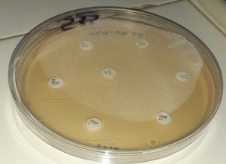
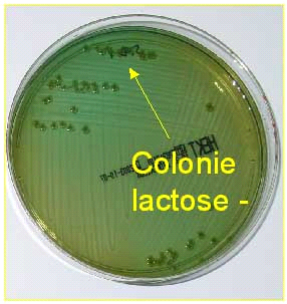
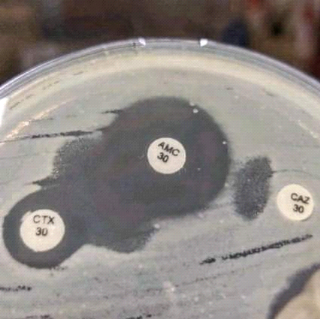

|
N°ED-STE |T|D|2|0|2|3|N|D|J|0|1| 0|6|
THÈSE DE DOCTORAT UNIQUE
Présenté par
Mahamat Tahir N'GARE HASSANMention : Biologie
Santé Humaine
Spécialité : Biotechnologies
Microbiennes et Cellulaires
Sur le thème :
Epidemiologie et caracterisation moleculaire de
Salmonella et Shigella, chez les patients
souffrants de diarrhéeaiguë à N'Djamena au
Tchad.
Soutenu le 14 Janvier 2025
Sous la direction de :
Pr ALI MAHAMAT MOUSSA
Professeur Titulaire, CAMESen Gastro/Enterol/Hepathologue
,Université de CAMES, Université de N'Djaména(Tchad);
Composition du jury :
Président : ABDELSALAMTidjani, Professeur Titulaire,
Nutrition et Technologie Alimentaire Université de N'Djamena (Tchad);
Rapporteur : DJOUM Richard, Professeur Titulaire de
Virologie et Biologie Moleculaire, Centre Pasteur de Yaoundé (
Cameroun) ;
Rapporteur : BESSIMBAYE Nadlaou,MC en Microbiologie,
Université de N'Djamena ( Tchad);
Examinateur : ABDERRAZZACK ADOUM FOUDA, MC en Microbiologie
et Immunologie , Université de N'Djamena ( Tchad);
Directeur de Thèse : ALI MAHAMAT MOUSSA, Professeur
Titulaire en Gastro Hepatho/Enterologie,Université de N'Djamena (
Tchad);
Années universitaires : 2019-202
DEDICACES
ü A mon épouse et mes enfants que ce travail vous
serve d'exemple ;
ü A ma mère, pour le soutien incontestable tout au
long de ma vie estudiantine,
ü Mon feu Père, N'gare Hassan ; Papa, là
où tu es actuellement trouve dans ce travail le résultat de tous
tes sacrifices et prières de même que l'expression de tout mon
amour à ton égard. J'aurais voulu que tu sois présent pour
partager ces moments. Que Dieu t'accepte dans son royaume céleste.
ü A mes soeurs et frères pour la place qu'ils
tiennent dans mon coeur ;
ü A tous les membres de ma famille, recevez à
travers ce document ma profonde considération
ü A mes bienfaiteurs, pour votre amour, votre chaleureux
soutien et votre enthousiasme à mon égard ;
ü A tous les patients qui ont participé à
cette étude ;
ü Trouvez ici l'expression de ma profonde
reconnaissance.
Remerciements
Ce travail a pu être
réalisé grâce au soutien des institutions et aux conseils
de nombreuses personnes ; qu'il nous soit permis de les
remercier :
Aux autorités de l'Université de N'Djamena en
particulier à la Presidence de l'Université de N'djamena, nous
exprimons toutes nos salutations et nos remerciements. Ce travail
réalisé est le fruit d'une collaboration internationale entre le
Laboratoire de Biochimie et ImmunuologieAppliqué(LABIA) à
l'Université Joseph Ki-Zerbo au Burkina Faso.
ü Au président de l'université de
N'Djamena, MAHAMAT SALEH DAOUSSA HAGGAR maitre de
conférences, spécilialitéMathématique, Enseignant
à la faculté des sciences exactes et appliqués, qui a
donné toute sa vie pour faire de cet institut un pôle africain de
référence en matière de recherches scientifique et
biomédicale. Merci pour m'avoir permis de poursuivre la
réalisation de mes rêves dans la vie scientifique et surtout
d'avoir approuvé mon stage de thèse au sein de cette illustre
institution de recherche dont vous dirigez. Que le bon Dieu vous accompagne
dans votre vie de chaque jour, qu'il vous comble de sa riche
bénédiction.
ü A notre Maître et Directeur de thèse
Pr Ali Mahamat Moussa, Professeur Titulairede
Gastro-EnteroHépatologie,enseignant à la faculté des
sciences et santé humaine.Cher Professeur, vous avez su à la fois
me laisser toute l'initiative et rester disponible pour me faire profiter de
l'entendu de votre savoir et la profondeur de vos idées pour mieux
orienter ce travail .Cher Maître, qu'il nous soit permis ici de vous
témoigner toute ma reconnaissance de m'avoir accepté comme
thésard. Vos qualités sont admirables. Votre amour pour le
travail bien fait, votre disponibilité et votre courtoisie nous ont
toujours impressionnés. Que le bon Dieu vous accorde sa riche
bénédiction et sa protection divine.
ü Pr Aly SAVADOGO, Professeur
Titulairede Biochimie-Microbiologie Je vous suis très reconnaissant et
exprime toute ma profonde gratitude, Merci pour toutes les remarques que vous
nous avez apportées pour l'amélioration du document. Recevez
toute ma reconnaissance et gratitude,
ü A la Direction du CHU de la Mère et de
l'Enfant de N'Djamena, pour m'avoir accepté dans son
institution pour ma recherche et réalisation de mes travaux,
ü M AHMAT MAHAMAT AHMAT, YACOUB MAHAMAT ALLAMINE,
AMINA KANIKA, ADOUM MAHAMAT OUMAR, AFFAF IDRISS et Dr OUMALKHER
YOUSSOUF, membre du groupe de recherches et d'avoir accepté de
nous suivre dans la réalisation de plusieurs de nos travaux de
recherches. Que Dieu vous bénisse.
ü A la Direction du Centre Hospitalier
Universitaire Mere et EnfantQu'il nous soit permis de remercier
très sincèrement les responsables du CHU ME qui nous ont permis
de faire la collecte dans leur institution. Merci à vous.
ü Aux Responsables des Hôpitaux des
Districts Qu'il nous soit permis de remercier très
sincèrement les responsables des Hôpitaux qui nous ont permis de
faire la collecte dans leur institution. Merci à vous.
ü Aux Techniciens de Laboratoire de
Recherche Diagnostic et expertises Scientifiques (LaboREDES).Qu'il
nous soit permis de vous remercier très sincèrement pour vos
conseils et votre bonne collaboration.
ü Aux Techniciens de Laoratoire du Centre
Hospitalier Universitaire Mere et Enfant (CHU ME)Qu'il nous soit
permis de vous remercier très sincèrement pour vos conseils et
votre bonne collaboration.
ü A mes Collaborateurs du Programme National de
Lutte Contre les Cancers Un grand Merci à vous. Vous avez
toujours été à mes côtés pour m'encourager et
prodiguer des conseils pour arriver à terme de cette thèse
Trouver en ce travail votre récompense,
ü DR CISSE HAMACher Dr et toute votre
équipe, retrouver ici l'expression de nos sincères remerciements.
Vous nous avez ouvert la porte de votre laboratoire en nous aidant à
réaliser la partie moléculaire de ce travail de thèse.
Merci infiniment pour votre bonne collaboration.
ü A LA COOPERATION FRANCAISE
Grace à vous, nous avons eu à
bénéficier d' une bourse de terrain qui nous à permis de
nous descendre sur le terrain et payer des reactifs, qu'il nous soit permis de
vous adresser toute notre reconnaissance.
Liste des sigles et
Abreviations
ADN : Acide
désoxyribonucléique
AVCI : Année de vie corrigée de
l'incapacité.
BCC : Bouillon Coeur Cervelle.
BLSE/ESBL : Bêta-Lactamases
à Spectre Élargi/ Estended-Spectrum-Beta- lactamases.
CA-SFM : Comité de
l'Antibiogramme de la Société Française de
Microbiologie.
BMR : Bactérie
Multi-résistante.
CDC : Center for Diseases Control and
prevention/Centre Américain pour le Contrôle
etla prévention des maladies.
CE/EC : Commission Européenne/
EuropeanCommision.
CIG : Céphalosporines de
première génération
G : Céphalosporines de
deuxième génération
C3G : céphalosporines de
troisième génération
C4G : céphalosporines de
quatrième génération
CTX-M :céfotaximases-Munich
CLSI : ClinicalLaboratory Standards
Institute/Institut de Normes de Laboratoire
Clinique.
CMI : Concentration Minimale
Inhibitrice.
CMB : Concentration Minimale
Bactéricide.
CNRVC-IPP : Centre National de Recherche
des Vibrions et de Choléra-Institut Pasteur de Paris.
CTX-M : Céfotaximase.
ECEH : Escherichia coli
entérohémorragique.
EFSA :Agence Europèenne de
la Sécurité Sanitaire.
ELISA :
Enzyme-linkedImmunoabsorbentAssays/Immunosorption enzymatique.
EPA/EPS : Eau Peptonée Alcaline/
Eau Peptonée Saline.
EMB : Éosine Bleu de
Méthylène.
FAO : Organisation des Nations Unies
pour l'Alimentation et l'Agriculture.
ICMSF : International Commission on
Microbiological Specifications for Foods
/ Commission Internationale sur les Spécifications
(caratéristiques)
Microbiologiques pour les Aliments.
INSEED : Institut National des
Statistiques et des Études Économiques et
Démographiques.
INSD : Institut National de la
Statistique et de la Démographie.
LPS:Lipolysaccharides.
MDR : Résistance à de
multiples antibiotiques, traduit de l'anglais « Multi-Drug
Resistance ».
MH : Mueller-Hinton.
NCCLS : National Committee for
ClinicalLaboratory Standards /Comité National pour les
normes de Laboratoire clinique.
OMP ou Omp : Outer Membrane
Protein /Protéine de la Membrane Externe.
OMS/WHO :Organistion Mondiale de la
Santé/ World HealthOrganization.
PCR : Polymérase Chaîne
Réaction/ Reaction Chain Polymerase.
PFGE : Pulsedfield gel
electrophoresis/Electrophorèse Gel d'agarose en champ pulsé.
PLP : Protéine Liant la
Pénicilline.
TCBS : Thiosulfate Bile Citrate
Saccharose.
TEM : Temoniera.
RPLA : Reverse Passive Latex
Agglutination/ Agglutination Inverse Passive du Latex.
SHV : Sulfhydrile Variable.
SSEI : Service de Surveillance
Épidémiologique Intégrée.
UFC : Unité Formant Colonie.
UI : Unité internationale.
UNICEF : United Nations International
Children's Emergency Fund/Fonds des Nations
Unies pour l'Enfance.
UV : Ultra-violets.
Liste des figure
Figure 1 : Salmonella au microscope
électronique........................................................15
Figure2: Shigella sonnei (cliché Wadsworth center,
2007)...............................................34
Figure3:Généralités sur les
entérobactéries.................................................................35
Figure 4 : modification morphologique d'une souche
Bactérienne............................................46
Figure 5: Schéma récapitulatif des
quatre..................................................................47
Figure 6 : Représentation schématique des cinq
familles de pompes d'efflux............................48
Figure7; : Centre Hospitalier Universitaire de la Mère et
de l'Enfant.............................................51
Figure8;Carte de la zone
d'étude..............................................................................52
Figure 9. Prélèvement des
selles.............................................................................54
Figure 10 : Ecouvillonnage
humide..........................................................................55
Figure11 : pré-enrichissement dans RV avant 24h et
après 24h.........................................56
Figure12:RV isolé sur gélose
Kektoen.....................................................................57
Figure 13: Hemoculture
Negative...........................................................................60
Figure 14: Hemoculture
Positive............................................................................60
Figure 15: Salmonella typhi sur Hektoene colonies vertes au
centre noir...............................70
Figure 16 : Shigella sur Hektoene colonies vertes
transparents..........................................71
Figure17: identification sur galerie API 20 E Salmonella typhi
differenciation biochimique.......71
Figure18:identification sur galerie API 20 E Shigella flexneri
différenciation biochimique.........71
Figure 19 : Répartition mensuelle des cas de
diarrhées et agents bactériens
isolé....................72
Figure20:Distribution des germes isolé dans les
hôpitaux de districts et CHU ME...................73
Figure 21 : Migration des réplicons de
salmonella........................................................80
Figure 22: Dendrogramme basé sur des empreintes de
(GTG)5-PCR sur les souches cliniques de Salmonellaselon l'algorithme
de l'UPGMA...............................................................81
.
Liste des tableaux
TableauI:Mode de transmission de certaines infections
bactériennes.................. ;..............11
Tableau II:Taxonomie de Salmonelle
......................................................................17
TableauIII:Pouvoir Pathogène des Salmonella
isolé chez l'homme et les animaux..................18
Tableau IV : Description des principales
épidémies d'origine alimentaire dues à
Salmonella....................................................................................................................24
Tableau V : Distribution des cas confirmés de
salmonelloses par serovars chez les humains, 2008-2009 (EFSA Journal,
2011....................................................................................25
Tableau VI : Répartition des 15 sérotypes de
Salmonella humains les plus fréquents isolés de quelques pays
africains en nombre et en pourcentage ((Hendriksen et al.,
2011))....................26
TableauVII:Sérotypes de Salmonella isolés
à N'Djamena au Tchad ..................................27
TableauVIII :caractères biochimiques
différentiels des entérobactéries
pathogènes.................57
TableauIX :Disques des antibiotiques choisis pour les
tests de la sensibilité...........................61
TableauX : Répartition des patients selon
l'âge et la provenance.........................................69
TableauXI :Aspects et consistance des selles
selon l'âge.................................................70
Tableau
XII : Répartition des agents bactériens selon le
sexe............................................73
Tableau
XIII :Analyse de l'efficacité des 14 antibiotiques face aux agents
bactériens isolés......76
RESUME
Introduction
Dans les pays en voie de développement, les maladies
infectieuses d'origine alimentaire, principalement attribuables aux genres
Salmonella et Shigella, représentent un problème de
santé majeur. Les Salmonella et Shigella, sont des
espèces bactériennes les plus courantes impliquées dans
divers types d'infections, y compris la septicémie et la
gastro-entérite. Ceux-ci impliquent plusieurs clones bactériens
présentant une résistance aux multimédicaments, ce qui les
rend difficiles à traiter. L'objectif de notre étude était
détecter les espèces de Salmonella et Shigella dans les
échantillons pathologiques de selles et du sang, afin d'évaluer
leur prévalence en relation avec les facteurs de risque, de
caractériser leur profil de résistance face aux antibiotiques, et
de reconstruire leur arbre phylogénétique pour comprendre leur
origine.
Materiel et Methodes
Les échantillons ont été
prélevés auprès de patients hospitalisés et de
patients externes dans quatre hôpitaux de district à savoir :
hopital de distrisctEst ,Hopital de District Centre , Hopital de
district Sud, Hopital de district Nord ainsi qu'au Centre Hospitalier de la
Mère et de l'Enfant, sur une période s'étendant de juin
2021 à décembre 2023. Les selles des patients du CHU ME ont
été prélevées dans des flacons stériles,
tandis que des écouvillons ont été utilisés pour
les patients des hôpitaux de district de N'djamena. De plus, le sang des
patients présentant une fièvre supérieure à 38
degrés Celsius a été utilisée pour
l'hémoculture. Le test de sensibilité antimicrobienne a
été réalisé à l'aide de la méthode
CA-SFM /EUCAST et les souches ont été identifiées par des
tests microbiologiques conventionnels.
L'ADN bactérien a été extrait par
méthode d'ébullition. (GTG) -PCR a été
utilisé pour le sous-typage de la souche. Le logiciel Dendro- UPGMA a
été utilisé pour regrouper les souches à partir des
empreintes génétiques obtenues par (GTG) -PCR.
Résultats et discussions
Un total de 1350 patients a été
enregistré dans quatre hôpitaux de district ainsi qu'au Centre
Hospitalier Universitaire de la Mère et de l'Enfant pour des cas de
gastro-entérites aiguës.
cinquante(50) souches ont été isolées,
dont trente (30)Shigella et vingt (20) Salmonella. Nous
avons observé une différence significative dans l'incidence des
infections bactériennes chez les enfants de 0 à 5 ans et les
adultes de plus de 21 ans par rapport aux autres groupes (p = 0,01).
Les profils de sensibilité aux antibiotiques des
souches Salmonella et Shigella étaient
diversifiés : Salmonellaenterica et Shigellabongori. Nous
avons constaté que 82,3 % des bactéries étaient
résistantes aux antibiotiques de la famille des bêta-lactamines,
notamment l'ampicilline, l'amoxicilline et l'amoxicilline + acide clavulanique,
ainsi que la céftriaxone. La majorité des souches étaient
sensibles à la gamme d'antibiotiques testée, notamment la
quinolone (acide nalidixique, ofloxacine et ciprofloxacine), à
l'exception de certains antibiotiques de la famille des bêtalactamases,
qui ont montré une sensibilité réduite à
l'ampicilline et à l'amoxicilline + acide clavulanique. Par ailleurs, pour évaluer les relations
phylogénétiques et établir des liens
épidémiologiques entre les souches de Salmonella
isolées au cours de notre étude, nous avons
caractérisé vingt isolats bactériens de
Salmonella par PCR (Polymérase Chain Reaction) GTG5, puis
regroupé les souches en utilisant le logiciel DendroUPGMA sur la base
des empreintes génétiques obtenues par PCR GTG5.
Le den- drogramme obtenu à l'aide de l'empreinte
génétique a permis de regrouper les souches de
Salmonella en 20 groupes (G1 à G20).
Conclusion
Cette étude souligne l'ampleur du problème de
santé publique posé par ces bactéries chez les populations
tchadiennes. Elle met en évidence la nécessité de
surveiller de près le profil antibiotique afin d'assurer une
antibiothérapie efficace et de mettre en place des programmes de
prévention adaptés à la santé publique. La
circulation de telles souches nécessite des études plus
poussées pour mieux connaitre l'origine et leur mode
dissémination.
Le test Rep-PCR (GTG) a permis un typage moléculaire
rapide des souches de Salmonella. Les souches des Salmonella
typées dans cette étude appartiendraient à
différents clones.
Mots clés : Diarrhée
aigüe, Identification, Antibiotiques, épidémiologie,
N'Djamena.
ABSTRACT
Introduction
In developing countries, foodborne infectious diseases, mainly
attributable to the genera Salmonella and Shigella, represent a major
health problem. Salmonella and Shigella are the most common bacterial
species implicated in various types of infection, including septicaemia and
gastroenteritis. These involve several bacterial clones with multi-drug
resistance, making them difficult to treat. The aim of our study was to detect
Salmonella and Shigella species in pathological stool and blood
samples, to assess their prevalence in relation to risk factors, to
characterise their antibiotic resistance profile, and to reconstruct their
phylogenetic tree to understand their origin.
Materials and methods
Samples were collected from inpatients and outpatients in four
district hospitals and the Centre HospitalierMère et Enfant, over a
period extending from June 2021 to December 2023. Stools from patients at the
CHU ME were collected in sterile vials, while swabs were used for patients at
district hospitals in N'djamena. In addition, blood from patients with a fever
above 38 degrees Celsius was used for blood cultures. Antimicrobial
susceptibility testing was performed using the CA-SFM /EUCAST method and
strains were identified by conventional microbiological tests.
Bacterial DNA was extracted using the boiling method.
(GTG)-PCR was used for strain subtyping. The Dendro- UPGMA software was used to
group strains on the basis of the genetic fingerprints obtained by (GTG)
-PCR.
Results and discussion
Between 1 January 2022 and 30 June 2023, a total of 1370
patients were registered at four district hospitals and the Centre
HospitalierUniversitaireMère et Enfant for cases of acute
gastroenteritis.
A total of fifty strains were isolated, including thirty
Shigella and twenty Salmonella. We observed a significant
difference in the incidence of bacterial infections in children aged 0-5 years
and adults aged over 21 years compared with the other groups (p = 0.01).
The antibiotic susceptibility profiles of Salmonella and
Shigella strains were diverse. We found that 82.3% of the bacteria were
resistant to beta-lactam antibiotics, including ampicillin, amoxicillin and
amoxicillin + clavulanic acid, as well as ceftriaxone. The majority of strains
were sensitive to the range of antibiotics tested, particularly the quinolones
(nalidixic acid, ofloxacin and ciprofloxacin), with the exception of certain
beta-lactamase antibiotics, which showed reduced sensitivity to ampicillin and
amoxicillin + clavulanic acid. In order to assess phylogenetic relationships
and establish epidemiological links between the Salmonella strains
isolated during our study, we characterised twenty Salmonella isolates
by GTG5 PCR (Polymerase Chain Reaction), then grouped the strains using
DendroUPGMA software on the basis of the genetic fingerprints obtained by GTG5
PCR.
The den- drogram obtained using genetic fingerprinting was
used to group Salmonella strains into 20 groups (G1 to G20).
Conclusion
This study highlights the scale of the public health problem
posed by these bacteria in Chadian populations. It highlights the need for
close monitoring of the antibiotic profile in order to ensure effective
antibiotic therapy and the implementation of prevention programmes tailored to
public health. The circulation of such strains requires further study to gain a
better understanding of their origin and mode of dissemination.
The 5-PCR test (GTG) has enabled rapid molecular typing of
Salmonella strains. The Salmonella strains typed in this
study belong to different clones.
Keywords: Acute diarrhoea, Identification,
Antibiotics, prevalence, epidemiology, N'djamena.
ãáÎÕ
ãÞÏãÉ
íÇáÈáÏÇäÇáäÇãíÉÊãËáÇáãÑÇÖÇáãÚÏíÉÇáãäÞæáÉÈÇáÛÐÇÁæÇáÊíÊÚÒìÈÔßáÑÆíÓíÅáìÌäÇÓÇáÓÇáãæäíáÇæÇáÔíÛíáÇãÔßáÉÕÍíÉßÈíÑÉ.
ÊÚÏÇáÓÇáãæäíáÇæÇáÔíÛíáÇãäßËÑÇáäæÇÚÇáÈßÊíÑíÉÔíæÚðÇæÇáÊíÊÓÈÈäæÇÚðÇãÎÊáÉãäÇáÚÏæìÈãÇíÐáßÇáÅäÊÇäæÇáÊåÇÈÇáãÚÏÉæÇáãÚÇÁ.
æÊÔãáåÐåÇáÍíæÇäÇÊÇáãÓÊäÓÎÉÇáÈßÊíÑíÉÇáãÊÚÏÏÉÇáãÞÇæãÉááÏæíÉÇáãÊÚÏÏÉããÇíÌÚáÚáÇÌåÇÕÚÈðÇ.
ßÇäÇáåÏãäÏÑÇÓÊäÇåæÇáßÔÚääæÇÚÇáÓÇáãæäíáÇæÇáÔíÛíáÇíÚíäÇÊÇáÈÑÇÒæÇáÏãÇáãÑÖíÉãäÌáÊÞííããÏìÇäÊÔÇÑåÇíãÇíÊÚáÞÈÚæÇãáÇáÎØÑæÊæÕíãáãÞÇæãÊåÇááãÖÇÏÇÊÇáÍíæíÉæÅÚÇÏÉÈäÇÁÔÌÑÉÇáäÔæÁæÇáÊØæÑÇáÎÇÕÉÈåÇáåãÕáåÇ.
ÇáãæÇÏæÇáÓÇáíÈ
ÊãÌãÚÇáÚíäÇÊãäÇáãÑÖìÇáãäæãíäæÇáãÑÖìÇáÎÇÑÌííäíÑÈÚÉãÓÊÔíÇÊÈÇáãäÇØÞæåí:ãÓÊÔìÇáãäØÞÉÇáÔÑÞíÉãÓÊÔìÇáãäØÞÉÇáãÑßÒíÉãÓÊÔìÇáãäØÞÉÇáÌäæÈíÉãÓÊÔìÇáãäØÞÉÇáÔãÇáíÉÈÇáÅÖÇÉÅáìãÑßÒãÓÊÔìÇáãæãÉæÇáØÇáæÐáßÎáÇáÊÑÉÊãÊÏãäíæäíæ
2021 ÅáìÏíÓãÈÑ
2023.
ÊãÌãÚÈÑÇÒÇáãÑÖìíãÓÊÔì
CHU ME
íÒÌÇÌÇÊãÚÞãÉíÍíäÊãÇÓÊÎÏÇãÇáãÓÍÇÊááãÑÖìãÓÊÔíÇÊÇáãäØÞÉíäÌÇãíäÇ.
ÈÇáÅÖÇÉÅáìÐáßÊãÇÓÊÎÏÇãÇáÏããäÇáãÑÖìÇáÐíäíÚÇäæäãäÍãìÚáìãä
38
ÏÑÌÉãÆæíÉíÒÑÇÚÉÇáÏã.
ÊãÅÌÑÇÁÇÎÊÈÇÑÇáÍÓÇÓíÉáãÖÇÏÇÊÇáãíßÑæÈÇÊÈÇÓÊÎÏÇãØÑíÞÉ
CA-SFM/EUCAST
æÊãÊÍÏíÏÇáÓáÇáÇÊÚäØÑíÞÇáÇÎÊÈÇÑÇÊÇáãíßÑæÈíæáæÌíÉÇáÊÞáíÏíÉ.
ÊãÇÓÊÎÑÇÌÇáÍãÖÇáäææíÇáÈßÊíÑíÈØÑíÞÉÇáÛáíÇä.
ÊãÇÓÊÎÏÇã (GTG) -PCR
ááÊÕäíÇáÑÚíááÓáÇáÉ.
ÊãÇÓÊÎÏÇãÈÑäÇãÌ
Dendro-UPGMA
áÊÌãíÚÇáÓáÇáÇÊÈäÇÁðÚáìÇáÈÕãÇÊÇáÌíäíÉÇáÊíÊãÇáÍÕæáÚáíåÇÈæÇÓØÉ
(GTG)-PCR.
ÇáäÊÇÆÌæÇáãäÇÞÔÇÊ
æÊãÊÓÌíáãÇãÌãæÚå
1350
ãÑíÖÇðíÑÈÚãÓÊÔíÇÊÈÇáãäÇØÞæßÐáßíãÑßÒãÓÊÔìÇáãæÇáØáÇáÌÇãÚíáÍÇáÇÊÇáÊåÇÈÇáãÚÏÉæÇáãÚÇÁÇáÍÇÏ.
ÊãÚÒáÎãÓíä
(50)
ÓáÇáÉãäåÇËáÇËæä
(30)
ÔíÌáÇæÚÔÑíä
(20) ÓÇáãæäíáÇ.
áÇÍÙäÇæÌæÏÇÎÊáÇßÈíÑíÍÏæËÇáÇáÊåÇÈÇÊÇáÈßÊíÑíÉáÏìÇáØÇáÇáÐíäÊÊÑÇæÍÚãÇÑåãÈíä
0-5
ÓäæÇÊæÇáÈÇáÛíäÇáÐíäÊÒíÏÚãÇÑåãÚä
21
ÚÇãðÇãÞÇÑäÉÈÇáãÌãæÚÇÊÇáÎÑì
(Ú = 0.01).
ßÇäÊãáÇãÍÇáÍÓÇÓíÉááãÖÇÏÇÊÇáÍíæíÉáÓáÇáÇÊÇáÓÇáãæäíáÇæÇáÔíÌíáÇãÊäæÚÉ:ÇáÓÇáãæäíáÇÇáãÚæíÉæÇáÔíÌíáÇÈæäÌæÑí.
ææÌÏäÇä 82.3%
ãäÇáÈßÊíÑíÇßÇäÊãÞÇæãÉááãÖÇÏÇÊÇáÍíæíÉÈíÊÇáÇßÊÇãÈãÇíÐáßÇáãÈíÓáíäæÇáãæßÓíÓíáíäæÇáãæßÓíÓíáíä
+
ÍãÖÇáßáÇæáÇäíßæßÐáßÇáÓíÊÑíÇßÓæä.
ßÇäÊÛÇáÈíÉÇáÓáÇáÇÊÍÓÇÓÉáãÌãæÚÉãäÇáãÖÇÏÇÊÇáÍíæíÉÇáÊíÊãÇÎÊÈÇÑåÇÈãÇíÐáßÇáßíäæáæä
(ÍãÖÇáäÇáíÏíßÓíßæÇáæáæßÓÇÓíäæÇáÓíÈÑæáæßÓÇÓíä)ÈÇÓÊËäÇÁÈÚÖÇáãÖÇÏÇÊÇáÍíæíÉÈíÊÇáÇßÊÇãÇÒÇáÊíÙåÑÊÇäÎÇÖÇáÍÓÇÓíÉááãÈíÓíáíäæãÚãæßÓíÓíáíä
+
ÍãÖÇáßáÇæáÇäíß.
ÚáÇæÉÚáìÐáßáÊÞííãÇáÚáÇÞÇÊÇáÊØæÑíÉæÅÞÇãÉÑæÇÈØæÈÇÆíÉÈíäÓáÇáÇÊÇáÓÇáãæäíáÇÇáãÚÒæáÉÎáÇáÏÑÇÓÊäÇÞãäÇÈÊãííÒÚÔÑíäÚÒáÉÈßÊíÑíÉãäÇáÓÇáãæäíáÇÈæÇÓØÉ
PCR
(ÊÇÚáÇáÈæáíãíÑÇÒÇáãÊÓáÓá)
GTG5ËãÞãäÇÈÊÌãíÚÇáÓáÇáÇÊÈÇÓÊÎÏÇãÈÑäÇãÌDendroUPGMAÈäÇÁðÚáìÇáÈÕãÇÊÇáÌíäíÉÇáÊíÊãÇáÍÕæáÚáíåÇÈæÇÓØÉ
GTG5 PCR.
æÞÏÊÇÍãÎØØÇáÔÌÇÑÇáÐíÊãÇáÍÕæáÚáíåÈÇÓÊÎÏÇãÇáÈÕãÇÊÇáÌíäíÉÊÌãíÚÓáÇáÇÊÇáÓÇáãæäíáÇí
20 ãÌãæÚÉ (ãä G1
Åáì G20).
ÎÇÊãÉ
ÊÓáØåÐåÇáÏÑÇÓÉÇáÖæÁÚáìãÏìãÔßáÉÇáÕÍÉÇáÚÇãÉÇáÊíÊÔßáåÇåÐåÇáÈßÊíÑíÇÈíäÇáÓßÇäÇáÊÔÇÏííä.
æíÓáØÇáÖæÁÚáìÇáÍÇÌÉÅáìãÑÇÞÈÉãáÇáãÖÇÏÇÊÇáÍíæíÉÚäßËÈãäÌáÖãÇäÇáÚáÇÌÇáÚÇáÈÇáãÖÇÏÇÊÇáÍíæíÉæÊäíÐÈÑÇãÌÇáæÞÇíÉÇáÊíÊÊßíãÚÇáÕÍÉÇáÚÇãÉ.
íÊØáÈÊÏÇæáãËáåÐåÇáÓáÇáÇÊÇáãÒíÏãäÇáÏÑÇÓÇÊÇáãÊÚãÞÉáåãÇáÕáæØÑíÞÉÇäÊÔÇÑåÇÈÔßáÖá.
ÓãÍÇÎÊÈÇÑ
Rep-PCR (GTG)
ÈÇáßÊÇÈÉÇáÌÒíÆíÉÇáÓÑíÚÉáÓáÇáÇÊÇáÓÇáãæäíáÇ.
ÊäÊãíÓáÇáÇÊÇáÓÇáãæäíáÇÇáãßÊæÈÉíåÐåÇáÏÑÇÓÉÅáìäÓÎãÎÊáÉ.
ÇáßáãÇÊÇáãÊÇÍíÉ:ÇáÅÓåÇáÇáÍÇÏÊÍÏíÏÇáåæíÉÇáãÖÇÏÇÊÇáÍíæíÉÚáãÇáæÈÆÉäÌÇãíäÇ.
Table des Matières
DEDICACES
i
Remerciements
ii
Liste des sigles et Abreviations
iv
Liste des figure
vi
Liste des tableaux
vii
RESUME
viii
ABSTRACT
x
INTRODUCTION GENERALE
1
Chapitre .1. Généralités sur les
Salmonellaet Shigella
5
1.1 Définition de la diarrhée
5
1.2 Ampleur des diarrhées
5
1. 2.1. Dans le monde
5
1.2.2. En Afrique
6
1.3. Epidémiologie des diarrhées
infantiles
7
? 1.3.1. Les bactéries : Salmonella et
Shigella
7
1.3.2 facteurs environnementaux favorisant les
infections diarrhéiques
7
1.3.2 Lutte contre les maladies diarrhéiques
8
2. Genre Salmonella
10
2.1 Définition
10
2.2 Historique
10
2.3.Caractéristiques morphologiques des
salmonelles
11
2.4Taxonomie et nomenclature
12
2.6 Caractères biochimiques
13
2.7 Pouvoir pathogène des Salmonelles
14
2.8 Caractéristiques antigéniques :
14
2.9 génome de Salmonella
15
2. 10 Mécanismes de virulence
16
2.11. pouvoir pathogène des
Salmonelles
17
2.11.1 gastro-entérites
17
2.11.2 infections systémiques ou fièvre
typhoïde
17
2.11.3. Toxi-infections alimentaires collectives
18
2.12. Cycle infectieux de Salmonelle
18
3. Genre Shigella
21
3.1 Caractères morphologiques
23
3.2 Caractères culturaux et biochimiques
24
3.4 Epidémiologie
27
3.5 Pouvoir Pathogène
28
3.5.5 Bases du Traitement
30
3.6 Shigella Vaccin
30
Chapitre .2 Antibiotiques
32
2.1. Définition
32
2.2 Resistance Bactérienne
32
2.2.1. Définition
33
2.2.2 Résistance naturelle
33
2.2.3 Résistance acquise
33
2.2.4 Causes des résistances acquises
34
2.2.5 résistance croisée
34
2.2.6 Mécanismes biochimiques de la
résistance
34
? Diminution de la perméabilité de la
membrane à l'antibiotique
36
? modification de cibles
36
? Excrétion par des systèmes d'efflux
37
2.2.7 Salmonella et résistance aux
antimicrobiens
38
Chapitre 3 Techniques moléculaires
deSalmonellaet
Shigella...........................................40
2eme Partie MATERIEL ET METHODE
47
1.2. Type et période d'étude
48
1.4 Échantillonnage
49
1.3 .1 Enquêtes
49
1.3.2 Procédure de collecte des données
51
1.3.3 Critère d'inclusion
52
1.4 Analyses microbiologiques et moléculaires
52
1.4.1 Enregistrement des selles
53
1.4.2 Examen macroscopique
53
1.4.3. Examen microscopique
53
2.5 Analyses microbiologiques
53
1.5.1 Méthodes Manuelles de Coproculture
54
1.5.3. Préparation
des échantillons des selles
54
1.5.4. Enrichissement
54
1.5. Isolement
54
3.4. Identification des agents bactériens
55
1.5. Méthodes Manuelles par
l'hémoculture
58
1.6. Analyses sérologiques
60
Chapitre 2. Profil de résistance aux
antibiotiques des Salmonella et Shigella isolés
62
2.1 Méthode de diffusion en milieu
gélosé
62
2.2 Les disques d'antibiotiques
62
2.3 Conservation des souches isolées
63
2.4 Caractérisation moléculaire de
Salmonella
63
2.4.1 Extraction de l'ADN bactérien
64
2.4.2. Préparation du mélange
réactionnel
64
2.4.3. Amplification des extraits d'ADN
64
2.4.4. Préparation du gel d'agarose
65
2.4.5. Electrophorèse de produit PCR
65
2.4.6. Traitement du gel
65
2.4.7. Construction de l'arbre
phylogénétique
65
2.4.8 Contrôle des milieux
65
2.4.9 Traitement des données.
66
1.4.10 Considération éthique et
administratives
66
3eme PARTIE : RESULTATS
68
Chapitre .1 . Nombre et origine des
échantillons biologiques collectés et analysés
69
3.2 Origine géographique des
échantillons
69
3.2.2 Répartition des échantillons en
fonction de la nature de produit pathologique et des sites
70
3.3 Identification des sérotypes des agents
bactériens isolés
71
3.4.3 Répartition mensuelle des cas de
diarrhées et agents bactériens
73
3.4.4 Types et nombre des sérotypes
identifiés
74
3.4.5 Facteurs de risque associés à
l'infection par les sérotypes des agents bactériens isolés
74
3.4.6 Différentes espèces de
Salmonella et Shigella et leurs facteurs de risques d'infection
à Ndjamena
75
Chapitre 2. Profil de résistance aux
antibiotiques des Salmonella et Shigella isolés
77
2.1 Analyse de l'efficacité des antibiotiques
face aux agents bactériens isolés
77
Chapitre 3. Caractérisation moléculaire
des agents bactériens identifiés
82
3.1 Caractérisation moléculaire des
souches de salmonella isolées par la Technique (GTG) -PCR
82
3.1 Comparaison des profils de l'arbre
phylogénétique
83
4eme Partie : DISCUSSION
85
4 . DISCUSSION GENERALE
86
4.1 Nombre et origine des échantillons
biologiques collectés et analysés
86
4.2 Profil de résistance aux antibiotiques des
Salmonella et Shigella isolés
90
4.3 Caractérisation moléculaire des
agents bactériens identifiés
92
CONCLUSION ET PERSPECTIVES
94
PERSPECTIVES
95
ANNEXE
1
Liste des articles et communication
1
INTRODUCTION GENERALE
La gastro-entérite est une affection au niveau de
l'estomac et des intestins, souvent provoquée par des agents
pathogènes tels que les bactéries, les virus ou les parasites
(McQuade et al., 2020). Dans les pays en développement, les
diarrhées aiguës infectieuses sont à l'origine d'environ un
tiers des décès dus à la déshydratation (Canada,
2017). Elles restent fréquentes dans nos régions, comme en
témoigne la fréquence des toxi-infections alimentaires familiales
ou des collectivités (crèches, etc.) (Mariani-Kurkdjian et al.,
2016). La diarrhée aiguë est définie par l'émission
d'au moins trois selles liquides et/ou molles par jour depuis moins de 14 jours
(Mariani-KurkdJIAN et al., 2016). Les Salmonella et Shigella, deux
espèces de bactéries pathogènes, sont souvent liées
aux épidémies de gastro-entérite à travers le monde
(Rogawski, McQuade et al., 2020). Les infections à parasites
intestinaux, à Salmonella et à Shigella sont
les principaux problèmes de santé publique dans le monde, en
particulier dans les pays en développement, en raison de
l'inaccessibilité de l'eau salubre et des pratiques de manipulation
d'aliments non hygiéniques des préposés à la
manutention des aliments (Mama et al., 2016). Ces micro-organismes peuvent
entraîner des infections graves, voire mortelles, surtout chez les
populations vulnérables telles que les jeunes enfants, les personnes
âgées et les individus immunodéficients (Vu, 2020). Les
enfants de moins de cinq ans sont les plus exposés et environ 125 000
meurent chaque année (Organisation mondiale de la Santé, 2018). .
En effet, on estime à plus de 91 millions le nombre de cas et à
137 000 celui des décès par an (Organisation mondiale de la
Santé, 2018).
L'épidémiologie des infections à
Salmonella et Shigella est complexe, impliquant divers facteurs tels
que la contamination alimentaire, l'eau contaminée et le contact
interhumain. Parmi les contraintes sanitaires de l'eau, figurent les
bactéries qui sont en général ubiquistes et causent des
maladies dites hydriques telles que la diarrhée, la fièvre
typhoïde, le choléra (Yesigat et al., 2020). Les eaux de forage
sont souvent exposées à de nombreuses contaminations, elles
peuvent donc présenter un risque pour la santé des consommateurs
(Sawadogo et al., 2023).Comprendre la dynamique de transmission de ces agents
pathogènes est crucial pour mettre en oeuvre des stratégies de
prévention et de contrôle efficaces. La gravité des
infections aux agents bactériens, associées aux
conséquences économiques et en santé publique, a
entraîné le développement de nombreuses méthodes
phénotypiques, puis plus récemment, moléculaires pour la
caractérisation des Salmonelles et Shigelles (Grattard
et Pozzetto, 1999). Cette caractérisation s'appuie en premier lieu sur
la détermination du sérotype, méthode très
couramment employée, permettant de suivre les tendances
évolutives dans différentes filières en vue de
l'épidémiosurveillance des Salmonelles et Shigelles
(Laurent &Moez, 2023). Au Danemark, les coûts économiques
liés aux salmonelloses sont estimés entre 10,4 et 25,5 millions
de dollars US en 200 (René et al., 2011).
A ce problème majeur, s'incarnait au cours de ces
dernières décennies, le phénomène de
résistance aux antibiotiques est devenu assez fréquent dans le
genre Salmonella et Shigella (Li et al., 2024). En effet, plusieurs
études ont montré que les Escherichia
colientéropathogènes, Salmonella enterica, Shigella spp,
Yersinia, Campylobacter et Vibrio cholerae sont de plus en plus
résistants aux â-lactamines (ZEBA et al., 2007, HAUKKA,2007). On
assiste également à l'apparition de phénomènes de
résistance inexpliqués (forte prévalence de
bactéries productrices de BLSE chez des enfants dont l'âge
était compris entre 0-12 mois à l'origine de l'impasse
thérapeutique (Dembélé et al., 2015) Au Tchad, les
premières études sur Salmonella datent des travaux de
Perpezat et al., (1964), de Le Minor et al., (1969) et de Guard et al., (1973)
et ont permis de démontrer l'importance épidémiologique
des salmonelloses humaines et animales, ainsi que la diversité des
sérotypes rencontrés.
Au Tchad, la situation sanitaire demeure très
précaire, imputable au contexte socio-économique et au
fonctionnement du système de santé (INSEED, 2014) ;(MSPP,
2022).
Les maladies diarrhéiques demeurent l'une des
principales causes de mortalité et de morbidité chez les enfants
de moins de 5 ans (BESSIMBAYE et al., 2013). De ce fait, elles constituent un
problème majeur de santé publique (MSPP, 2022). L'utilisation
sélective des antibiotiques a touché environ 19 000 personnes
dont 15 900 enfants de moins de 5 ans, chaque année, atteints de
diarrhée (BESSIMBAYE et al., 2013).
Les hôpitaux tchadiens à l'instar des
hôpitaux africains ne sont pas du tout épargnés par les
phénomènes des infections croisés (Bessimbayeet al., 2021)
; (Hassan et al ;2021) ; (Ouchar al., 2019).
Le Tchad ne dispose d'aucun mécanisme de
régulation et de contrôle de l'utilisation des antibiotiques tant
dans le domaine vétérinaire qu'en santé humaine (Tabo,
2013). Les antibiotiques de toutes catégories se vendent à tous
les coins des rues des grandes villes du Tchad, sans aucun contrôle et
dans des très mauvaises conditions de conservation (Tabo,2013).
La caractérisation moléculaire des souches de
Salmonella et Shigella revêt une importance
particulière pour plusieurs raisons. Elle permet de mieux comprendre la
diversité génétique au sein de ces espèces,
d'identifier les souches émergentes, et de tracer l'origine des
épidémies. De plus, la caractérisation moléculaire
peut aider à évaluer la résistance aux antimicrobiens, ce
qui est essentiel pour orienter les choix thérapeutiques et mettre en
place des mesures de lutte contre la résistance aux médicaments.
Ces techniques, en général plus longues et fastidieuses à
mettre en oeuvre, sont plutôt réservées aux enquêtes
épidémiologiques dans un écosystème donné ou
lors d'investigation suite à une toxi-infection alimentaire ou à
une épidémie de salmonellose et de shigellose
(Ung et al. , 2019).
L'étude pourrait donc se concentrer sur la collecte de
données épidémiologiques à partir de cas de
gastroentérite provoquée par Salmonella et Shigella , en
utilisant des méthodes de surveillance sur le terrain. En
parallèle, elle pourrait mettre en oeuvre des techniques de biologie
moléculaire pour caractériser les souches isolées, en
analysant leur génome, en identifiant les gènes de virulence, en
évaluant leurs sensibilités aux antibiotiques et en
étudiant la diversité au sein des micro-organismes pour l'
obtention de l'empreinte génétique entre les différentes
souches étudiées.
Très peu d'études ont été
menées sur ces deux (2) germes ( Salmonella et Shigella ) au
Tchad,, en dehors de la contribution de Tabo et al., (2013) sur l'état
de l'antibiorésistance des souches de Salmonella chez les
humains et les poules pondeuses dans la ville de N'Djamena.
Les résultats de cette recherche contribueraient
à améliorer la compréhension de
l'épidémiologie de la gastro-entérite liée à
Salmonella et Shigella, tout en fournissant des informations
précieuses pour la prévention, la surveillance et le
contrôle de ces infections.
OBJECTIF
Objectif général
Contribuer à une meilleure prise en charge des garstro
entértes causées par les souches de Salmonella et
Shifellaau Tchad.
En Objectif Spécifique ; il s'agit
de :
· Determiner la prevalence des Salmonella et
Shigellaimpliqué dans les gastroenterite
· Déterminer le profil de resistance aux
antibiotiques des Salmonella et Shigella isolés,
· Rassembler les facteurs de risques associés
à la transmission,
· Effectuer la caractérisation moléculaire
des agents bactériens Salmonella et Shigella.
1erePARTIE
REVUE DE LA LITTERATURE

Chapitre.1.
Généralités sur lesSalmonellaet Shigella
1. Géneralité sur les
diarrhées
1.1 Définition de la
diarrhée
Une diarrhée est la survenue de plus de trois
émissions fécales, molles ou liquides, par jour. Ces
émissions peuvent être soit glaireuses et plus ou moins
sanglantes, soit se présenter sous forme de diarrhée (OMS, 2000).
Les épisodes de diarrhée d'une durée inférieure
à 14jours sont définis comme des diarrhées aigües
(ABBA et al., 2009). Les épisodes de diarrhée d'une durée
supérieure à 14jours sont définis comme des
diarrhées persistantes (ABBA et al., 2009).
1.2Ampleur des
diarrhées
1. 2.1. Dans le monde
Ces vingt dernières années, les problèmes
de santé publique et d'ordre économique associés aux
maladies d'origine alimentaire ont pris une ampleur croissante dans un certain
nombre de pays. Les flambées de maladies provoquées
fréquemment par de nouveaux agents pathogènes, l'administration
d'antibiotiques au bétail et le transfert de la résistance aux
antibiotiques à l'homme, ainsi que les inquiétudes
suscitées actuellement par l'encéphalite spongiforme bovine n'en
sont que quelques exemples. Les pays munis de systèmes de surveillance
ont enregistré une augmentation notable de l'incidence (nombre de cas)
des maladies alimentaires au cours de ces deux dernières
décennies. La signification de cette augmentation sera discutée
ultérieurement. Les estimations annuelles sont de l'ordre de 76 millions
de cas de maladies transmises par les aliments, auxquels sont associés
325 000 hospitalisations et 5 000 décès pour les Etats-Unis et de
2 366 000 cas, 21 138 hospitalisations et 718 décès en Angleterre
et au Pays de Galles (MEAD et al., 1999). Le nombre de cas rapportés
laisse supposer que la charge de morbidité des maladies d'origine
alimentaire est probablement du même ordre de grandeur dans la plupart
des pays de l'OCDE. Les maladies d'origine alimentaire constituent un vaste
groupe de pathologies. Parmi celles-ci, les gastro-entérites,
provoquées par tout un ensemble de micro-organismes, bactéries,
virus et parasites, sont le syndrome clinique le plus fréquent.
Généralement brève, la période d'incubation dure
1-2 à 7 jours. Cette pathologie, qui varie en gravité du simple
trouble ne nécessitant pas de traitement médical à
l'affection sévère conduisant à une hospitalisation, peut
entraîner une incapacité à long terme, voire le
décès (la fréquence des hospitalisations
s'échelonne entre 0,6 et 29 % et la mortalité atteint 2,5 % aux
États-Unis) (MEAD et al., 1999).
Les conséquences de l'exposition par voie alimentaire
à des agents pathogènes provoquant des diarrhées
dépendent de plusieurs facteurs relevant de l'hôte, notamment son
état immunitaire sous-jacent, sa capacité à
générer une réaction immunitaire, son état de
nutrition, son âge, et de facteurs non spécifiques de l'hôte
comme les facteurs environnementaux. Par suite, l'incidence, la gravité
et la létalité des diarrhées aiguesd'origine alimentaire
sont plus élevées chez certaines catégories
particulièrement vulnérables de la population, comme les enfants
de moins de cinq ans, les femmes enceintes, les personnes
immunodéprimées (patients subissant une transplantation d'organe,
une chimiothérapie contre le cancer, atteints du SIDA, etc.) et les
personnes âgées (GERBA et al., 1996). À côté
de ces facteurs prédisposant bien connus, de nouveaux facteurs sont
régulièrement identifiés [atteinte hépatique pour
septicémies à V. paraheamoliticus, thalassémie pour les
infections à Yersinia enterocolitica (HLADY et al., 1996, ADAMKIEWICZ et
al., 1998). Ces maladies peuvent entraîner des complications importantes,
notamment des atteintes intestinaux et systémiques, comme le syndrome
urémique hémolytique (SHU) (dysfonctionnement rénal et
troubles neurologiques) pour 10 % des infections à Escherichia coli 0157
:H7 accompagnées de diarrhées sanglantes, ou le syndrome de
GuillainBarré (atteinte dégénérative du tissu
nerveux, suivi d'une récupération lente et d'une
incapacité résiduelle prononcée) après une
infection à Campylobacter jejuni, des arthrites consécutives
à une salmonellose ou encore une encéphalite toxoplasmique
chronique (GRIFFIN et al., 1988, THOMSON et al., 1995). Plusieurs auteurs
estiment que des complications à long terme (séquelles) peuvent
survenir chez 2 à 3 % des maladies d'origine alimentaire (LINDSAY,
1997). Tandis que la diarrhée est le syndrome le plus fréquent
après la consommation d'aliments contaminés, d'autres affections
sont beaucoup plus sévères.
1.2.2. En Afrique
Dans les pays en voie de développement tels que la
plupart des pays africains, l'incidence des diarrhées aiguës
infantiles est nettement plus élevée : le nombre
d'épisodes varie de 3 à 9 par an et par enfant (BUISSON, 2001).
Quant à la situation au Burkina Faso, elle indique 6 à 8
épisodes par enfant et par an (OUERMI et al., 2007). Les maladies
diarrhéiques sont encore plus fréquentes et plus
sévères dans les parties les plus pauvres des pays en voie de
développement surtout dans les régions tropicales et
subtropicales.
Par exemple, selon l'OMS, le climat et les conditions
socio-économiques de l'Afrique occidentale favorisent le
développement des diarrhées infantiles.
1.3. Epidémiologie des
diarrhées infantiles
Un rapport de l'Organisation mondiale de la Santé
(OMS), établi en 2020, avançait le chiffre de 3,3 millions de
décès par diarrhée aiguë chez des enfants de moins de
5 ans en Afrique. Cependant, grâce aux campagnes de prévention, ce
chiffre était nettement inférieur à celui rapporté
en 1980 qui faisait état de 4,6 millions de décès dans les
mêmes régions.
1.3.1. Les
bactéries :Salmonella et Shigella
Les principales causes de Toxi-infections Alimentaires
Communautaires (TIAC) déclarées sont les salmonelles (70 % des
TIAC), Clostridium perfringens pour les plats en sauce et Staphyloccus aureus
pour les préparations ayant nécessité des manipulations et
des produits laitiers. D'autres bactéries comme Escherichia coli
entéropatogène, Shigella spp, Campylobacter jejuni, Les maladies
diarrhéiques sont en général transmises par l'eau et les
aliments contaminés. Il s'agit essentiellement d'un manque
d'hygiène dans le traitement des denrées alimentaires. Les
principaux vecteurs de ces maladies sont : Escherichia coli, Salmonella spp,
Shigella, Yersinia et Campylobacter Yersinia enterocolitica, Vibrio cholerae,
Clostridium difficile et Bacillus cereus sont également agents de
troubles transmis par l'eau et les aliments souillés.
1.3.2 facteurs environnementaux
favorisant les infections diarrhéiques
· Hygiène
L'hygiène se réfère aux pratiques
associées à l'assurance d'une bonne santé et de la
propreté. Le terme scientifique "hygiène" se réfère
au maintien de la santé et d'une vie saine. Il apparait dans des phrases
comme hygiène personnel, hygiène domestique, hygiène
dentaire, et hygiène occupationnelle et est fréquemment
utilisé en rapport avec la santé publique (ANDERSON et LACHAN,
2008). Selon GAUCI et al. (2008), les mesures d'hygiène ne constituent
pas un luxe mais une nécessité pour aider à réduire
l'expansion des maladies infectieuses. Or, dans la plupart des pays en
développement, ces mesures sont encore ignorées, non
respectées et constituent donc de sérieux problèmes de
santé publique. Une des graves conséquences du non respect des
mesures élémentaires d'hygiène est la hausse de
prévalence des maladies diarrhéiques ces dernières
années notamment en ce qui concerne les enfants. L'OMS estime que 98,8%
des cas de décès liés au manque d'hygiène
surviennent dans les pays en voie de développement dont les enfants
représentent les 90% (OMS, 2003). En effet, les enfants de moins de cinq
ans constituent la population vulnérable à ces agents. Ils sont
responsables de gastroentérites qui se manifestent par des
diarrhées aiguës nécessitant le plus souvent une
hospitalisation (WHO/UNICEF/USAID/CCCD, 2003). Certains microorganismes
persistent dans la l'environnement et réémergent grâce
à leur multi résistance. Ce fait a été
observé chez les bactéries isolées des vidanges et des
eaux (MALIK et AHMAD, 1994). 4.2. Mode alimentaire
L'évolution des maladies diarrhéiques reste
étroitement liée aux habitudes et modes alimentaires des
populations rurales. En effet, l'eau et les aliments sont réputés
être des réservoirs non négligeables des
entéropathogènes agents de ces pathologies infectieuses. Certains
germes comme les norovirus peuvent survivre dans l'environnement durant un long
temps et accroître alors le risque de contamination (GAUCI et al., 2008).
Les maladies causées par les entérobactéries
pathogènes à travers les eaux de consommation sont en majeure
partie d'origine fécale (ASHBOLT, 2004; HUNTER et al., 2002). Les
obstacles majeurs pour la santé des populations des pays en voie de
développement sont liés à la consommation de l'eau non
potable, à la pauvreté des districts sanitaires et au manque
d'hygiène (OMS, 2003). Ces facteurs contribuent ainsi à
l'émergence et à la réémergence de certaines
maladies induisant des épidémies voire des pandémies. Les
risques de contamination par le mode alimentaire sont énormes. Ils
peuvent résulter de la qualité des aliments en ce qui concerne la
matière première, du traitement dont ces aliments ont fait
l'objet (manquement aux règles d'hygiène, mauvaise conservation
des repas, etc....).
1.3.2Lutte contre les maladies
diarrhéiques
1.3.2 1. Lutte préventive
Dans le domaine des diarrhées infantiles, la
prévention comprend deux étapes successives qui sont
fréquemment rencontré en Afrique :
ü La première est d'éviter, devant une
diarrhée simple, une aggravation par le suivi d'un traitement correct,
appliqué à temps. Ceci relève essentiellement du
médecin et du personnel paramédical.
ü La deuxième consiste à éviter la
dissémination de la maladie en pratiquant une politique d'assainissement
(approvisionnement en eau potable, évacuation des matières et
eaux usées, amélioration de l'habitat), une politique
d'éducation sanitaire et enfin une politique en matière de
nutrition : contrôle des aliments et mise au point d'aliments
adéquats.
Dans cette tâche, le médecin collabore avec les
représentants d'autres services. Pour bien réussir ces mesures
préventives, quelques précautions élémentaires
s'imposent. En restauration collective, les principales mesures
préventives sont le respect des bonnes pratiques de transport, de
stockage et de préparation des aliments, le respect strict des
chaînes du chaud et du froid. En milieu familial, il est
recommandé de conserver les produits sensibles (viandes, oeufs,
poissons, etc.) dans le réfrigérateur et de les y placer
rapidement après achat, de bien cuire les oeufs destinés aux
personnes vulnérables (enfants, personnes âgées, femmes
enceintes), de préparer les aliments à base d'oeufs non cuits
(mayonnaise, pâtisserie) le plus près possible de la consommation
et de consommer les viandes hachées et les volailles cuites à
coeurs (absence de teinte rosée). Les règles d'hygiène
(lavage des mains à la sortie des toilettes, avant de préparer
les repas) et les bonnes pratiques permettant d'éviter les
contaminations croisées au moment de la préparation des aliments
(par exemple, ne pas utiliser le même couteau pour couper de la viande et
les crudités, nettoyage des plans de travail) ou lors du stockage
doivent être rappelées.
2. Genre Salmonella
2.1 Définition
Les Salmonelles sont des
bactéries entériques en forme de bâtonnet,
anaérobies facultatifs, à Gram négatif, avec des flagelles
péritriches, de 0,7-1,5 ×2,0-2,5 ìm ; elles sont
généralement mobiles, mais certains sérovars sont
immobiles comme Salmonella Gallinarumpullorum et d'autres ont perdu leurs
flagelles. Les Salmonella appartiennent à la famille des
Enterobacteriaceae et possèdent toutes leurs caractéristiques
biochimiques.
2.2Historique
L'agent pathogène de la fièvre typhoïde fut
découvert par Eberth en 1880 dans des coupes de rate et des ganglions
lymphatiques d'un malade mort de typhoïde (AVRIL et al., 1988). En 1886,
l'américain Daniel Salmon et ses collègues ont découvert
les bactéries responsables de la fièvre porcine : Salmonella
choleraesuis. Ensuite, Widal fût le premier en 1896 à montrer que
le sérum des malades atteints de fièvre typhoïde agglutinait
des cultures du bacille d'Eberth (premier sérodiagnostic de l'histoire)
(AVRIL et al., 1988). Le terme de Salmonella ne fut créé qu'en
1900 par Lignières, en l'honneur de Daniel Elmer Salmon, directeur des
services vétérinaires des États-Unis à cette
époque.
Les salmonelles sont des bactéries entériques,
acquises par voie orale et adaptée à la vie dans le mucus du
tractus digestif. Elles ont un tropisme particulier pour le tube digestif des
animaux en général, et des volailles en particulier, qui
constituent sans doute le réservoir d'origine. Ce tropisme est
lié à l'évolution de ces bactéries avec leur niche
écologique durant des millénaires, qui a abouti à une
sélection de gènes adaptés, notamment liés à
leur caractère microaérobie, à leur métabolisme et
à leurs caractères physiques, leur permettant de se mouvoir dans
le mucus digestif. Elles ont été isolées dans l'intestin
de porc par Theobald Smith et Daniel Elmer Salmon '(Jajere, 2019) et compte
depuis 2004, 3 espèces : Salmonella bongori, Salmonella
subterraneaet Salmonella enterica ''''''''''''(Nau et al., 2010).
La maladie humaine la plus fréquemment associée au salmonellose
est, par conséquent, une entérite aiguë causée par
une infection intestinale qui peut se compliquer par des localisations
secondaires et d'un syndrome post-infectieux(Fresney, 2007). A l'exception de
Salmonella Typhi et des sérotypes paratyphiques (A, C et certaines
souches de B) qui sont spécifiques de l'homme, toutes les autres
infections dues aux salmonelles non typhiques peuvent être
considérées comme des zoonoses(Michel et al., 2018). La
salmonellose est sans doute la zoonose d'origine alimentaire la plus
répandue dans le monde. En général, l'homme se contamine
en ingérant des aliments contaminés, le plus souvent d'origine
animale (viande, et en particulier de volailles, produits carnés, oeufs
et produits laitiers) consommés crus, insuffisamment cuits ou
recontaminés après cuisson. Il est de transmission
oro-fécale, verticale et horizontale-(Mares, 2017). Différents
sérovars de Salmonella enterica sont zoonotiques et
responsables de toxi-infections alimentaires dans le monde. D'autres sont
responsables de salmonelloses mineures transmises par contamination
alimentaire'(Deguenon et al., 2019).
C'est la maladie la plus importante en termes d'impact sur la
morbidité et la mortalité chez l'Homme. Les salmonelles humaines
surviennent sous forme sporadique ou de TIA mais elles peuvent aussi
entraîner des épidémies régionales, voire
internationales (Delmas & Fuhrman, 2010);(Rahman, 2015).
2.3.Caractéristiques
morphologiques des salmonelles
Les salmonelles sont des bacilles Gram négatif, mobiles
péritriches à l'exception de Salmonella Gallinarumet
Salmonella Pullorum(A. Andino & I. Hanning, 2015).
Les Salmonelles ont une paroi épaisse de 8 à 12
nm. En microscopie optique, elles apparaissent comme des bâtonnets
à Gram négatif de 2 à 3 ìm de longueur et de 0,6
à 0,8 ìm de largeur. Le constituant le plus essentiel dans une
membrane des bactéries à Gram-négatif, est un lipide
complexe ; lipopolysaccharide (LPS). Celipopolysaccharide est un complexe
macromoléculaire toxique présent de manière constitutive
dans la membrane externe. (Avril et al., 1992). Les Salmonella sont des
bactéries mobiles grâce à de fins filaments
protéiques capilliformes : les flagelles. Ils présentent trois
parties :
Un Filament hélicoïdal rigide de10um de longueur
;
Un crochet, très cours (60um) ;
Un corpuscule basal, il correspond à la zone
d'insertion du flagelle dans le corps cellulaire. Cette structure est
douée d'un pouvoir pathogène par l'intermédiaire de
l'antigène flagellaire H, celui-ci est constitué de
sous-unités protéiques : flagelline (Avril et al, 1992)
Elles sont aéro-anaérobies facultatives et se
cultivent sur milieu ordinaire. Après des étapes de
pré-enrichissement, d'enrichissement sélectif et de culture sur
milieu, elles présentent après une incubation de 24 heures
à 37°C, des colonies caractéristiques.
Ces colonies apparaissent roses à centre noir sur
gélose Xylose Lysine Deoxycholate, incolores sur gélose
Salmonella-Shigella et ambrées translucides sur
gélose Eosine Methylene Blue (Nau et al., 2010 ; Jajere,
2019).

Figure 1 : Salmonella au
microscope électronique
Source :
http://microbiology.free.fr/Presentations/salmonella.pdf
2.4Taxonomie et
nomenclature
Sur la base de tests phénotypiques et de tests
sérologiques, Kauffmann, pionnier de l'analyse du genre Salmonella,
avait individualisé plusieurs sous-genres et de très nombreuses
espèces de Salmonella. Depuis quelques années sur le plan
international, grâce aux études moléculaires basées
sur l'analyse comparative des gènes codant les ARN ribosomaux et sur des
techniques d'hybridation ADN-ADN, il fut proposé que le genre Salmonella
soit subdivisé en deux espèces distinctes : Salmonella enterica,
espèce majoritaire et Salmonella bongori. La première
espèce est, elle-même subdivisée en 6 sous-espèces :
enterica, salamae, Arizona, diarizonae, houtenae et indica (Grimont et al.,
2000 ; Olsen, 2005). Chacune des sous-espèces est subdivisée en
sérovars sur la base de caractères antigéniques,
somatiques et flagellaires. L'association de ces facteurs antigéniques
permet alors de définir une structure antigénique
complète, qui selon le schéma de Kauffmann-White,
caractérise une souche (Brisabois et al, 2016).
2.5 Habitat
La sous-espèce enterica comprend la plus grande
majorité des souches isolées chez l'homme et les animaux à
sang chaud ; les sous-espèces salamae, Arizona, diarizonae sont
fréquemment retrouvées dans la flore commensale de l'intestin des
animaux à sang froid mais peuvent être aussi isolées de
l'environnement ou des animaux à sang chaud. Les sous- espèces
houtenae, indica et l'espèce bongori sont très rarement
retrouvées et n'ont pas d'habitats préférentiels
(Brisabois et al, 2016). Bien que toute Salmonella isolée soit
considérée comme potentiellement pathogène pour l'homme,
la détermination du sérovar permet de mieux caractériser
la souche et de la restituer dans son contexte écologique ou
épidémiologique (Brisabois et al, 2016). Les Salmonella peuvent
se multiplier à une température comprise entre 5°C à
45°C avec un optimum 35°C - 37°C, et à des pH de 4,5
à 9. L'optimum est entre 6,4 à 7,5. On peut diviser les
Salmonella en trois groupes distincts : Les Salmonella spécifiques de
l'homme : Salmonella Typhimurium ; Salmonella paratyphi A et Salmonella sendai
responsables de fièvres typhoïdes et paratyphoïdes. Les
sérovars adaptées à des espèces animales :
Salmonella Gallinarumpullorum chez la volaille, Salmonella abortusovis chez le
mouton, Salmonella abortuse chez le cheval, Salmonella Typhisuis et Salmonella
choleraesuis chez le porc. Les autres sérovars sont ubiquistes et
peuvent infecter aussi l'homme que l'animal et sont à l'origine de la
plupart des salmonelloses humaines et animales.
Tableau II: Taxonomie de
Salmonelle
|
Domaine
|
Bacteria
|
|
Phylum
|
Proteobacteria
|
|
Classe
|
Gammaproteobacteria
|
|
Ordre
|
Enterobacteriale
|
|
Famille
|
Enterobacteriaceae
|
|
Genre
|
Salmonella
|
|
EspecesBongori
|
Salmonella enterica et Salmonella
|
|
Sous-especes salmonella enterica :
|
Enterica, salamae, arizonae, diarizonae, houtenae et indica.
|
2.6 Caractères
biochimiques
Les Salmonella ont des caractères biochimiques communs
fondamentaux. Lescaractéristiques biochimiques générales
de la plupart des sérotypes isolés chez l'homme et les animaux
à sang chaud sont :
· L'absence d'une uréase active, de tryptophane ou
de phénylalanine désaminase,
· L'absence de production d'indole et d'acétoine
(test de Voges-Proskauer négatif),
· La production d'hydrogène sulfureux à
partir du thiosulfate (présence d'un thiosulfate réductase) H2S :
+,
· La décarboxylation fréquente de la lysine
et de l'ornithine (pas le sérovarTyphy), LDC : + En plus de ces
caractères différentiels intrinsèques, les
Salmonella possèdent les caractères
généraux de la famille des Enterobacteriaceae qui sont :
ü Bacilles à coloration de Gram négatif ;
ü Souvent mobiles grâce à leur ciliature
péritriche (rarement immobiles), non sporulés;
ü Bacilles qui se cultivent sur les milieux ordinaires ;
ü Bacilles aéro-anaérobies facultatifs ;
ü Bacilles fermentant le glucose avec ou sans production
de gaz
ü Bacilles réduisant les nitrates en nitrites
ü Bacilles qui ne possèdent pas de cytochrome
oxydase.
ü Bacilles qui possèdent une catalase (Navoun,
2005)
2.7 Pouvoir pathogène
des Salmonelles
Le tableau II nous a permis de connaitre les différents
les sérovars et les problèmes de santé causés aux
hôtes (animal et homme).
Tableau III : Pouvoir
Pathogène des Salmonella isolé chez l'homme et les
animaux
|
Habitat
|
Serovars
|
Pouvoir pathogene
|
|
Strictement humain
|
Typhi, paratyphi A, paratyphi B et paratyphi C
|
Fièvre typhoïde et paratyphoïde
|
|
Strictement animal abortusovis (ovin),
|
Gallinarumet pullorum (volaille), choleraesuis (porc)
|
Infection avec signes cliniques chez l'animal
|
|
Salmonella ubiquiste sans specificite
d'hote
|
La majorité des sérotypes
TyphimuriumEnteritidishadar, Saint paul (volaille), derby,
branderburg (porc), dublin, montevideo (bovin)
|
Salmonellose de type gastroentérite chez
l'homme. Portage chez l'animal (porc, volaille)
|
Source : (Jabrane & Abdelkhalek, 2014)
2.8 Caractéristiques
antigéniques :
Chez Les salmonelles ont été distinguer par trois
types d'antigènes présentant un intérêt de
diagnostic (Dumas, 1958) :
· Antigène somatique O (Ag O)
:
L'antigène O est un antigène de la paroi. Les
antigènes O sont portés par les chaînes spécifiques
du lipopolysaccharide (LPS). L'antigène O possède des
propriétés immunisantes ; C'est un complexe contenant une
protéine, un polysaccharide et un composé phospholipidique. On
distingue 67 facteurs O selon la nature des sucres entrant dans la constitution
des unités oligosaccharidiques du polysaccharide (Humbert et al., 1998).
L'antigène O est formé d'une fraction lipidique appelée
lipide A qui est responsable des effets toxiques, d'une partie basale et du
polysaccharide support de la spécificité (Gledel et Corbion,
1991). Les antigènes sont classés en facteurs O majeurs et en
facteurs O accessoires. Les facteurs majeurs sont liés à la
présence de certains sucres (abéquose pour O : 4, tyvélose
pour O : 9) (Humbert et al.,1998). L'antigène somatique est stable ; il
résiste à l'alcool et au phénol pendant deux heures et
demi à la température de 100°C (Dumas, 1958).
· Antigène flagellaire (Ag H) :
C'est un polymère de flagelline (protéine de
structure des flagelles). Cet antigène est thermolabile, détruit
par la chaleur à 100°C, par l'action de l'alcool et par les
ferments protéolytiques. Il résiste au formol et perd son
agglutinabilité par les anticorps en présence d'alcool et d'acide
phénique. Son développement optimum s'obtient sur les milieux
liquides après un séjour de 8 heures à 37°C (Dumas,
1958). La grande majorité des sérovars possèdent deux
systèmes génétiques et peut exprimer alternativement deux
spécificités différentes pour leur antigène
flagellaire. On dit que les antigènes flagellaires de Salmonella sont
diphasiques (Humbert et al., 1998).
· L'antigène de virulence (Ag Vi) :
C'est un antigène de l'enveloppe ; Il a
été identifié chez trois types de sérovars : Typhi,
Paratyphi C et Dublin mais toutes les souches de ces sérovars ne
possèdent pas forcement cet antigène (Humbert et al.,1998). Cet
antigène est considéré comme un antigène de surface
(Dumas, 1958), il est distinct de l'antigène somatique et de
l'antigène flagellaire. L'antigène Vi rend les germes
inagglutinables par les anticorps O quand il est abondant. Il ne se
développe pas si les cultures sont effectuées au-dessous de
25°C et au-dessus de 40°C. Un chauffage à 100°C pendant
dix minutes le détruit et les germes deviennent agglutinables par les
anticorps O. Il est de nature glucidolipidopolypeptidique. A côté
de ces antigènes il existe dans le genre Salmonella, des structures
protéiques de surface : les pilis qui se différencient en pilis
communs (intervenant dans l'hémagglutination mannose dépendante)
et en pilis sexuels (intervenant dans la conjugaison bactérienne) et
dontla présence est codée par des plasmides (Gledel and Corbion,
1991).
2.9 génome de
Salmonella
Le génome de la bactérie est composé
d'un ADN chromosomique et d'un ou de plusieurs plasmides. La taille du
chromosome de Salmonella varie d'un sérotype à l'autre et elle
est comprise entre 4,5 et 4,9 Mbp (méga-paires de base). La membrane
cytoplasmique de la bactérie est entourée par le peptidoglycane
puis par la membrane externe qui porte les flagelles, pili, glycocalix et
lipopolysaccharide. Ces structures ont des rôles importants pour la
survie de la bactérie et comme facteurs de virulence.
2. 10 Mécanismes de
virulence
Après ingestion d'aliments contaminés par
Salmonella, cette dernièrese retrouve au niveau de l'estomac
puis atteint l'intestin. Dans la plupart des cas, elles colonisent la partie
inférieure de l'intestin appelé l'ileum (Galan, 1996).
Après attachement aux cellules épithéliales intestinales,
différentes portes d'entrée permettent la colonisation du tractus
intestinal : les cellules M, les entérocytes et les phagocytes CD18+
(Cossart and Sansonetti, 2004). Les portes d'entrée utilisées
varient en fonction des sérotypes de Salmonella à titre d'exemple
prenons le S. Typhimurium. Très rapidement après l'infection de
souris ou de veau (Manon, 2011), il a été décrit que S.
Typhimurium se retrouvait principalement associée aux plaques de Peyer
et plus précisément aux cellules M (Jepson and Clark, 2001; Jones
et al., 1994; Santos et al., 2002). Ces cellules M, localisées au niveau
de l'épithélium associé aux follicules, ont la
capacité d'échantillonner et de transloquer les antigènes
ou micro-organismes de la lumière intestinale vers les tissus
sous-jacents (Neutra, 1998). Salmonella peut aussi traverser la barrière
intestinale par l'invasion des entérocytes (Finlay and Falkow, 1990 ;
Santos et al., 2002). Lors du franchissement de la barrière intestinale
par les cellules M ou les entérocytes, les bactéries sont ensuite
phagocytées par les macrophages de la lamina propriaqui sont en contact
avec les cellules M des plaques de Peyer (Cossart and Sansonetti, 2004). Les
bactéries sont alors transportées jusqu'aux ganglions
mésentériques sous-jacents. Enfin, une autre voie permet à
Salmonella de franchir l'épithélium intestinal. Il s'agit de la
capture luminalevia les cellules phagocytaires CD18+ telles que les cellules
dendritiques. En effet, ces cellules projettent leurs dendrites à
travers l'épithélium intestinal, ce qui permet de transporter la
bactérie vers le pôle basolatéral de
l'épithélium (Santos and Baumler, 2004). Les phagocytes CD18+,
tout comme les macrophages, transporteraient aussi les salmonelles jusqu'aux
ganglions mésentériques. A ce stade, l'infection peut rester
localisée et entrainer une pathologie de type gastroentérite.
Dans ce cas, l'invasion cellulaire induit la mise en place d'une réponse
inflammatoire (Galan, 2001). Une infiltration importante entraine alors la
destruction de l'épithélium intestinal, la formation
d'oedème et la sécrétion de fluide au niveau de la
muqueuse intestinale (McCormick et al., 1998).
2.11. pouvoir pathogène
des Salmonelles
La salmonella est un groupe de bactérie capable de
causer une maladie infectieuse appelé salmonellose, les personnes qui
consomment des aliments contaminés par Salmonella sont susceptibles de
contracter la maladie. On distingue trois types de symptômes de
Salmonellose.
2.11.1
gastro-entérites
Les gastro-entérites sont provoquées par des
Salmonella non typhiques ubiquistes telles que S. Enteritidis et S.
Typhimurium présentes chez l'homme et les animaux.Comme un grand nombre
d'animaux sont porteurs de Salmonella, la contaminationhumaine peut se
faire par le biais de divers produits alimentaires (viande, et
particulièrementvolailles, produits carnés, oeufs et produits
laitiers). Les sérotypes majoritairement incriminéest S.
Enteritidis (rapport EFSA, 2008 publié en 2010). Cependant, il y a
l'émergence d'autres sérotypes tels que S. Infantis, 3e
sérotype le plus fréquemment incriminé (International
surveillance network for the enteric infections Salmonella, VTECO157
and Campylobacter. Annual Report 2004). Ce sérotype est passé de
la 5e à la 1èreposition en termes de prévalence. La
durée d'incubation est le plus souvent de un à deux jours. Elle
dépend de la santé de l'hôte, de la dose
ingérée et de la virulence de la souche de Salmonella. Les
gastro-entérites à Salmonella se manifestent par une
diarrhée, des vomissements, de la fièvre et des douleurs
abdominales qui surviennent généralement 12-36 heures
après l'ingestion. Ils sont la conséquence d'une inflammation de
la muqueuse intestinale et conduisent à une déshydratation
importante. Chez des adultes de condition physique normale, une
gastro-entéritedisparaît sans traitement après 3 à 5
jours en moyenne. Le traitement employé repose essentiellement sur la
réhydratation (AVRIL et al., 1992).
2.11.2 infections
systémiques ou fièvre typhoïde
Chez l'homme, il s'agit de la fièvre typhoïde ou
paratyphoïde et elles sont respectivement dues à S. Typhi et S.
Paratyphi. Ces sérotypes sont strictement adaptés à
l'homme. La maladie se transmet par ingestion d'aliments ou d'eau
contaminés par l'urine ou les fèces de personnes infectées
(malades, convalescents ou porteurs asymptomatiques). La plupart des personnes
infectées sont infectieuses jusqu'à la première semaine de
convalescence mais 10% des personnes non-traitées excrètent la
bactérie pendant plus de 3 mois. De plus, de 2 à 5% des personnes
non-traitées deviennent des porteurs asymptomatiques (Crumpet al., 2004
;Panget al., 1998). Cette maladie, qui constitue la forme la plus grave de
salmonellose, touche chaque année 22 millions de personnes dans le monde
et conduit à 217 000 décès (OMS, 2016). Elle a
pratiquement disparu des pays industrialisés mais reste un vrai
problème de santé publique dans les pays en voie de
développement (Crump et al., 2004). De plus, des souches S. Typhi
multirésistantes aux antibiotiques apparaissent de plus en plus,
augmentant ainsi l'incidence des fièvres typhoïdes mais aussi la
gravité des cas humains (OMS, 2015). En l'absence de traitement, la
fièvre typhoïde évolue sous forme de septicémie avec
des taux de mortalité de 24 plus de 10%. Cependant, grâce à
des antibiothérapies appropriées, les taux de mortalité
liés à la fièvre typhoïde sont de 1 à 4% (OMS,
2015). La fièvre paratyphoïde causée par S. Paratyphi
présente des symptômes similaires à ceux observés
lors de fièvre typhoïde mais elle est en général
moins sévère avec des taux de mortalité plus faibles. Les
animaux peuvent aussi développer des infections systémiques
à salmonelles : les bovins lorsqu'ils sont infectés par S.
Dublin, les porcins par S. Choleraesuis, les souris par la plupart des
sérotypes ubiquistes ainsi que les volailles par S. Gallinarum.
2.11.3. Toxi-infections
alimentaires collectives
La consommation simultanée par plusieurs personnes d'un
aliment massivement contaminé par des Salmonella « mineures »
(Salmonella typhi murium, S. enteritidis, S. dublin, etc...) entraîne une
cascade des cas de gastro-entérites, qui, simulant un véritable
empoisonnement, est appelé toxi-infection alimentaire collective (TIAC).
La période d'incubation est de 10 à 18 heures. Les troubles
durent en général 2 à 5 jours. Les complications sont
rares sauf chez les sujets à faibles moyens de défense. L'aliment
responsable est identifié par enquête
épidémiologique (enquête cas-témoin). Le diagnostic
se fait par la recherche de Salmonella dans les selles des malades et dans
l'aliment incriminé (s'il est encore accessible). Le traitement est le
même que celui des gastro-entérites (Avril et al., 1992). La
prévention repose essentiellement sur l'hygiène des cuisines
collectives (détection des porteurs sains, techniques de
préparation, techniques de conservation : « chaîne du chaud
» ou « chaîne du froid », etc....).
2.12. Cycle infectieux de
Salmonelle
Le cycle infectieux de Salmonella fait intervenir 3 grandes
étapes : (i) l'attachement, (ii) l'invasion cellulaire et (iii) la
survie et la multiplication intracellulaire.
2.12.1 Attachement aux cellules
La première étape dans la pathogénie de
Salmonella est l'attachement à la muqueuse intestinale dans les
parties distales de l'intestin (Lockman and Curtiss, 1992). Les
protéines, appelées adhésines, sont des molécules
de surface bactériennes qui permettent à la bactérie de
cibler et de coloniser les tissus de l'hôte par la reconnaissance d'un
récepteur spécifique ou non. Il existe 2 grandes familles
d'adhésines décrites ci-dessous : les fimbriae ou pili, et les
adhésines non fimbriaires. Le LPS et le flagelle, qui jouent aussi un
rôle dans l'adhésion des salmonelles, sont ensuite
présentés.
2.12.2 Invasion cellulaire
Après avoir adhéré à
l'épithélium intestinal, les salmonelles peuvent être
transloquées via les cellules M et les phagocytes CD18+, mais elles sont
aussi capables d'induire leur propre internalisation à
l'intérieur de cellules non phagocytaires professionnelles. Salmonella
possède différents facteurs d'invasion. Le mécanisme
d'entrée le mieux caractérisé chez Salmonella est un
mécanisme de type Trigger, c'est-à-dire qu'un système de
sécrétion de type III injecte différents effecteurs
bactériens directement à l'intérieur des cellules
hôtes. Ces effecteurs vont activer directement différentes
protéines cellulaires, amenant à une intense
polymérisation d'actine qui va se traduire par la formation de forts
renflements membranaires.
2.12.3. Survies et Multiplication
Intracellulaire
Dès que Salmonella entre dans la cellule hôte
via son T3SS-1, elle se retrouve dans une vacuole d'endocytose appelée
la SCV. Bien que les effecteurs SopB, SipA, AvrA et SptP
sécrétés par le T3SS-1 soient impliqués lors de la
phase précoce de la biogénèse de la SCV, le principal
facteur permettant la survie et la multiplication intracellulaire est un
deuxième système de sécrétion de type III,
appelé T3SS-2 (Ibarra and Steele-Mortimer, 2009). Malgré le
rôle crucial du T3SS-2 dans la virulence des salmonelles, le
fonctionnement du T3SS-2 et les interactions de ses effecteurs avec les
protéines cellulaires sont moins bien connus que ceux du T3SS-1.
Tableau VII :
Sérotypes de Salmonella isolés à N'Djamena au
Tchad
|
Sérotypes
|
Nombre
|
Source
|
Origine
|
|
S. Dublin 1
|
1
|
Hémocultures
|
Humaine
|
|
S. Uganda
|
1
|
Coprocultures
|
Humaine
|
|
S. Singapore
|
1
|
Coprocultures
|
Humaine
|
|
S. Hull
|
2
|
Coprocultures H
|
umaine
|
|
S. Branderup
|
1
|
Coprocultures
|
Humaine
|
|
S. Colindale
|
1
|
Coprocultures
|
Humaine
|
|
S. Infantis
|
2
|
Coprocultures
|
Humaine
|
|
S. Manhattan
|
1
|
Coprocultures
|
Humaine
|
|
S. Chagoua
|
2 C
|
oprocultures
|
Humaine
|
|
S. Enteritidis
|
5
|
Ganglions mesenter.
|
Bovins
|
|
S. Dublin
|
2
|
Ganglions mesenter.
|
Bovins
|
|
S. Amager
|
1
|
Ganglions mesenter.
|
Bovins
|
|
S. Milezi
|
1
|
Ganglions mesenter.
|
Bovins
|
|
S. Tchad
|
1
|
Ganglions mesenter.
|
Bovins
|
|
S. Dublin
|
1
|
Viscères
|
Caprins
|
|
S. Enteritidis
|
1
|
Viscères
|
Caprins
|
|
S. infantis
|
1
|
Viscères
|
Caprins
|
|
S. Teshie
|
1
|
Viscères
|
Caprins
|
|
S. Gallinarum
|
26
|
Cadavres
|
Poules
|
|
S. Hull
|
2
|
Cadavres
|
Poules
|
|
S. Anatum
|
1
|
Cadavres
|
Poules
|
|
S. Virchow
|
1
|
Cadavres
|
Poules
|
Source : (Perpezat et al., 1964)
2.13.3 Signes cliniques et traitements
Les salmonelloses d'origine animale provoquent une infection
intestinale chez l'homme. Celles-ci sont provoquées par des
Salmonella ubiquistes présentes chez l'homme etles animaux et
se caractérisent par une période d'incubation de 8 à 48
heures, après l'ingestion d'aliments contaminés et le
développement rapide d'une fièvre, de céphalées et
de malaises. La durée d'incubation dépend de la dose
ingérée, de la santé de l'hôte et des
caractéristiques de la souche de Salmonella. Dans la phase
d'état, les principaux symptômes sont des douleurs abdominales,
des nausées, des vomissements et de la diarrhée.
L'évolution clinique est, en général, bénigne et la
guérison intervient au bout de 2 à 4 jours. Bien que la
salmonellose affecte des sujets de tous âges, la fréquence est
beaucoup plus élevée chez les jeunes enfants, les personnes
âgées et les malades immunodéprimés chez lesquels
l'infection peut être plus sévère, voire mortelle (Weill,
2008). Dans les formes habituelles, la guérison est spontanée en
quelques jours et seul un traitement symptomatique est préconisé.
Le recours aux antibiotiques est donc à réserver aux patients
présentant soit une forme sévère ou des risques de
complication. Les fluoroquinolones (FQ) sont considérées comme le
traitement de choix chez l'adulte. Chez l'enfant, il fait appel aux
céphalosporines de troisième génération (C3G), les
FQ étant en général déconseillées pour cette
tranche d'âge. Les antibiotiques les plus anciens comme les
aminopénicillines, l'association triméthoprime
-sulfaméthoxazole (Sxt) et beaucoup plus rarement, les
phénicolés, peuvent être utilisés comme solutions
alternatives (Weill, 2008).
Ø Prévention
La meilleure protection contre le risque de salmonellose est
une bonne cuisson des aliments, en particulier des viandes, à au moins
65°C pendant 15 à 30 minutes. Pour le steak haché
congelé ou surgelé, la cuisson doit être effectuée
sans décongélation préalable, car elle augmente le risque
de multiplication bactérienne. Le froid bloque le développement
des bactéries mais ne les tue pas (Fresney et al., 2007).De 1985
à 1997, la prévalence des infections à Salmonella
Enteritidisa fortement augmenté en France : elle touche les
élevages de volailles et a la particularité d'être
présente non seulement à la surface de la coquille de l'oeuf,
mais dans le contenu même d'oeufs intacts. Il est pour cette raison
conseillé de conserver les oeufs au réfrigérateur, de
maintenir au froid les préparations à base d'oeufs sans cuisson
(mayonnaise, crèmes, pâtisseries ...) et de les consommer le plus
près possible de leur fabrication. De plus, les personnes les plus
vulnérables (personnes âgées, malades, nourrissons, femmes
enceintes) devraient éviter la consommation d'oeufs crus ou peu cuits.
Enfin, il est conseillé de se laver les mains après contact avec
un animal vivant (en particulier les reptiles), voire d'éviter les
contacts avec les reptiles de compagnie pour toutes les personnes
vulnérables (les nourrissons, les femmes enceintes, les personnes
immunodéprimées,
3. GenreShigella
La shigellose est une infection intestinale invasive
aiguë provoquée par des bactéries appartenant au genre
Shigella ; elle se manifeste cliniquement par une diarrhée
souvent sanglante(World Health Organization, 2008). Elle est endémique
dans de nombreux pays en développement et survient également sous
forme d'épidémies accompagnées d'une morbidité et
d'une mortalité élevées. Parmi les quatre espèces
de Shigella, Shigelladysenteriae type 1 (Sd1) est
particulièrement importante car elle est à l'origine de la forme
la plus grave de la maladie et peut occasionner de vastes
épidémies à l'échelle régionale(World Health
Organization, 2008). Les principaux obstacles à la lutte contre la
shigellose sont la facilité avec laquelle Shigella se transmet de
personne à personne et la vitesse d'apparition de la résistance
de cette bactérie aux anti-infectieux(World Health Organization, 2008).
L'incidence mondiale de la shigellose a été signalée
à environ 165 millions de cas, mais la mortalité a
considérablement diminué au cours des trois dernières
décennies. Les présentes directives sont destinées
à aider les autorités(Dekker & Frank, 2015) sanitaires
nationales, les responsables de la santé publique et les professionnels
de santé, y compris les membres d'agences internationales et
d'organisations non gouvernementales (ONG), dans leurs efforts de lutte contre
la shigellose endémique et épidémique. Le texte
décrit l'épidémiologie, les aspects cliniques et la prise
en charge de la maladie ainsi que les mesures à prendre pour se
préparer aux épidémies dues à Sd1 et les
maîtriser(World Health Organization, 2008). Les définitions
suivantes s'appliquent aux termes utilisés dans le présent
document :
ü Diarrhée sanglante. Il s'agit d'un diagnostic
clinique qui désigne tout épisode de diarrhée dans lequel
les selles molles ou aqueuses contiennent du sang frais visible(World Health
Organization, 2008). Le terme de diarrhée sanglante ne s'applique pas
aux épisodes dans lesquels le sang est présent en
traînées à la surface de selles moulées, n'est
détecté que par examen microscopique ou au moyen de tests
biochimiques ou dans lesquels les selles sont rendues noires par la
présence de sang digéré (méléna). Bien que
la diarrhée sanglante ait de nombreuses causes, cette définition
simple est largement utilisée pour la surveillance de la shigellose dans
la communauté.
ü Dysenterie. Ce terme à la même
signification que celui de diarrhée sanglante. Bien que les textes
médicaux l'utilisent souvent pour désigner un syndrome de
diarrhée sanglante avec fièvre, crampes abdominales, douleurs
rectales et selles contenant du mucus, ces aspects n'accompagnent pas toujours
la diarrhée sanglante ni ne définissent nécessairement son
étiologie ou déterminent le traitement approprié(World
Health Organization, 2008).
ü Dysenterie bacillaire. Il s'agit d'une dysenterie
provoquée par Shigella. Ce terme est souvent utilisé
pour distinguer la shigellose de la dysenterie amibienne, qui est due à
Entamoeba histolytica(McQuade et al., 2020).
ü Diarrhée invasive. Ce terme désigne la
diarrhée due à des bactéries pathogènes, dont
Shigella, certaines Salmonelles, Escherichia coli et Campylobacter
jejuni, qui envahissent la muqueuse intestinale où elles provoquent
inflammation et lésions tissulaires(Rogawski McQuade et al., 2020).
Lorsque du sang visible est présent, l'épisode peut aussi
être qualifié de dysenterie ou de diarrhée
sanglante (Mahmoudi et al., 2017).
Il s'agit de bactéries adaptées au parasitisme
du côlon de l'homme grâce à un plasmide responsable de leur
invasivité.Le genre Shigella est responsable de la dysenterie,
résultat de la destructiondes cellules épithéliales de la
muqueuse intestinale et du rectum. Il produit uneentérotoxine. La
transmission de Shigella sppse fait d'Homme à Homme ou par
l'intermédiaire d'eau ou aliments contaminés par des
déjections humaines. C'est une pathologie endémique dans les pays
les moins avancés avec une atteinte préférentielle des
enfants de moins de 5 ans (Afssaps, 2010).
Quatre espèces sont observées sur la base
antigénique du polysaccharide O pariétal : Shigella
dysenterae, Shigella flexneri, Shigella boydiiet Shigella sonnei
(Delarras, 2014)
Les Shigelles sont des bactéries strictement
humaines. Elles ne font pas partie de la flore intestinale normale ; on ne les
trouve que chez les malades, les convalescents et les rares porteurs sains.
Elles sont responsables de dysenterie bacillaire (Shigella
dysenteriae1) qui décimait les armées en campagne.
Actuellement, elles sont la cause, chez l'adulte, de colites infectieuses et
chez l'enfant, de gastro-entérites sévères avec
diarrhée muco-purulente et sanglante, fièvre et
déshydratation. Ces infections surviennent par petites
épidémies familiales ou des cantines scolaires. En France, c'est
Shigella sonneique l'on isole le plus souvent. Les Shigella
sont essentiellement rencontrées dans les pays chauds, en Asie
(Shigella flexneri, Shigella boydiiet Shigella sonnei), en
Afrique particulièrement au Burkina Faso, au Tchad, au Niger, Mali
etc... (Le Minor et Veron, 1989).
Il existe quatre espèces de Shigella :
Shigella dysenteriae1, Shigella flexneri, Shigella boydii et
Shigella sonnei.
Le bacille de Shiga (Shigella dysenteriae 1) est sans
contester celui qui détermine la dysenterie la plus grave. Elle est la
cause des grandes et longues endémies de dysenterie. En plus de
l'endotoxine sécrétée par l'ensemble des Shigelles,
Shigella dysenteriae 1 élabore de plus une toxine
protéique qui le rend plus pathogène que les autres. Son pouvoir
pathogène expérimental est net pour le lapin(Lavergne et Burdin
1969 ; Pilet et al., 1979). L'injection intraveineuse de 1/10
à 2 ml d'une culture de 24 heures en bouillon au lapin, entraîne
après deux à trois jours l'apparition d'une parésie, puis
d'une paralysie du train antérieur. Des selles diarrhéiques sont
émises, le train postérieur se paralyse. L'animal entre en coma,
puis meurt. Ce bacille a pour biotope préféré les pays
chauds et particulièrement en Asie. Les autres espèces,
Shigella flexneri, Shigella boydii et Shigella
sonnei provoquent également des diarrhées, mais dont le
pronostic est nettement plus favorable (Dupeyron, 1997 ; CDC, 2002,
Lavergne et Burdin, 1969). Il ressort que les principales causes des troubles
digestifs sont les bactéries (Escherichia coli, Salmonella et
les Shigella) (Bessimbaye et al., 2013).
3.1 Caractères
morphologiques
Les caractéristiques morphologiques des Shigelles
comprennent des bacilles gram négatif, non sporulés et non
capsulés. Elles sont généralement mobiles grâce
à des flagelles, bien que certaines souches puissent être non
mobiles. Leur forme est typiquement en bâtonnet. Ces bactéries
peuvent être observées au microscope comme des bacilles courts et
arrondis, mesurant environ 0,5 à 1,0 micron de largeur et 1,5 à
3,0 microns de longueur. Elles sont anaérobies facultatives et peuvent
se cultiver sur milieu sélectif SS (gélose
Salmonella-Shigella), Hectoene, Mac Conkey et milieu
lactosé non sélectif (Phe, 2014 ; Bianchi et al.,
2019).
En culture, elles peuvent apparaître sous forme de
colonies rondes et lisses sur des milieux de culture appropriés.

Figure 2 : Shigella
sonnei (cliché Wadsworth center, 2007)
3.2 Caractères culturaux
et biochimiques
Ce sont bacille à Gram négatif immobile, La
température optimale de culture est de 37° C, supportent les Ph
alcalin, aeroanerobies facultatifs, sur milieu Hektoen les colonies sont vertes
de 2-4 mm de diamètre à bord régulier, lisses. Ses
caracteres Biochimiques : faible pouvoir métabolique : Fermentent le
glucose sans production de gaz, n'utilisent ni le lactose ni le saccharose, pas
de production d'H2S, pas d'utilisation du citrate, LDC-, urée-, indole-.
Les antigéniques : Ag O : antigène somatique permet la
détermination des serovars au sein d'une même
espèce .les produits élaborés sont : toxines - LPS :
endotoxine des bactéries à Gram négatif. - Exotoxine
thermolabile produite essentiellement par S.dysenteriae, constituée de 2
parties : A et B, cette toxine a une action
: cytotoxique : mort des cellules épithéliales
du colon Neurotoxique : paralysie des souris Enterotoxique.


Figure 3:
Généralités sur les entérobactéries
Source : (Schmitt, 2011)
3.3 Taxonomie et nomenclature
L'agent pathogène Shigella est un bacille
à Gram négatif, immobile, qui appartient à la famille des
Enterobacteriaceae(World HealthOrganization, 2008). Le genre Shigella comprend
quatre espèces : S. dysenteriae, S. flexneri, S. boydii et S. sonnei,
également désignées par l'appellation de groupes A, B, C
et D respectivement(World Health Organization, 2008). Les trois
premières espèces possèdent de multiples sérotypes.
S. sonnei et S. boydii provoquent habituellement une maladie relativement
bénigne avec diarrhée aqueuse ou sanglante(World Health
Organization, 2008). S. flexneri est la cause principale de la
shigellose endémique dans les pays en développement(World Health
Organization, 2008).
L'immunité est spécifique de sérotype.
Sd1, ou bacille de Shiga, diffère des autres Shigella par quatre aspects
importants :
· Il produit une puissante toxine (toxine de
Shiga) ;
· il provoque une maladie plus grave, plus longue et plus
fréquemment mortelle que les autres Shigella ;
· Il est plus souvent résistant aux
anti-infectieux que les autres Shigella ;
· il provoque de vastes épidémies, souvent
à l'échelle d'une région, avec souvent des taux d'attaque
et des taux de létalité élevés.
Toutes les espèces de Shigella provoquent une
diarrhée sanglante aiguë en envahissant et en détruisant par
plages l'épithélium du côlon(World Health Organization,
2008). Il s'ensuit la formation de microulcérations et d'exsudats
inflammatoires, et l'apparition de cellules inflammatoires (leucocytes
polynucléaires) et de sang dans les selles(World Health Organization,
2008). Les selles diarrhéiques contiennent de 106 à
108Shigella par gramme. Une fois excrété, le
bacille est très sensible aux conditions environnementales et meurt
rapidement, surtout s'il est exposé à la dessiccation ou à
la lumière solaire directe(World Health Organization, 2008).
3.4 Epidémiologie
3.4.1 Épidémiologie de la
shigellose
La shigellose est une infection gastro-intestinale
causée par l'une des quatre espèces de
bactéries Shigella, dont S. sonnei. Il s'agit
d'un agent pathogène virulent dont la dose infectieuse est très
faible, ce qui signifie qu'il suffit d'un petit nombre de bactéries,
soit environ 10 à 100 organismes, pour provoquer la maladie. Les
êtres humains constituent le seul réservoir connu et peuvent
excréter des bactéries dans les selles pendant des semaines
après avoir présenté une diarrhée sanglante.
Les Shigella se trouvent dans le tractus intestinal
des personnes infectées et peuvent se transmettre par voie
fécale-orale à la suite d'un contact direct entre personnes, d'un
contact avec les selles d'une personne infectée ou d'un contact
indirect, par exemple par l'intermédiaire de mouches, d'objets
souillés ou de la consommation d'aliments ou d'eau contaminés.
Les porteurs asymptomatiques peuvent également transmettre la maladie.
La transmission sexuelle durable est devenue une voie de transmission
importante de la shigellose.
Les symptômes les plus courants associés aux
infections à S. sonnei comprennent : diarrhée
aqueuse ou sanglante, douleurs et crampes abdominales, fièvre,
nausées, vomissements, perte d'appétit, maux de tête et
malaise. La plupart des infections à S. sonnei provoquent
une maladie de courte durée, avec une guérison en une semaine et
un faible taux de létalité, mais ce pronostic n'est pas toujours
applicable aux sujets immunodéprimés et des complications peuvent
survenir. Les infections modérées à sévères
sont habituellement traitées par des antibiotiques, mais compte tenu de
l'incidence croissante des Shigella multirésistantes et
ultrarésistantes dans le monde, les options thérapeutiques sont
de plus en plus limitées. Des cas d'infections à S.
sonnei ultrarésistantes ont été signalés
précédemment en Australie et aux États-Unis
d'Amérique.
La shigellose est endémique dans la plupart des pays
à revenu faible ou intermédiaire (PRFI) et est une cause majeure
de diarrhée sanglante dans le monde. On estime que chaque année,
elle est à l'origine d'au moins 80 millions de cas de
diarrhée sanglante et de 700 000 décès. La
quasi-totalité (99 %) des infections à Shigella se
produisent dans les PRFI et la majorité des cas (~70 %) et des
décès (~60 %) concernent des enfants de moins de cinq ans.
On estime que <1 % des cas bénéficient d'un traitement en
milieu hospitalier.
3.4.2Charge de morbidité Shigellose
endémique
La shigellose est endémique dans la plupart des pays
en développement et constitue la première cause de
diarrhée sanglante dans le monde(World Health Organization, 2008). On
estime qu'elle provoque chaque année au moins 80 millions de cas de
diarrhée sanglante et 700 000 décès(World Health
Organization, 2008). Quatre-vingt-dix-neuf pour cent des infections dues
à Shigella surviennent dans les pays en développement, et la
plupart des cas (environ 70 %) et des décès (environ 60 %)
concernent des enfants de moins de cinq ans. Probablement moins de 1 % des cas
sont traités à l'hôpital--'--'-(Ung et al., 2019).
3.4.3Epidémies dues à
Shigella dysenterie 1
Les flambées de diarrhée sanglante due à
Sd1 sont très fréquentes dans les zones pauvres et
surpeuplées, avec un assainissement insuffisant et de mauvaises
conditions d'hygiène et d'approvisionnement en eau(World Health
Organization, 2008). Les réfugiés et les populations
déplacées sont particulièrement exposés au risque.
Au cours des vingt dernières années, des flambées
épidémiques de grande ampleur ont éclaté en
Afrique, en Asie du Sud et en Amérique centrale(World Health
Organization, 2008). Entre 1993 et 1995, des flambées ont
été rapportées dans plusieurs pays d'Afrique centrale et
australe(World Health Organization, 2008). En 1994, une flambée brutale
parmi les réfugiés rwandais au Zaïre a provoqué
environ 20 000 décès au cours du seul premier mois(World Health
Organization, 2008). Entre 1999 et 2003, des flambées ont
été rapportées en Sierra Leone, au Libéria, en
Guinée, au Sénégal, en Angola, en République
centrafricaine et en République démocratique du Congo(World
Health Organization, 2008). En 2000, des flambées de diarrhée
sanglante due à Sd1 résistant aux fluoroquinolones ont
été observées en Inde et au Bangladesh. En Amérique
centrale, la plus récente des épidémies de grande ampleur
a duré de 1969 à 1973 et a provoqué plus de 500 000 cas et
20 000 décès(World Health Organization, 2008).
3.5Pouvoir Pathogène
3.5.1Dysenterie bacillaire
C'est la forme la plus sévère des infections
à Shigella(Charles & Jean-Louis, 2007). Elle est due à S.
dysenteriae, sérotype 1. Après une brève incubation de 1
à 2 jours, elle se traduit pardes douleurs abdominales, de la
fièvre et l'émission de selles afécales faites de glaires
mucosanglantes(Charles & Jean-Louis, 2007). Des perforations coliques
peuvent se produire. La maladie peut se propager sur le mode
épidémique et entraîner une mortalité
appréciable sur des terrains fragiles(Charles & Jean-Louis,
2007).
3.5.2 Syndrome diarrhéique
Les infections à Shigella se traduisent plus
souvent par une diarrhée d'allure plus commune. Elles surviennent
surtout chez l'enfant(Charles & Jean-Louis, 2007). La diarrhée peut
être sanglante et suivie parfois d'un syndrome hémolytique et
urémique. Les infections à Shigella sont très
fréquentes dans les pays en voie de développement, mais
s'observent aussi dans nos régions, avec une incidence beaucoup plus
faible(Charles & Jean-Louis, 2007). Les shigelles sont responsables d'une
partie des diarrhées des voyageurs(Charles & Jean-Louis, 2007).
3.5.3Facteurs de
Pathogénicité
ü Pouvoir invasif
Les shigelles envahissent le côlon (surtout dans sa
partie distale) et provoquent une intense réaction inflammatoire au
niveau de la muqueuse et de la lamina propria, ainsi que des
ulcérations(Charles & Jean-Louis, 2007). Les bactéries n'ont
pas tendance à se propager au-delà du côlon. Les shigelles
ont la capacité d'envahir des cellules épithéliales
grâce à un groupe de gènes plasmidiques (Ipa)(Charles &
Jean-Louis, 2007). Elles provoquent au niveau de la cellule
épithéliale des remaniements du cytosquelette qui permettent leur
ingestion par un processus analogue à la phagocytose(Charles &
Jean-Louis, 2007). Les shigelles lysent ensuite la vacuole de phagocytose et se
multiplient activement dans le cytoplasme(Charles & Jean-Louis, 2007).
Elles peuvent se déplacer dans la cellule et même d'une cellule
à l'autre en provoquant une polymérisation de l'actine à
un de leur pôle (grâce à un autre gène plasmidique).
Lorsqu'elles sont phagocytées par des macrophages elles provoquent la
mort cellulaire par apoptose et la libération de cytokines
pro-inflammatoires, comme l'IL-1â. Les lésions semblent
résulter à la fois de la prolifération bactérienne
intracellulaire et de la réponse inflammatoire très
intense(Charles & Jean-Louis, 2007).
ü Toxines
S. dysenteriae produit une toxine de structure complexe, faite
d'une chaîne polypeptidique A et de 5 chaînes B. Les chaînes
B assurent la fixation de la toxine sur son récepteur cellulaire. La
chaîne A pénètre dans la cellule et clive un résidu
adénine au niveau d'un ARN ribosomal(Charles & Jean-Louis, 2007).
Cette altération entraîne l'arrêt des synthèses
protéiques et la mort cellulaire. La diffusion de la toxine de Shiga
semble impliquée dans le syndrome hémolytique et urémique.
Elle est très proche de la Shiga-like toxin des Escherichia
coli entérohémorragiques. Deux entérotoxines (1 et 2)
ont été décrites. Elles jouent un rôle dans la
diarrhée(Charles & Jean-Louis, 2007). L'entérotoxine 1 est
produite par S. flexneri, l'entérotoxine 2, codée par un
gène plasmidique, peut être produite par différentes
espèces de shigelles(Charles & Jean-Louis, 2007) .
3.5.4Surveillance
La détection et la notification rapides des cas de
diarrhée sanglante constituent la première étape,
capitale, de la surveillance de la shigellose endémique et de la lutte
contre la shigellose épidémique, et également des
flambées de cas de dysenterie dus à E. coli
entéro-hémorragique(World HealthOrganization, 2008). Le nombre de
cas de diarrhée sanglante et de décès associés doit
être déterminé et rapporté pour deux groupes
d'âge, les enfants de moins de cinq ans et les patients de cinq ans et
plus--'--'-(Ung et al., 2019). Tous les établissements de santé
doivent désigner un responsable qui sera chargé de la
notification exhaustive des cas de diarrhée sanglante et des
décès associés(World Health Organization, 2008). Les
rapports doivent être envoyés une fois par semaine au responsable
sanitaire de district chargé de la surveillance de l'apparition des cas
et de la détection des flambées épidémiques. Aux
fins de surveillance, la définition standard des cas de diarrhée
sanglante ou de dysenterie est « diarrhée avec présence de
sang visible dans les selles »(World Health Organization, 2008).
Shigella est fortement associée à la
dysenterie (McQuade et al., 2020).En conséquence, les lignes directrices
de l'OMS recommandent le traitement de tous les cas pédiatriques de
dysenterie avec de la ciprofloxacine ou de l'azithromycine pour une infection
présumée à Shigella (Williams, 2018).
3.5.5 Bases du Traitement
En dehors du traitement symptomatique (réhydratation),
il comprend l'administration d'un antibiotique. Les shigellose n'ont pas de
résistance naturelle vis-à-vis des antibiotiques actifs sur les
bactéries à Gram négatif, mais les résistances
acquises ne sont pas rares, d'où la nécessité d'un
antibiogramme. En première intention, le cotrimoxazole, une
fluoroquinolone ou une pénicilline A peuvent être
utilisés.
3.6Shigella Vaccin
La diminution de l'incidence de la shigellose avec l'âge
suggère qu'une immunité naturelle se développe, ce qui
implique que les vaccins suscitant cette réponse naturelle peuvent
être efficaces(Dekker el al., 2015). Il n'existe actuellement aucun
vaccin Shigella homologué, mais il existe de nombreux vaccins
en phase préclinique ou d'essais cliniques, y compris des vaccins
vivants atténués, des vaccins à cellules entières
tuées, des vaccins conjugués et des vaccins sous-unitaires
(Kim et al.,2013). Des vaccins ont été
conçus contre les antigènes O, et des vaccins conjugués
ont également été développés à l'aide
de plusieurs molécules antigéniques conservées
(Barry et al.,2013). Les données sont limitées
en ce qui concerne le paramètre immunitaire qui est en
corrélation avec l'immunité protectrice (Porter et
al.,2013). D'autres études sont nécessaires avant de
savoir si un vaccin Shigella s'avérera efficace(Dekker &
Frank, 2015).
Chapitre.2
Antibiotiques
2.1. Définition
Un antibiotique, du grec « anti » et « bios
» qui signifient respectivement « contre » « la vie »,
est une substance chimique produite par des moisissures ou certaines
bactéries afin de tuer ou bloquer la croissance d'autres
bactéries (Muylaert et Mainil, 2012). Il est dit bactéricide
lorsque l'antibiotique élimine 99,99 % des bactéries cibles et
bactériostatique quand l'antibiotique bloque la croissance
bactérienne. Les antibiotiques peuvent être produits naturellement
ou par synthèse chimique (on parle d'antibiotique de synthèse)
(Walsh et Wright, 2005). Dans tous les cas, il est produit de façon
sélective pour lutter contre certaines bactéries et n'a aucun
effet sur les cellules humaines, les moisissures et les virus. Les
antibiotiques agissent de diverses manières sur des cibles bien
spécifiques. La résistance d'une bactérie à un
antibiotique se définit par sa capacité à croitre en
présence d'un antibiotique donné. Une bactérie est dite
multi-résistante lorsqu'elle résiste à au moins trois (3)
antibiotiques appartenant à trois (3) familles différentes
(Dureja et al., 2014). Le manuel bien connu de Brock de la microbiologie
définit un antibiotique comme un agent chimique produite par un
organisme et qui est nuisible à d'autres organismes (Yao,
2019.).
2.2Resistance
Bactérienne
De nos jours beaucoup
d'antibiotiques sont connus, mais leur surconsommation entraîne des
résistances de certaines bactéries à certains d'entre eux,
et même des multi résistances, au point de rendre à nouveau
incurables les premières maladies que nous avons traitées avec
succès avec les premiers antibiotiques(Carrière,
2001 ;Andremont A, 2011 ; Gangoue, 2007)).
Le développement de la résistance aux
antibiotiques constitue un problème de santé publique d'ampleur
mondiale nécessitant une intervention urgente et concertée des
citoyens, des gouvernements, des médecins et vétérinaires,
des éleveurs, des industries pharmaceutiques ainsi que des ONG
nationales et internationales de santé publique (Tigaud, 2015 ;
Longenberger et al., 2014).
2.2.1. Définition
Une souche est dite résistante lorsque la concentration
d'antibiotiques qu'elle est capable de supporter est notablement
supérieure à la concentration que l'on peut réaliser au
lieu où se trouve la bactérie, et où quand elle supporte
une concentration d'antibiotiques très supérieure à celle
qui inhibe le développement de la majorité des autres souches de
la même espèce (CA-SFM, 2022). La résistance peut
être naturelle ou acquise (Cambau, 1997 ; Duval, 1980). Il existe
plusieurs types de résistance.
Il existe deux types de résistance aux antibiotiques
à savoir la résistance naturelle ainsi que la résistance
acquise des souches.
2.2.2 Résistance
naturelle
La résistance naturelle ou résistance
innée ou encore résistance intrinsèque est la
capacité de toutes les espèces d'une bactérie
donnée à se développer en présence d'un
antibiotique donné. Cette résistance est surtout portée
par les chromosomes et toutes les espèces présentent le
même profil de résistance (Philippon et Arlet, 2012). Ce type de
résistance est transmis aux générations issues de la
même espèce de façon verticale mais pas de façon
horizontale c'est-à-dire entre des espèces
phylogénétiquement différentes. La résistance
naturelle peut être due à la production d'une enzyme
(pénicillinase, bêta-lactamase par exemple) agissant sur des
antibiotiques donnés (Walsh et Wright, 2005) ou par
l'imperméabilité d'un antibiotique au sein d'une bactérie
(Mérens et al., 2011). Les études ont montré que les
bactéries à Gram négatif (E. coli,
Salmonella) présentent une résistance naturelle
vis-à-vis des macrolides qui sont des grosses molécules. Au
regard du mode d'action, on peut observer une résistance naturelle de
certaines souches vis-à-vis de certains antibiotiques. Par exemple, les
antibiotiques agissant sur la paroi bactérienne n'ont aucun effet sur
les bactéries à Gram négatif presque dépourvu de
ladite paroi.).
2.2.3 Résistance
acquise
Outre la résistance naturelle, il existe la
résistance acquise au fil du temps et au regard de certaines conditions
(Ploy et Denis, 2000). Ce type de résistance n'est pas stable au sein
d'une espèce bactérienne et s'acquière dans le temps sous
certaines conditions. Elle n'affecte pas toutes les espèces d'une
bactérie. Elle peut être porter par un chromosome, soit des
transposons ou par des plasmides conférant la résistance à
certains antibiotiques (Gassama et al., 2010; Mérens et al., 2011).
Comparativement à la résistance naturelle, ce type de
résistance peut être transféré de façon
horizontale c'est-à-dire entre des espèces
phylogénétiquement différentes par l'intermédiaire
de la conjugaison bactérienne (Muylaert et Mainil, 2012). Elle constitue
de nos jours un véritable problème de santé publique et
touche la plupart des espèces bactériennes pathogènes et
non pathogènes. La résistance acquise peut avoir plusieurs causes
telles que la présence d'une forte quantité de résidus
d'antibiotiques, l'automédication, ainsi que l'usage abusive des
antibiotiques dans l'antibiothérapie. La résistance acquise se
fait au moyen de plusieurs mécanismes, surtout moléculaires.
2.2.4 Causes des
résistances acquises
La cause principale se trouve dans le mauvais usage des
antibiotiques, souvent lorsqu'ils ne sont pas indiqués à des
doses insuffisantes, quelque fois en croyant éliminer un germe alors que
s'en est un autre qui est responsable de l'infection. Des considérations
qui ne sont pas vraiment médicales conduisent trop souvent à
employer le dernier antibiotique connu, favorisant ainsi l'émergence des
germes qui lui seront rapidement résistant alors que d'autres plus
anciens auraient largement suffit (Bimetetal.,
2000 ; Dupeyron, 1997).
2.2.5 résistance
croisée
La résistance croisée fait
référence au spectre d'inactivation liée à un
même mécanisme de résistance vis-à-vis de divers
antibiotiques appartenants à la même famille ou sous-groupe. Cette
notion et utilisée lors de lecture interprétative de
l'antibiogramme. Parmi les nombreux cas de résistances croisées,
des mutations dans les topoisomérases type II, gyrase ou
topoisomérases IV induisent la résistance à l'ensemble des
Fluoroquinolones. Un autre exemple de résistance croisée est
celui de la résistance à la méticilline des staphylocoques
par la production d'une nouvelle PLP2a qui procure également la
résistance aux autres molécules de la famille des â-
lactamines. La conséquence majeure de la résistance
croisée est la sélection croisée. Quant à
laco-résistance, plusieurs mécanismes de résistance
peuvent être associés chez la même bactérie, parfois
stabilisés par intégration dans le chromosome. Chacun des
mécanismes confère par résistance croisée la
résistance à un groupe d'antibiotique conférant à
la bactérie un large spectre de résistance
(Moubarecketal., 2007).
2.2.6 Mécanismes
biochimiques de la résistance
Les mecanismesbiochimiques peuvent être
regroupés en trois grands types de mécanismes Cf (Figure
4) :
v Inactivation
enzymatique
Les résistances par l'inactivation enzymatique de
l'antibiotique : les bêtalactamases (pénicillinases,
céphalosporinases, imipénimases) sont les plus importantes. Ce
sont des enzymes sécrétées notamment par certains
Staphylocoques, Haemophilus, Neisseria et plusieurs
entérobactéries, qui détruisent les antibiotiques à
noyau Bêta-Lactam (Bêta-Lactamines). Signalons au passage que les
pénicillines agissent en empêchant la synthèse du
peptidoglycane, principale constituant de la paroi bactérienne. Il
existe un antagoniste aux bêtalactamases ; l'acide clavulanique
lui-même élaboré par un champignon, Streptomyces
clavuligenus. Cette sécrétion est en générale
naturelle à un taux suffisant pour être efficace. Mais dans
certains cas, la bactérie est naturellement productrice de cette enzyme
à un taux faible, peu efficace. Elle peut subir une augmentation
temporaire de cette sécrétion par le contacte avec un
antibiotique de la famille des bêta-lactamines. C'est le seul cas ou la
résistance est induite par la présence du germe
(Zebaetal., 2007 ; Cambau, 1997). Prenons l'exemple des
ß-lactamines chez un bacille à Gram-négatif, qui pour agir,
doivent traverser la membrane externe ou la paroi au niveau des porines (motif
en bleu ; Figure 8), puis traverser l'espace cytoplasmique et enfin se
fixer sur des cibles ou protéines liant la pénicilline (PLP en
marron : Figure 8) qui sont situées principalement au niveau de la
membrane cytoplasmique. Cette fixation amène à une inhibition de
celles-ci (transpeptidase, transglycosylase....) entraînant des
modifications morphologiques de type filaments (Figure 9) ou au contraire
formes sphéroïdes. Le résultat final est une inhibition de
la synthèse du peptidoglycane (couche interne de la paroi en rose :
avec quelquefois, une lyse finale (Lozniewskia et Rabaud, 2010).

Figure 4 : modification morphologique d'une souche
bactérienne lors d'un traitement par une pénicilline à
large spectre (Philippon, 2004)
v Diminution de la
perméabilité de la membrane à l'antibiotique
La diminution
delaperméabilité(mutationaffectantlastructuredesporinesou
diminuantlasynthèsedesporines
parlesquellesl'antibiotiquepeutpénétrerdanslabactérie)eteffluxactif
:l'effluxreposesurunepompeinsérée
danslamembraneetcapabled'éjecterl'antibiotiquehorsdelabactériegrâceuncanal
;ceteffluxconduitàune diminution dela concentration intracellulaire de
l'antibiotique (Bimetet al., 2000 ; Cambau, 1997 ;
Carbonelletal., 1987 ; Yang etal., 2009).
v modification de cibles
La modification de la cibledes antibiotiques : modification
desPLP, les PLP ou "protéines liant les pénicillines"
sontdesenzymesquicatalysentl'étapefinaledelabiosynthèsedupeptidoglycane(paroibactérienne)etquisont
lacibledesbêta-lactamines(ensefixantauxPLPlesbéta-lactamineslesempêchentdejouerleurrôle
;la synthèse dupeptidoglycane est donc entravée). Trois
mécanismes peuvent intervenir (Figure 9) :
a)diminutiondel'affinitédesPLPpourlesbêta-lactamines(Streptococcuspneumoniae;lesbéta-
lactamines ont du mal à se fixer aux PLP qui restent disponibles pour la
synthèse du peptidoglycane) ;
b) augmentation dela synthèse
desPLPexistantes avec hyper-expression de PLPpossédant
naturellementunefaibleaffinitépourlesbêta-lactamines(Enterococcusspp
;casprécédentavecenplus
uneaugmentationdunombredePLPdisponiblespourlasynthèsedupeptidoglycanecequiconduitàune
impossibilité pour une même dose de béta-lactamines de
toutes les bloquer)
c)synthèsed'uneoudeplusieursnouvellesPLPinsensiblesauxbêta-lactamines(Staphylococcus
aureus: l'acquisition et l'intégration dans le chromosome
d'ungène(mecA), d'originemal connue, induitla
synthèsed'unenouvelle PLP,laPLP2aqui est capable d'assurerà elle
seulel'assemblagedu peptidoglycaneet elle confère une
résistanceà toutes lesbêta-lactamines (Lozniewskia et
Rabaud, 2010, Hedi et al., 2007).

Figure 5: Schéma récapitulatif des
quatre types de stratégie de résistance à un antibiotique
(Aarab et al., 2011).
v Excrétion par des systèmes
d'efflux
Enfin, l'excrétion de l'antibiotique hors de la
cellule : mécanisme rare. Bien entré dans la cellule, il en
est chassé avant d'avoir pu agir. Ces différents
mécanismes peuvent s'associer (Bimetetal., 2000 ; Cambau,
1997 ; Cattoir, 2004) (Figure 5).
Le système d'efflux actif est efficace grâce aux
protéines transmembranaires ancrées dans la membrane plasmique
mais également dans la membrane externe des bactéries Gram
négatif). Ces protéines sont spécifiques d'une classe
d'antibiotiques ou au contraire responsables de « multidrugresistance
» (MDR). Pour fonctionner, les pompes à efflux utilisent
l'énergie fournie par dissipation d'un gradient de protons (familles
MFS, RND et SMR) ou d'ions sodium (famille MATE) ou encore par hydrolyse d'ATP
(famille ABC) (Figure 5). En cas d'hyperexpression de ces systèmes, Chez
les bactéries à Gram positif, les systèmes d'efflux ne
sont constitués que d'une pompe transmembranaire. Chez les
bactéries à Gram négatif, les systèmes d'efflux
sont souvent des complexes protéiques ternaires avec une pompe
transmembranaire, une protéine périplasmique de jonction et une
porine de la membrane externe. Les pompes les plus fréquemment
rencontrées sont de type RND comme AcrB chez Escherichia coliou
MexB chez Pseudomonas aeruginosa(Cattoir, 2004). Lors d'une
hyperexpression, ces systèmes d'efflux, comme celui correspondant aux
gènes marRAB chez E. coli, entraîne une
résistance généralement à bas niveau et
croisée à différentes familles d'antibiotiques.

Figure 6 : Représentation
schématique des cinq familles de pompes d'efflux d'après CATTOIR
et al (2004)
MFS ou major facilitatorsuperfamily(ex. NorA chez
Staphylococcus aureus) ; SMR ousmallmultidrugresistance(ex.
EmrE chez Escherichia coli) ; MATE ou multidrug and toxic compound
extrusion (ex. NorM chez Vibrio parahaemolyticus) ; RND ou
resistance-nodulation cell division (ex. MexB chez Pseudomonas
aeruginosa) avec MexA (membrane fusion protein) etOprM (outer
membrane factor) ; ABC ou ATP-binding cassette (ex. LmrA chez
Lactococcus lactis). ME, EP : membrane externe et espace
périplasmique des bactéries à Gram négatif ; MC
:membrane cytoplasmique ; ATB : antibiotique.
2.2.7Salmonella et
résistance aux antimicrobiens
Salmonella est naturellement sensible à tous
les antibiotiques habituellement efficaces sur les bactéries à
Gram négatif. La résistance aux antibiotiques chez Salmonella est
devenue, ces dernières décennies, matière à
inquiétude pour la santé publique dans le monde (Weill et al.,
2004c). C'est à partir de 1997, que l'OMS signalait l'augmentation
alarmante de l'incidence de souches de Salmonella non typhiques
résistantes aux antibiotiques (WHO, 1997).
En 2002, plusieurs études comparatives de la
résistance aux antibiotiques chez Salmonella non typhiques d'origine
humaine, animale ou environnementale réalisée dans l'UE et
à travers d'autres continents a montré des niveaux de
multi-résistances très inquiétants (Boerlin et Reid-Smith,
2008 ; Cobbold et al., 2006 ; Lauderdale et al., 2006). L'analyse de la
sensibilité aux antimicrobiens des souches humaines du sérotype
Typhimurium a montré des niveaux élevés et stables de
multi-résistance depuis 1993. Il s'est avéré que cette
multi-résistance est due à la présence d'un clone
particulier, individualisé grâce à son lysotype DT104. Ce
clone a intégré dans son chromosome, un îlot
génomique de 43 kb, appelé Salmonella Genomic Island 1 (SGI1),
dont une partie porte les différents gènes impliqués dans
la résistance à l'ampicilline (A), blaPSE-1, à la
streptomycine (S) et à la spectinomycine, aadA1, au
chloramphénicole (C), floR, aux sulfamides (Su), sul1, et aux
tétracyclines (T), tetG, d'où son nom de clone
«penta-résistant» ou «ACSSuT» (Cloeckaert et al.,
2007 ; Mulvey et al., 2006 ; Weill, 2009). Il a d'abord émergé au
Royaume-Uni dès 1989 dans le bétail, puis chez les volailles,
moutons, porcs et chevaux et enfin chez l'homme. Il a ensuite
disséminé en Amérique du Nord et dans plusieurs pays
européens (Aarestrup et al., 2007 ; Casin et al., 1999 ; Glynn et al.,
1998 ; Threlfall et al., 2003). Salmonella Enteritidis, sérotype
prédominant chez l'homme jusqu'en 2004 en France, est resté
majoritairement multi-sensible aux antibiotiques sur la période 1993
à 2004, tandis que le sérotype Hadar, souvent retrouvé
dans la filière avicole, présentait des niveaux
élevés de multi-résistance aux antibiotiques (Weill,
2009). Ces dernières années, de plus en plus de sérotypes
de Salmonella ont acquis des résistances diverses à
plusieurs familles d'antibiotiques tels que les beta-lactamines (Weill et al.,
2004), les aminosides, les quinolones (Cloeckaert et Chaslus-Dancla, 2001), les
fluoroquinolones (Walker et al., 2000), les céphalosporines, etc.,
molécules de choix lorsqu'un traitement s'avère nécessaire
lors des infections systémiques à Salmonella (Stevens et
al., 2006 ; Threlfall, 2002 ; Weill, 2009). Depuis 2000, c'est le cas de
Salmonella Kentucky résistante à haut niveau aux
fluoroquinolones, qui a été identifiée chez l'homme en
France, au Danemark, en GrandeBretagne et aux USA. Les patients étaient
le plus souvent de retour d'un voyage au Maghreb. Cette souche appelée
ST198 serait apparue dans les années 90 en Egypte, aurait ensuite acquis
petit à petit tous ses déterminants de multi-résistance
dont la résistance à la ciprofloxacine en 2000. Ensuite elle
semble s'être disséminée rapidement à l'ensemble du
continent africain à partir de 2005, puis au Moyen-Orient et maintenant
en Asie (Le Hello et al., 2011, Guillon et al, 2013). Elle a également
été détectée dans des élevages de volaille :
des poulets en Ethiopie en 2007 (Le Hello et al., 2011), des poules pondeuses
en Algérie en 2009 (Bouzidi et al., 2011), des dindes au Maroc
dès 2006 (Bouchrif et al., 2008) et en Pologne en 2010 (Wasyl et al.,
2012). Devant l'émergence mondiale de cette souche hautement
résistante aux antibiotiques, plusieurs microbiologistes dont Le Hello
et al. (2013).
v antibiotiques les plus utilisés
L'antibiothérapie est une approche très
précieuse, soumise à des règles strictes d'utilisations
dont l'inobservation peut avoir des conséquences très
regrettables :
- pour le patient traité, dont la guérison est
compromise ;
- parcequ'elle est à l'origine de l'acquisition de la
résistance des souches bactériennes.
v Règles
générales du choix des antibiotiques les plus
utilisés
La mise en oeuvre d'un traitement antibiothérapie,
nécessite un certain nombre de règles à suivre :
- le choix de l'antibiotique ;
- la dose en tenant compte d'une éventuelle
toxicité ;
- l'activité de l'antibiotique pendant une durée
suffisante en tenant compte des particularités : âge, sexe,
grossesse, et pathologies associées (Cambauetal., 1997 ;
Duval, 1980)
Au Tchad, il a été constaté, selon les
fiches d'enquêtes, que les antibiotiques des familles suivantes sont les
plus utilisés : Bêta-lactamines (Pénicillines,
Céphalosporines), Aminosides, Chloramphénicols,
Tétracyclines, Macrolides, Sulfamides, Quinolones, Fluoroquinolones et
divers''(Bessimbaye et al., 2021).
CHAPITRE 3 : Techniques moléculaires
deSalmonella et Shigella
A. Caractérisation des iso-enzymes
Analyse des modifications dans la structure de la
protéine (substitution d'acides aminés), qui est elle-même
le reflet de mutations d'ADN au niveau des gènes de structures de ces
protéines par électrophorèses en gel d'amidon ou
d'acrylamide-agarose, électrophorèse en gel de polyacrylamide en
milieu dénaturant ou (SDS-PAGE) constitue une de ces techniques (Begum
et al., 2008). Les études ont porté essentiellement sur les
enzymes (iso-fonctionnels) ou (iso-enzymes) pour lesquels une mutation
n'altère pas la fonction enzymatique mais provoque une variation de
migration électrophorétique. On peut ainsi, pour une souche
donnée, obtenir une combinaison de variants pour l'ensemble des enzymes
étudiés, appelée «Type
Électrophorétique». Particulièrement
étudiées pour les Salmonelles permettant de définir
différents zymotypes (Selander et al., 1986).
B. Caractérisation génotypique
desSalmonella et Shigella
B.1. Profil plasmidique
La détermination du nombre et de la taille des
plasmides nécessite d'extraire l'ADN plasmidique, de les séparer
par électrophorèse en agarose et de les révéler
après coloration au bromure d'éthidium (BET), les profils
plasmidiques ont été utilises dans plusieurs enquêtes afin
d'aider à caractériser des souches de même sérotype
et d'origines divers (Borrego et al.,1992 ; Martinetti , 1990), elle a permis
de subdiviser des lysotypes chez Typhimurium et Enteritidis (Threlfall et al.,
1989 ; Threlfall et al., 1990). D'autres types d'analyses plus précises
peuvent être réalisées comme la détermination du
profil de restriction ; les méthodes employées sont alors
très fortement identiques à celles utilisées pour l'ADN
chromosomique et permettent d'obtenir un profil de restriction plasmidique.
Cette analyse peut être intéressante pour la mise en
évidence de gènes portés sur un plasmide et elle accroit
la discrimination entre les souches et permet de mesurer le degré de
parenté entre de plasmides de taille similaire (Yves Millemaan, 1998).
Toutefois la détermination de profil plasmidique n'apparait pas aussi
intéressante que les autres méthodes de typage comme la lysotypie
quand le nombre de plasmides est réduit (Poppe et al., 1993) et dans le
cas ou les plasmides sont tellement fréquents dans une espèce
qu'ils ne permettent plus de les subdiviser (Threlfall, 1994).
B.2. Étude de l'ADN chromosomique
desSalmonella et Shigella
Les méthodes utilisent schématiquement deux
types de technologie, l'amplification génique ou PCR (Polymérase
Chain Réaction) et la restriction enzymatique, ces deux derniers pouvant
parfois être combinés pour certaines caractérisations
particulières.
B.2.1. Les techniques basées sur la PCR
(Polymérase Chain Réaction)
Les techniques PCR ont l'avantage d'être simples
à mette en oeuvre et de permettre d'obtenir un résultat
très rapidement. Après la phase d'extraction de l'ADN, la PCR est
réalisée, suivie de l'électrophorèse des produits
amplifiés et de la révélation de ces produits par
coloration au bromure d'éthidium (BET), permettent de réaliser
une amplification génomique de certaines séquences d'ADN, c'est
ainsi plusieurs techniques ont été proposés telle :
· La Technique RAPD « Random Amplification
of Polymorphic DNA » C'est une méthode de typage
très utilisée et nécessite une seule amorce choisie au
hasard, formée d'environ une dizaine de nucléotides et
s'hybridant à plusieurs endroits du génome. Les profils des
produits amplifiés ainsi obtenus peuvent être
caractéristiques de la souche et permettent une bonne discrimination au
sein d'un sérotype donné (Hilton et al., 1996). Elle a
été largement utilisée dans la caractérisation et
le diagnostic de l'infection par Salmonella (Tikoo et al., 2001). RAPD a
été décrite comme un procédé simple et
rapide capable d'offrir des empreintes détaillées de la
composition génomique de la bactérie (Welsch & McClelland,
1990), cette technique a prouvé son pouvoir discriminant puissant par
rapport aux techniques phénotypiques pour la caractérisation de
Salmonella Enteritidis de différentes origines (Betancor et al., 2004).
Cependant la reproductibilité et la répétabilité de
la méthode sont passables ce qui ne permet pas de l'utiliser pour un
suivi de souches à long terme. En effet des profils RAPD
différents peuvent résulter de faibles variations portant sur la
concentration des amorces, le nombre et les conditions des cycles
d'amplification, la qualité et la concentration de la Taq
polymérase (Ellsworth et al., 1993 ; Meunie et al., 1993).
· La Technique MLST
(MultilocusSequenceTyping) La technique MLST, développée
en 1998 pour N. meningitidis (Maiden et al., 1998) du fait de la
difficulté de comparer des résultats de MLEE (MultiLocus Enzyme
Electrophoresis) (Caugant, 2002) est une méthode basée sur
l'analyse de la séquence de 7 gènes dits « gènes de
ménage » dont l'expression est indispensable et qui est responsable
du métabolisme de la cellule. Les gènes séquencés
ont la particularité d'être indépendants des gènes
de virulence de l'agent pathogène et de sa résistance aux
antibiotiques. Cette technique est utile pour des études
épidémiologiques descriptives de biosurveillance, mais peut ne
pas être assez discriminante pour des analyses en situation
d'épidémie suite à l'évolution
génétique lente de gènes de ménage (M'aide et a1.,
1998). L'intérêt et l'avantage de cette méthode est qu'elle
est parfaitement reproductible quelque soit le laboratoire et elle permet
l'établissement d'importantes bases de données
répertoriant chaque séquençage (Chan et al., 2001), et
à laquelle des laboratoires du monde entier ont non seulement
accès, mais peuvent également participer en partageant les
séquences des souches qu'ils étudient. Pour salmonella, la base
de données MLST (MLST Database at UoW, University of WARWICK)
(mlst.warwick.ac.uk/mlst) est une des bases qui ont permis la standardisation
de cette technique MLST pour cette bactérie avec sept gènes de
ménages choisies (thrA, purE, sucA, hisDaroC, hemD et dnaN), amorces
pour amplification et séquençage, d'un autre côté
cette base de données offre les moyens de lecture
d'interprétation des différentes séquences ,
détermination de profil allelique , sequencetype et ainsi le complexe
clonal.
· La Technique MLVA (MultilocusVntrAnalysis)
(Variable Numbers Of Tandem Repeats) Les répétitions en
tandem sont constituées par la répétition et dans un
même sens les uns derrière les autres, de motifs d'ADN
répétés, par opposition aux répétitions
« dispersées » dont les unités
répétées sont dispersées dans le génome,
elles sont initialement décrite chez les eucaryotes, les
séquences répétées en tandem (TR) forment des
familles de répétitions souvent distinguées en deux
grandes classes : les microsatellites et les minisatellites (Jeffreys, 1985).
Les séquences répétées, intra ou
inter-géniques sont différenciées par leur taille, de 1
à 9pb pour les microsatellites formés par glissement lors de la
Réplication et plus de 9pb pour les minisatellites formés lors de
la réparation de cassures dans le double brin, d`origine
réplicative (Vergnaud &Pourcel, 2009). Certaines séquences
répétées en tandem présentent un polymorphisme de
répétitions intra- espèce. Ces séquences
polymorphes, qu'elles soient de type micro ou minisatellites, sont
appelées VNTRs pour (Variable Number of Tandem Repeats). Selon les
génomes bactériens elles peuvent représenter de 2 à
10% de l'ensemble des répétitions en tandem (Denoeud&
Vergnaud, 2004). Les VNTRs sont des régions génomiques instables
dont la mutation est médiée par plusieurs facteurs. La
réponse à des stress environnementaux, est une des raisons de
promouvoir cette forme de variabilité. Ces répétitions en
tandem polymorphes sont nécessaires à l'adaptation des
bactéries à leur environnement par action sur la fonction d'une
protéine (variation antigénique, variation de phase, variation
fonctionnelle, interaction avec d'autres bactéries, interaction avec la
cellule cible, régulation de l'expression d'un gène) (Hood et
al., 1996 ; Madoff et al., 1996). Les VNTRs en raison de leur polymorphisme de
longueur résultant de la variation du nombre de motifs ont conduit au
développement des empreintes génétiques permettant
l'identification humaine dans un premier temps (Jeffreys, 1985), et des
bactéries dans un deuxième temps, dont les premiers travaux ont
été effectués sur Haemophilus influenzae en 1997 (Van
Belkum, 1997) et Bacillus anthracis (Jackson, 1997). Depuis 2003, la
méthode de génotypage par MLVA de S. enterica a été
introduite (Lindstedt, 2003 ; Liu, 2003). Les avantages connus de cette
technique sont les suivants : capacité de typage,
reproductibilité, stabilité, concordance
épidémiologique, ainsi que pouvoir de discrimination
élevé en fonction des marqueurs et des sérotypes
étudiés, (Vergnaud &Pourcel, 2009 ; Ramisse et al., 2004 ;
Lindstedt et al., 2003), ce pouvoir discriminant a été
prouvé et vérifié dans plusieurs études
comparatives entre cette technique moléculaire (MLVA) et d'autres telles
que l'électrophorèse en champ pulsé (PFGE) et la lysotypie
(Boxrud et al., 2007 ; Ross &Heuzenroeder, 2009). La technique MLVA
exploite comme source de polymorphisme la variation du nombre de motifs dans
les répétitions en tandem. L'amplification par PCR d'une
collection de loci répétés en tandem, et la mesure de la
taille des fragments amplifiés, permettent d'assigner à une
souche une série de nombres correspondant au nombre d'unités
répétées dans chaque locus (Vergnaud &Pourcel, 2009).
Des schémas MLVA pour certains sérotypes sont déjà
établis pour d'autres ils sont en cours.
B.2.2. Les techniques basées sur la restriction
enzymatique
Ces méthodes consistent à couper l'ADN extrait
et purifié, avec une enzyme de restriction, permettant ainsi de produire
un certain nombre de fragments d'ADN qui seront ensuite séparés
par électrophorèse en gel d'agarose et
révélés par coloration au BET, deux plus importantes et
les plus largement utilisées sont le ribotypage et
l'électrophorèse en champ pulsé ou PFGE (Pulsed Field Gel
Electrophoresis).
· Ribotypage : IL s'est
développé suite à la REA« Restriction Enzyme Analysis
» qui donnait un nombre de fragments trop important pour que les profils
soient facilement interprétables ; génère une empreinte
hautement reproductible et précise qui peut être utilisée
pour classer les bactéries du genre à travers et au-delà
du niveau de l'espèce. Il consiste à transférer les
fragments d'ADN ayant migré sur une membrane de nylon et à
révéler seulement une partie de ces fragments à l'aide
d'une sonde spécifique, une des sondes les plus couramment
utilisées étant la sonde codant pour les ARN ribosomaux 16S et
23S de Escherichia coli ; elle permet donc de révéler les profils
de restriction des gènes codant pour les ARN ribosomaux ou «
ribotypes ». Le ribotypage a été appliqué à
différents sérotypes de Salmonelles et son pouvoir discriminant
est très variable d'un sérotype à un autre ; dans certains
cas, il n'est pas possible de relier le ribotype obtenu à un
sérotype donné (Selander et al., 1990).
· Électrophorèse en Champ
Pulsé ou (PFGE) (Pulsed Field Gel Electrophoresis) Elle utilise
une endonucléase de restriction à faible fréquence de
coupure permettant ainsi de produire un nombre de fragments directement
exploitable pour l'interprétation des profils. Ces fragments d'ADN
doivent alors migrer dans un champ électrique particulier permettant la
migration de fragments de grosse taille de 30 à 2000kb (Schwartz &
Cantor, 1984) par la technique d'électrophorèse dite CHEF
(ClampedHomogenous Electric Field). La révélation des fragments
se fait de façon classique avec le BET. Les enzymes de macrorestriction
utilisées pour le PFGE des Salmonella sont XbaI, BlnI ou SpeI (Murase et
al., 1995). Cette technique a montré, de façon
générale, un très bon pouvoir discriminant pour
Salmonella, mais il existe des variations en fonction du sérotype
étudié. C'est ainsi qu'il existe un bon polymorphisme par PFGE
chez S. Typhimurium après digestion par XbaI alors que la même
enzyme de restriction donne moins de diversité chez S. Enteritidis.
B.2.3. Techniques de caractérisation
moléculaires combinées (PCR-RFLP)
Utilise des techniques d'amplification géniques et de
restriction enzymatique à la fois, dans le cas des Salmonelles, cette
technique à été utilisée pour la
caractérisation du gène de la flagelline, permettant ainsi une
approche moléculaire d'identification des antigènes flagellaire
(H) dans le but de se substituer à la sérotypie ou de
révéler une phase flagellaire antigéniquement non
décelable. Les gènes de flagelline de certains sérotypes
ont été amplifiés puis clivés par des
endonucléases HhaI ou HphI. Des profils de restriction de gène de
flagelline ont été obtenus pour les deux phases flagellaires,
mais la diversité rencontrée dans ces profils ne correspondait
pas de façon précise aux résultats de l'agglutination
flagellaire (Dauga et al., 1998).
PARTIE 2 MATERIEL ET METODES
CHAPITRE .1APPROCHE
METHODOLOGIQUE
Dans ce deuxième chapitre consacré aux
matériel et méthodes utilisés pour traiter du sujet, ont
été présentées successivement la zone
d'étude, l'espèce à étudiér, les techniques
d'échantillonnage, les traitements expérimentaux et les
techniques d'analyse,.
1.1. Cadre de l'étude
Le Centre Hospitalier Universitaire de la Mère et de
l'Enfant où les analyses bactériologiques ont été
réalisées a une superficie de 15000m², il est limité
au Nord par la rue Charles De Gaulle au Sud par le Centre Hospitalier de
Référence Nationale et le Centre National de Transfusion
Sanguine, à l'Est par la Direction Générale de la Police
Nationale et le Marché Central et à l'Ouest par la rue du Canal
Saint Martin. C'est un etablissement à caractère administratif,
doté de la personnalité morale et jouissant de l'autonomie
financière et de gestion. Il est placé sous la tutelle du
Ministère de la Santé Publique. Cet Hôpital a pour mission
de réduire la mortalité maternelle, néonatale et infantile
notamment par :
§ La prévention ;
§ La prestation des soins ;
§ La formation et le perfectionnement du personnel
technique ;
§ La réalisation des analyses et de diagnostic des
maladies ;

§ Les études et recherches relatives aux
problèmes de santé de la Mère et de l'Enfant
Photo 7 : Centre
Hospitalier Universitaire de la Mère et de l'Enfant
Les analyses moléculaires ont été
réalisées au Laboratoire de Biochimie et Immunuologie Appliquer
(LABIA) à l'Université Joseph Ki-Zerbo au Burkina Faso.
1.2. Typeet période d'étude

C'était une étude transversale descriptive qui a
étéréalisée en deux phases de juin à
Decembre2022( phase de collecte de données et d'analyse) et Janvier 2023
jusqu'à décembre 2023 (2émé phase
d'analyse des données et redaction). Cette étude a
concerné quatre (4) Hôpitaux des Districts Sanitaires (DS) et le
CHU de la Mère et de l'Enfant de N'Djamena.
Photo 8 : Carte de la zone
d'étude
1.3 Variables
d'étude
Variables sociodémographiques et
cliniques
L'examen clinique nous a permis :
ü noter la température corporelle fièvre
supérieure ou égale à 38 ?C ;
ü d'apprécier l'état nutritionnel ,
ü l'existence ou non de signes de déshydratation
;
ü de rechercher des symptômes physiques
associés
ü Age, sexe, profession, résidence, le nombre de
selles émises par jour ;
ü l'aspect des selles ;
ü l'existence de traitement antérieur ;
ü début de la diarrhée, facteurs de risques
associé à la diarrhée.
Variables paracliniques
Biologie :
ü Examen des selles et sang à la recherche du
salmonella et shigella,
ü milieu de culture le gelosehektoene et hemoculture,
ü Test de sensibilité aux antibiotiques ,
ü Méthodes de réalisation d'antibiogramme
(Kirby-Bauer , Préparation de la gélose Muller Hinton,
ü Choix des disques,
ü Lecture et
interprétationetCaractérisation moléculaire.
1.4 Échantillonnage
Un échantillonnage exhaustif et consécutif de
tous les patients de tous âges confondus hospitalisés ou non
hospitalisés souffrant de diarrhées ou suspectés
d'infections diarrhéiques reçus en consultation dans
lesdifferentes structures sanitaires de notre zone d'etute a été
réaalisé.
Les selles de routine et le sang des patients ont
constitué notre échantillonnage. Mille cinquante
(1050)echantillons des sellesprovenant des patients ont été
reçus et mises en culture au LaboREDES et 320 sangs des patients qui ont
une fièvre avec une temperaturesupérieure à 38°
degrés. Les selles de routine ont été
prélevées dans les flacons stériles chez les malades
souffrant de troubles digestifs comme la diarrhée reçus au
laboratoire du CHU ME ou soit prélevées dans les mêmes
conditions chez les personnes souffrantes touché de troubles digestifs
dans les hôpitaux des districts sanitaire de N'djamena dans des tubes
stériles contenant de la gélose Cary-Blair pour des analyses au
laboratoire de Bactériologie du LaboREDES.
1.3 .1 Enquêtes
Un questionnaire a été élaboré et
émis aux patients ou aux accompagnants (Annexe VII). Les principales
informations collectées étaient : la provenance, le sexe,
l'âge et l'origine possible de la contamination (la source d'eau de
boisson, aliments et le mode de vie de chaque personne admise).
Chaque patient inclus dans l'étude a fait l'objet de
prélèvement des selles dans un flacon stérile.
Matériel de laboratoire
ü Eprouvette graduée : pour mesurer la
quantité d'eau pour faire dissoudre le milieu ;
ü balance électrique : pour la pesée ;
ü plaque chauffante : pour la préparation des
milieux de cultures des bactéries ;
ü Autoclave : pour la stérilisation des milieux
et les verreries à 121 degrés,
ü Hotte de biosécurité : appareil dans
lequel les manipulations se font en toute sécurité ;
ü Portoir : permet d'arranger les tubes ;
ü Bec benzène : il produit de la flamme et permet
de rendre le milieu stérile ;
ü verreries : tubes, erlenmeyer, boites de Pétri,
béchers, pipettes, lames et lamelles,
ü Gants : permet de se protéger ;
ü Lames et lamelles : permettent d'étaler
l'échantillon pour observer au microscope ;
ü Etuve à 37°C ; · Microscope
optique : permet d'observer les microorganismes ;
ü Vortex (agitateur) : c'est pour
homogénéiser les solutions
Réactifs
Ø Lugol : colorant permettant de marquer les structures
cellulaires au microscope ;
Ø Fushine ; · L'alcool ; · Eau de
javel : un antiseptique ;
Ø Milieux de cultures préparés :
Ø L'eau distillée : elle permet de diluer et
d'homogénéiser les solutions ;
Ø RVS (Rappaport Vassilliadis Soja) : milieu
sélectif permettant la croissance des Salmonelles
Ø HKT(Hecktoen) : milieu sélectif
(gélose) pour l'isolement et la différenciation des bacilles
gram(-), milieu permettant le développement des colonies des
salmonella et shigella ;
Ø L'ADN bactérien : a été
extrait de cultures pures de souches Salmonella et shigella
Ø La Rep-PCR : a été
réalisée avec l'amorce universelle (GTG)
(5'-GTGGTGGGTGTGTGTG 3')
Ø Elements de la PCR : tampon de réaction
(Buffer) MgCl2 dNTP Taq polymérase L'appareil thermocycleur pour PCR
H2O bi-distillée et stérile ;
Ø Souches ATCC13076 : Souche de
référence salmonella ;
Ø Électrophorèse des produits PCR :
Un volume de dix microlitres de chaque produit PCR a été
placé dans les puits du gel d'aga- rose ;
Ø L'affiliation phylogénétique : des
souches a été réalisée grâce aux empreintes
génétiques obtenues par rep-PCR.
Matériel de terrain
Le matériel utilisé pour le
prélèvement se compose de :
· Glacière : permettant de transporter les
échantillons au laboratoire ;
· Petits sachets stériles en plastique d'une
contenance de 500g ;
· gants ;
· Marqueur ;
· caches nez ; · de l'eau distillée ;
· une spatule.
Matériel biologique :
échantillons des selles et sangs permettent d'identifier les
microorganismes
1.3.2 Procédure de
collecte des données
Les données cliniques ont été recueillies
sur une fiche de collecte de données réalisée à cet
effet à l'aide d'un questionnaire présenté en face
à face de l'enquêteur. La première partie de la fiche a
été remplie à partir des dossiers et/ou à partir de
l'interrogatoire de l'accompagnant (parents), concerne les principales
variables qui sont : sociodémographiques des participants, les
antécédents médicaux, les caractéristiques
cliniques des patients et l'appréciation de la température
corporelle. La deuxième partie concerne le laboratoire, aspect
macroscopie des selles, microscopie à l'état frais et
après coloration au Gram, les caractéristiques de la culture et
les résultats de l'antibiogramme.
De chaque patient participant à l'étude,
était prélevé un échantillon des selles pour faire
la coproculture et les patients qui ont été soumis au test au
thermomètre et qui présentaient une fièvre
supérieure ou égale à 38 ?C, un
prélèvement sanguin veineuse de 10 ml sera fait chez chaque
patient consentant à l'étude, qui présentait une
fièvre supérieure ou égale à 38 ?C et
mis directement sur le flacon de l'hémoculture. Quant aux patients qui
ont de diarrhée aiguë et qui ne sont pas sur le site ou on devrait
faire l'analyse biologique seront prélevés par un
écouvillon contenant un milieu physiologique à une
température de conservation située entre 5 et 25°C
susceptible de maintenir en vie les bactéries recherchées
grâce à l'appui des agents de santé.
Une fois les prélèvements effectués, les
échantillons ont été acheminés vers le laboratoire
en vue de leur analyse. Les analyses ont été effectuées
dès la réception des dits échantillons.

Photo 9 : Prélèvement des
selles
1.3.3 Critère
d'inclusion
Les selles ont été prélevées chez
des patients tout venant et souffrant de troubles digestifs, reçus en
consultation au CHU ME et dans les quatre hôpitaux des districts de
N'Djamena Tchad. Chaque personne incluse dans l'étude a fait l'objet de
prélèvement des selles dans un flacon stérile ou
écouvillons et présentant une fièvre supérieure
à 38 ?C ayant été hospitalisés ou ayant
été reçus en consultation externes,
précédant leur consultation à l'une des quatre
hôpitaux des districts et le CHU de la mère et de l'enfant de la
ville de N'Djamena étaient éligibles pour participer à
l'étude.
Les patients ont été exclus de notre
étude : tous les selles provenant des personnes sans trouble
digestifs, les patients ne présentant une fièvre
supérieure à 38 ?C lors de la consultation et les
personnes ayant prélevées des selles dans de conditions non
appropriées.
1.4 Analyses microbiologiques
et moléculaires
L'écouvillon, le pot et le flacon de
l'hémoculture étaient acheminés immédiatement au
Laboratoire CHU de la mère et de l'enfant et au laboratoire de recherche
diagnostic et expertise scientifiques (LABO-REDES) ont
étéimmédiatement traités.
Deux méthodes ont été utilisées
pour réaliser les analyses microbiologiques : les méthodes
manuelles de coproculture avec la galerie API 20E et la méthode de
l'hémoculture.
L'isolement, l'identification culturale, la
caractérisation biochimique, les tests sérologiques et la
conservation des souches ont été effectuées au Centre
Hospitalier Universitaire Mère et enfant et le LaboREDES N'Djamena
(Tchad). La caractérisation moléculaire des souches des
Salmonella a été réalisée au Labia Burkina
Faso.
1.4.1
Enregistrement des selles
Les selles ont été reçues des malades
hospitalisés dans des services du CHU ME et de malades externes venant
des différents quartiers de N'Djamena et les quatre hôpitaux des
districts de Ndjamena pour des consultations médicales.. Chaque selle
reçue a été étiquetée conformément au
numéro d'ordre dans le registre de coproculture et ensuite codé.
Les flacons stériles, hermétiques et parfois munis d'une
cuillère ou d'une spatule ont été recommandés pour
le prélèvement et l'ensemencement plus pratique. On
prélève à partir des matières fécales
émises dans un récipient propre, quelques grammes de selles. Un
fragment muco-purulent ou sanguinolent est choisi lorsqu'il existe.
Les selles de routines ont été recueillies dans
des flacons stériles chez les patients reçus au laboratoire du
CHU ME.
L'écouvillonnage se fait à l'aide d'un
dispositif formé d'un écouvillon stérile et d'un tube en
plastique contenant de l'eau physiologique stérile à 0.9%.

Figure 10: Ecouvillonnage humide
1.4.2 Examen macroscopique
Chaque selle reçue a été soumise à
un examen macroscopique pour la description de leurs aspects et consistance
1.4.3. Examen microscopique
1.4.3.1. Recherche de la
mobilité et morphologie
L'état frais se fait également pour
l'observationde la mobilité et de la morphologie des germes .
2.5 Analyses
microbiologiques
Une méthode a été utilisée pour
réaliser les analyses microbiologiques. La méthode manuelle avec
la galerie API® 20E, et les milieux d'isolement.
1.5.1 Méthodes Manuelles de Coproculture
1.5.2. Traitement des échantillons
La mise en culture des différents milieux, passe par
l'ensemencement de ces milieux (enrichissement, isolement).
1.5.3. Préparation des échantillons des
selles
La préparation des échantillons des selles a
été spécifiques pour chaque type de selles (selles de
routine). Les fractions des selles d'environ 1 à 1,5 g ont
été prélevées avec de pipette pasteur (en verre) ou
avec une anse de platine stériles et ensemencées directement sur
les milieux ou pour préparer un inoculum. Une fois que l'inoculum est
préparé, les différents milieux sont ensemencés
puis incubés à 37 ° C à l'étuve pendant 24
heures. Après incubation, nous procédons à
l'identification des caractères culturaux et morphologiques des colonies
bactériennes dans ces milieux.
1.5.4. Enrichissement

Le bouillon rappaport (Müller-Kauffmann) a
été utilisé comme milieu d'enrichissement pour l'isolement
des Salmonelles et Shigelles dans les selles. Une fraction de
selles a été prélevée à l'aide d'une anse
à platine et ensemencée dans le tube contenant le bouillon. Le
tube ensemencé a été incubé à 37 ° C
à l'étuve pendant 4 heures au minimum et 24 heures au maximum. Le
bouillon devient trouble lorsque les bactéries l'utilisent. Ensuite une
anse à platine a été trempée dans le bouillon puis
ensemencée dans le milieu Hektoen et incubé à 37 ° C
pendant 24 heures pour la recherche de Salmonella et
Shigella.

Figure 11 :
pré-enrichissement dans RV avant 24h et après 24h.
1.5. Isolement
Le milieu Hektoen a été utilisé comme
milieu d'isolement. Les milieux ensemencés ont été
incubés à 37 ° C à l'étuve pendant 24 heures.
Ensuite, les colonies vertes ou bleuâtres avec ou sans centre noir ont
été recherchées pour l'identification des
Salmonella et Shigella (Figure 19, 20 ; Anexxe
XIII).

Figure 12: RV isolé sur
gélose Kektoen
3.4. Identification des agents
bactériens
3.4.1. Identification biochimique des agents
bactériens
Pour l'identification biochimique des bactéries, les
galeries API® 20E a été utilisé et la
réalisation des antibiogrammes.
ü Les Salmonella, la plupart de
Salmonella isolées (Typhi, para Typhi A, B) ont pour
caractères biochimiques communs : ONPG -, Urée -, TDA -,
Citrate de Simmons -, Indole -. Nous avons remarqué que les
Salmonella Typhi et Salmonella para Typhi B sont souvent
H2S + faible après 24 heures de culture et plus
prononcé 48 heures à 72 heures. Par contre, les
Salmonella para Typhi A isolés ont quelques fois H2S
- après 24 heures de culture, mais, le H2S apparaît
faiblement 72 heures voir une semaine après culture. Elles produisent
des gaz en glucose sauf Salmonella Typhi (Figure 14).

Figure 14 : identification sur galerie API 20 E Salmonella
typhi differenciation biochimique
ü Les Shigella, la majorité des
Shigella isolés ont pour caractères biochimiques
négatifs, mais ils sont tous glucose + (Figure 16), catalase + sauf
Shigella dysenteriae 1est catalase -. L'absence de gaz en glucose est
un indice de suspicion. Les Shigella sont tous immobiles à
l'observation microscopique

Figure 15 : identification sur galerie API 20 E Shigella
flexneri différenciation biochimique
Tableau VIII :
caractères biochimiques différentiels des
entérobactéries pathogènes
|
Caractères différentiels des
entérobactéries
|
Glucose
|
Lactose
|
ONPG
|
Uréase
|
TDA
|
Mobilité
|
Mannitol
|
Indole
|
VP
|
H2S
|
|
Salmonella Typhi
Salmonella para Typhi A
Salmonella para Typhi B
Salmonella para Typhi C
Salmonella Typhimurium
Salmonella enteritidis
|
+
+
+
+
+
+
|
-
-
-
-
-
-
|
-
-
-
-
-
-
|
-
-
-
-
-
-
|
-
-
-
-
-
-
|
+
+
+
+
+
+
|
+
+
+
+
+
+
|
-
-
-
-
-
-
|
-
-
-
-
-
-
|
(+)
(-)
+
+
+
(+)
|
|
Shigella dysenteriae 1
Shigella flexneri
Shigella sonnei
Shigellaboydii
|
+
+
+
+
|
-
-
(+) lent
-
|
(+)
(+)
(+)
(+)
|
-
-
-
-
|
-
-
-
-
|
-
-
-
-
|
-
(+)
+
+
|
(+)
(-)
-
-
|
-
-
-
-
|
-
-
-
-
|
NB : (+) et (-) sont des
caractères biochimiques variables
3.4.3. Préparation de la gélose Muller
Hinton
La gélose MH a été préparé
selon les recommandations du fabriquant et stérilisée à la
plaque chauffante pendant 15mn. Après stérilisation, elle a
été autoclavée dans un bain-marie à environ
45°C. L'épaisseur de la gélose était de 4mm, ce qui
correspond à un volume de 22,5 ml pour une boite de pétri avec un
diamètre de90mm. Les boites de pétri ont été
ensuite déposées sur une table à niveau pour la
solidificationpuis s'ensuit le séchage à l'étuve.
3.4.4 Préparation de
l'inoculum
A partir d'une culture de 18 à 24 heures sur la
gélose MH, des colonies pures de la souche à étudier ont
été mises en suspension bactérienne directement en
solution salée (5ml d'eau physiologique) puis
homogénéisées à l'aide d'un vortex. La
densité du mélange a été ajustée à
l'aide d'un densitomètre de sorte à obtenir une turbidité
équivalente de l'étalon 0,5 Mc-Farland, ce qui correspond
à un inoculum d'environ UFC/ml pour Escherichia coli. L'inoculum a été
ajusté en ajoutant une colonie si la suspension bactérienne n'a
pas atteint une turbidité de 0,5 MacFarland ou en ajoutant l'eau
physiologique stérile si la suspension était plus dense.
3.4.5 Ensemencement de
l'inoculum
Un écouvillon stérile a été
trempé dans la suspension bactérienne, puis pressé contre
la paroi interne du tube. L'étalement se fait en frottant
l'écouvillon sur toute la surface de la gélose de haut en bas en
stries serrées et répété2 fois en tournant la boite
de pétri à un angle de 60° de chaque côté de la
boite afin d'obtenir une distribution homogène de l'inoculum (CLSI,
2010). L'application de disque se fait 5 à 10 minutes à une
température ambiante (25°C) après ensemencement. Les boites
de pétri ont été séchées à
l'étuve à 37°C pendant 24heures.
3.4.6 Choix des disques
Quatorze antibiotiques ont été testés.
Ces antibiotiques sont généralement actifs sur les
entérobactéries et sont utilisés couramment en
antibiothérapie probabiliste des infections dues aux
entérobactéries particulièrement les
gastroentérites. Ces antibiotiques étaient les suivantes :
Ampicilline (25ug ;Amikacine (25ug), Amoxicilline+acide clavulanique
(20/10ug), Ceftriaxone (30ug), Triméthoprime Sulfamides (30ug),
,Céfamadole (30 ug), Imipénème (10ug), Aztreonam (10ug),
Norfloxacine (10ug), Colistine (30ug), Acide Nalixidique (30ug), Ciprofloxacine
(5ug), Ofloxacine (5ug) Chloramphénicol (25ug).
3.4.7 Application des disques imprégnés
d'antibiotiques
Les antibiotiques utilisés pour l'antibiogramme
provenaient des disques Bio Mérieux et Bio Rad. Ils ont
été placés individuellement avec des pinces
stériles. Le nombre des disques par boite de pétri devait
être de telle sorte que les zones d'inhibitions ne se coupaient pas afin
de permettre la lecture des diamètres dans plusieurs directions. Le
nombre de disque choisi variait entre 6 à 7 par boite de 90
millimètres.
Photo 16 : Disposition de
disque d'antibiogramme
3.4.8. Lecture et interprétation
Après 24 heures d'incubation, les zones d'inhibition
circulaires autour de chaque disque ont été mesurées
à l'aide d'une règle graduée et comparées aux zones
d'inhibition standard. Les diamètres critiques ont été
proposés par le fabricant conformément au NCCLS. (Performances
standards for Antimicrobiolsucceptibillitytesting).
1.5. Méthodes Manuelles
par l'hémoculture
Le diagnostic des bactériémies repose sur une
mise en culture des bactéries éventuellement présente dans
le sang, appelée hémoculture (diagnostic au laboratoire
des bacteriémie, 2023). En règle générale, une
hémoculture correspond à une paire de flacon aérobie et un
flacon anaérobie (diagnostic au laboratoire
des bacteriémie, 2023).
La prescription des hémocultures se justifient dans les
cas suivants :
· Présence des signes de sepsis (hyperthermie >
38.5°, hypothermie < 36.5°, · frissons...)
· Suspicion d'endocardite infectieuse (fièvre,
souffle au coeur.) ;
· Existence d'une fièvre inexpliquée chez
une femme enceinte, un nouveau-né ou un patient
immunodéprimé ;
· Patients à risque (aplasie par exemple).
Le prélèvement doit répondre
à 3 objectifs :
· Limiter au maximum le risque d'exposition au sang du
préleveur (VHB, VIH) ;
· Limiter au maximum la contamination microbienne du
prélèvement ;
· Prélever une quantité de sang
suffisante.
Les hémocultures inoculées sont
acheminées au laboratoire sans tarder. Lorsque le laboratoire utilise
un automate d'hémoculture, pour éviter que la croissance
bactérienne débute avant le dépôt des flacons dans
l'automate, il est recommandé de ne pas placer les flacons
ensemencés à 37°C.
Pour faire l'incubation on doit homogénéiser le
sang et le bouillon par retournement des flacons puis on va incliner 5
à10 minutes le flacon aérobie afin de recouvrir et ainsi
ensemencer la partie et ainsi ensemencer la partie. L'incuber à
37°C en position verticale le flacon d'hémoculture.
Examen visuel des flacons 1 à 2 fois par jour pendant
10 jours. Chaque jour, on inspecte les flacons pour rechercher les signes
témoignant d'une croissance visible. Sur la gélose
présence des colonies et dans le bouillon apparition d'un trouble ou
d'une hémolyse.
Un flacon négatif montrera un culot globulaire rouge
vif et le bouillon reste limpide et un résultat positif s'observe
lorsque le mélange sang bouillon dépasse le manchon de
l'indicateur de croissance.
Dans le cadre de la démarche qualité, et pour
une bonne traçabilité, les prélèvements
reçus au laboratoire sont inscrits dans les registres de laboratoire et
saisis sur support informatique. Volume sanguin : le nombre de bactéries
par ml de sang étant en général faible, il importe de
prélever une quantité suffisante de sang :
ü Pour l'adulte, 10 ml par ponction veineuse
périphérique. La veine du pli du coude est la plus
indiquée.
Chez l'enfant ou le nouveau-né, le volume de sang
à prélever doit être déterminé par le
médecin traitant. Pour le nouveau-né, il est souvent difficile
d'obtenir plus d'1 à 2 ml de sang. Chez l'enfant 2 a 5 ml de sang
peuvent suffire. Un volume de 5 ml de sang est prélevé sur le
patient et injecte directement dans les flacons d'hémoculture et
incubé à l'étuve pendant une semaine. Lorsqu'on constate
après une semaine des turbidités dans le flacon
d'hémoculture, on va faire le gram, si c'est les bactéries
à Gram négatif qui sont observées, la
référence est faite à l'organigramme ainsi qu'il suit si
le micro- organisme pousse sur la gélose au sang, faire un test
d'oxydase et inoculer une galerie API 20 E. Les Enterobacteriacea (tels que
Salmonella, Shigella) sont oxydase- négatifs. Pour le test
d'oxydase l'aide de pince une goutte de réactif d'oxydase a
été déposée sur le papier buvard, placé sur
une lame porte objet. Ensuite une colonie bien isolée et
représentative a été prélevée à
l'aide de l'anse, puis frottée doucement sur le papier buvard. Le test
est positif lorsqu' une coloration violette apparait dans un délai de 30
secondes. En absence de coloration ou coloration au-delà de 30 secondes
le test est négatif (Paul, 2004). Dans ce test les
caractéristiques des Salmonella, Shigella ont : oxydase (-).
Si les micro-organismes isoles sont identifiés comme
étant Salmonella, Shigella et confirmer par la galerie
API 20E, À l'aide d'une pipette, ont été introduit la
suspension bactérienne dans les microtubes de la galerie. L'incubation
s'est faite à 37°C pendant 24 heures. La lecture de ces
réactions se faits à l'aide du tableau de lectureet
l'identification des souches est obtenue à l'aide du tableau
d'identification du catalogue analytique et faire l'antibiogramme pour les
sensibilités des germes.


Figure 16: Hemoculture Negative
Figure 17: Hemoculture Positive
1.6. Analyses
sérologiques
1.6.1 Test aux anti-sérums
Le test d'agglutination a
été exécuté en suivant les instructions de
Kaufmann et White à l'aide des antisérums :
Il a été utilisé les sérums
d'agglutinations polyvalentes, A, B, C et D, pour la recherche de
Salmonella Typhi, Salmonella para Typhi A, B, C et D et
également les sérums d'agglutinations OMA (O
mélangé), OMB, OMC, OMD pour la recherche de leur appartenance
aux groupes A, B, C et D. Enfin l'antigène Vi (initial du mot allemand
Viehl qui signifie « beaucoup », il masque
l'agglutinabilité O, et qui se rencontre que chez Salmonella
Typhi, Salmonella para Typhi C et exceptionnellement chez
Salmonella Dublin. Dans la pratique, les Salmonella paraTyphi
C n'ont pas été isolées, le test d'agglutination avec le
sérum Vi a été effectué pour attester la
présence de Salmonella Typhi. Les antisérums H ont
été utilisés pour la mise en évidences des
antigènes flagellaires.
Pour les Shigella, les sérums d'agglutinations
(Anti boydii, Anti flexineri, Anti sonnei) pour la recherche de chaque
espèce (Shigella boydii, Shigella flexneri,
Shigella sonnei) et le sérum polyvalent A1 pour la
recherche de Shigella dysenteriae 1.
Chapitre 2. Profil de résistance aux antibiotiques des
Salmonella et Shigella isolés
La méthode des disques ou technique de Kirby Bauer en
milieu gélosé a été également
utilisées pour la réalisation de l'antibiogramme.
2.1 Méthode de diffusion
en milieu gélosé
La méthode de test de sensibilité
utilisée est celle de la diffusion en gélose MH (méthode
des disques ou technique de Kirby Bauer) selon la technique recommandée
par le Comité d'Antibiogramme de la Société
Française de Microbiologie (CASFM, 2022). L'épaisseur de la
gélose était de 4 mm, ce qui correspond à un volume de 25
ml pour une boite de Pétri (Ø 90 mm). L'antibiogramme a
été réalisé à partir d'une souche pure,
isolée sur gélose MH ou en culture pure. Cette méthode est
basée sur le fait, lorsqu'un antibiotique est déposé sur
la surface d'un milieu gélosé en un point donné, il
diffuse en établissant un gradient de concentration inversement
proportionnelle au diamètre de l'antibiotique. L'inoculum a
été suffisamment dilué et comparé avec le standard
des turbidités Mc Farland 0,5, qui est la densité optimale de
sorte qu'après culture sur milieu de Mueller-Hinton il ait la formation
de colonies toutes isolées mais jointives.
Dans les 15 minutes suivantes l'ajustement de la
turbidité de la suspension d'inoculum, il a été
trempé un écouvillon de coton dans la suspension.
L'écouvillon trempé a été pressé fermement
en le tournant contre la paroi inférieure du tube juste au-dessus du
niveau du liquide pour enlever l'inoculum excédentaire. Ensuite, il a
été étalé à trois (3) reprises sur la
surface entière de la gélose, en tournant la boite à
environ 60 °, après chaque application, pour obtenir une
distribution égale de l'inoculum. Enfin partout du bord de la surface de
la gélose a été écouvillonné.
2.2 Les disques
d'antibiotiques
Tous les disques utilisés ont été fourni
par la maison bioMérieux (réf: 55561 ; lot : 102014010). Les
antibiotiques utilisés pour l'antibiogrammes proviennent des disques Bio
Mérieux, disques Pasteur, Rosco et Difco, Bio Rad et DebenDiangosticsLt.
Les antibiotiques sont issus des familles suivantes :
Béta-lactamines (Pénicillines et Céphalosporine),
Phénicolés, Cyclines, Sulfamides, Polypeptides et Quinolones.
Des disques de papier buvard de 6,35 mm de diamètre
imprégnés d'une charge déterminée en antibiotique
ont été utilisés pour les tests d'antibiogramme. 5
à 10 min après l'inoculum, les disques d'antibiotiques ont
été appliqués sur les boites de Pétri. Les disques
ont été placés individuellement avec des pinces
stériles ou à l'aide d'un distributeur contre la gélose.
Le nombre des disques par boites de Pétri doit être tel que les
zones d'inhibition ne se coupent pas afin de permettre la lecture des
diamètres dans plusieurs directions. Le nombre des disques choisi varie
entre 6 à 7 par boite de 90 millimetres. Une fois que les disques ont
été placés sur la gélose, elles sont
laissées à la température du laboratoire (25 ° C)
pendant environ 30 minutes puis ils sont portés à l'incubation
pendant 24 heures à 37 ° C. Après une nuit d'incubation. La
mesure du diamètre de chaque zone d'inhibition (diamètre du
disque compris) en mm a été faite à l'aide d'un instrument
de mesure gradué appelé pied de coulisse ou d'une règle
graduée. La technique de disposition de disques d'antibiotiques est
représentée par le schéma suivant :

Figure 18 : Technique de disposition des disques
d'antibiotiques
2.3 Conservation des souches
isolées
Le milieu de conservation est un milieu pauvre qui maintient
les bactéries dans un état de vie ralentie. Le BCC (Bouillon
Coeur Cervelle) avec 15% de glycérol (glycérine) a
été utilisé comme milieu de conservation. Le
glycérol a été utilisé comme huile minérale
pour prévenir la dessiccation de la gélose du bouillon. Les
colonies ont été raclées à l'aide d'un
écouvillon puis introduite dans les tubes contenant le BCC
glycérol . La conservation se fait dans un congélateur à -
86 ° C à l'aide de cryo-tubes dans une cryo-boite.
2.4 Caractérisation
moléculaire de Salmonella
La caractérisation moléculaire des souches de
Salmonella isolées a été faite au laboratoire de biochimie
et immunologie appliquée Ouagadougou Burkina Faso.
La PCR (Polymerase Chain Reaction ou réaction de
polymérase en chaîne) est une technique d'amplification d'ADN
in vitro qui permet d'obtenir un très grand nombre de copies
d'une séquence d'ADN cible.
Chaque cycle de PCR est constitué de trois
étapes : une dénaturation de l'ADN par chauffage pour
séparer les deux brins qui le composent, une hybridation des amorces aux
extrémités de la séquence recherchée, puis une
élongation grâce à l'action d'une ADN polymérase.
2.4.1 Extraction de l'ADN bactérien
Repiquer sur la gélose Mueller Hinton, les souches
confirmées de Salmonella incuber à 37 °C pendant 18
à 24 H.
Prélever environ quatre à cinq colonies bien
isolées de la culture bactérienne et les remettre en suspension
dans 5 ml de Bouillon Coeur Cervelle, pour une culture à 37 °C
pendant 24H.
L'extraction de l'ADN bactérien a été
réalisée par thermolyse (Moyoet al., 2007). A l'aide
d'une pipette Pasteur stérile, quelques colonies (02 à 03) de 18
à 24 heures ont été prélevées et
placées dans un tube Eppendorf contenant 300 ìL d'eau
stérile pour PCR. L'ensemble a été
homogénéisé soigneusement jusqu'à la dissolution
complète. Tous les tubes contenant la suspension bactérienne ont
été placés dans un bain marie bouillant à 100
°C pendant 10 minutes. Après ce temps, les tubes ont
été placés dans un congélateur pendant 5 minutes
pour faire éclater les cellules par choc thermique. Ensuite, ces tubes
ont été centrifugés à 12000 trs/mn. Le surnageant a
été utilisé pour la PCR.
2.4.2. Préparation du
mélange réactionnel
La rep-PCR (repetitivesequencebasedpolymerasechainreaction) a
été réalisé en utilisant l'amorce universel GTG5
(5'-GTGGTGGTGGTGGTG-3'). Le volume total de mélange réactionnel
était de 25 microlitre composé de 4 micro litre de Master Mix (5
*FIREPolrMaster Mix), 2 microlitres de l'amorce GTG5 de
concentration 10 micro molaire par ml,2 micro litre de Mgcl2 (2,5 Mm), 2
microlitres d'ADN et 15 microlitres d'eau pure (Water free nuclease).
2.4.3. Amplification des
extraits d'ADN
L'amplification a été réalisé en
trois étapes en utilisant le thermocycleur de type Mastercycler nexus
gradient (Eppendorf). Le programme PCR décris par Cissé et al
2019, et Kaboré et al (2021) a été utilisé. Il
s'agit d'une première étape de dénaturation initial a
94° C durant 4 mn, suivi d'une deuxième étape de 30 cycle
constituée chacun d'une dénaturation a 95° C c
durant 30s, une hybridation à 45° C durant 60s, une
élongation à 65° C durant 8mn et enfin une troisième
étape d'élongation finale à 65° C durant 16 mn. Les
produits PCR ont été conservé au frais au 4 °C.
2.4.4. Préparation du
gel d'agarose
Le gel d'agarose a été préparé en
dissolvant 1 g d'agarose dans 100ml du tampon Tris Acétate EDTA (TAE) a
0,5X au four microondes (SHARP R65G10) jusqu'à la dissolution
complète de l'agarose. Après refroidissement de la solution
d'agarose,10 micro litre de Bromure d'Etilium (BET) a 10 mg/ml ont
été ajoutés. Le mélange obtenu a été
coulé dans une cuve horizontal contenant un peigne. Après
solidification le peigne a été retiré, et le gel a
été émerger dans une cuve de migration (ENDURO GEL XL).
2.4.5. Electrophorèse de
produit PCR
La migration des amplicons a été faite sous un
champ électrique de 40 volts et 30 mA durant 2 heure. Pour se faire, 10
microlitres de chaque amplicon ont été introduit dans un puits
sur la gélose. Un marqueur de 100 pb a été utilisé
pour la comparaison de la taille de bande dans chaque profil de souche
étudier. Après la migration, le gel a été
visualisé et photographié par le système d'imagerie UVP
PhotoDoc-It Imaging System.
2.4.6. Traitement du gel
Une observation visuelle a l'oeil nu de profil d'empreinte
génétique obtenue par la rep-PCR a été faite pour
le groupage de souches. Les souches présentant les mêmes profils
d'empreinte génétique ont été affilié
à un même groupe (Cissé et al 2019).
2.4.7. Construction de l'arbre
phylogénétique
les données obtenues par les empreintes
génétiques de chaque souche ont été utilisé.
L'affiliation phylogénétique des souches a été
réalisée grâce aux empreintes génétiques
obtenues par rep-PCR . La construction de l'arbre phylogénétique
a été effectuée en effectuant une analyse de
classification hiérarchique par le programme DendroUPGMA en utilisant
l'index de similarité de Jaccard (Jaccard index, Tanimoto) selon
Kaboré et al. (2021). Les profils de bande pour chaque isolat
ont été convertis en matrice binaire, indiquant la
présence ou l'absence d'une bande caractéristique. L'algorithme
UPGMA a été appliqué à la matrice de similitude
avec une valeur supérieure au coefficient de Jaccard (écart-type)
moyen de 88 %. La souche de SalmonellaenteritidisATCC 13076 a
été utilisé comme souche de référence.
2.4.8 Contrôle des
milieux
Un contrôle de qualité, de la
stérilité et de l'efficacité de chaque milieu a
été effectué. Pour ce faire, les milieux de culture une
fois préparées ont été incubés à
37°C pendant 24h. Le milieu est considéré comme
stérile s'il y a eu une absence de pousse. Quant à
l'efficacité du milieu, la souche de référence ATCC 13076
a été ensemencée sur les milieux et la présence
d'une pousse bactérienne sur chaque milieu témoignait de son
efficacité
2.4.9 Traitement des
données.
Les données recueillies ont été saisies
à l'aide d'un tableur Excel et le logiciel SPSS nous a permis de faire
l'analyse statistique,qui a utilisé le test de chi-carré
(÷²) pour la comparaison des variables qualitatives. La valeur de
p = 0,05 a été considérée comme
significative.
1.4.10
Considération éthiqueet administratives
lesautorisations des recherches duMinistere de la Santé
Publique,de l'Ecole Doctorale, de la Faculté de Médecine et du
Centre Hospitalier Universitaire de la Mère et de l'Enfant, ont
été obtenues pour nous faciliter l'acces dans les differents
structures sanitaires. Les patients ont été informés des
objectifs avant la collecte des données. La confidentialité a
été respectée, les données collectées
étaient restées anonymes et exploitées pour cette
étude.
2.4.10.1. Consentement
éclairé
Pour rendre possible les collectes d'échantillons dans
les différents hôpitaux concernés par notre étude,
il nous a fallu obtenir des autorisations des recherches, auprès de la
formation de l'Ecole Doctorale, de la Faculté de Médecine, du
Centre Hospitalier Universitaire de la Mère et de l'Enfantet de la
Diriction General du Ministere de la Sante Publique et de la Solidarité
National qui coordonne tout le système de santé tchadien. Cette
autorisation de recherche delivré par le Ministère de la
Santé du Tchad était notre carte d'accès dans les dans les
differentsHopitaux des districts sanitaires et au CHU mere et enfant de
N'djamenaet nous permettait de recueillir directement auprès de
laboratoires respectifs de ces hôpiatux, tous les échantillons des
selles et sang disponibles chez les patients malades
hospitalisés .Les parents des enfants ont été
informés des objectifs avant la collecte des données.les
données collectées étaient restées anonymes et
exploitées pour cette étude et les données
collectées étaient restées anonymes et exploitées
pour cette étude.
Pour effectuer notreetudeune fiche d'information et un
formulaire d'assentiment individuel standard écrits en français a
été remis aux participants. Chaque parent a eu
l'opportunité de poser des questions auxquelles des réponses
appropriées ont été apportées. Une fiche
d'information a été remise aux participants avec une copie
conforme signée du formulaire d'assentiment.
2.4.10..2.Confidentialité
Les données concernant les enfants et les patients
adultes inclus sont confidentiels et ne sont communiquées à
personne en dehors de l'équipe de l'étude, sauf si cela est
jugé nécessaire pour protéger la santé d'un enfant.
La confidentialité est garantie par un système
de codage adapté. Les données nominales ne sont pas
diffusées hors du site d'étude. Les dossiers des patients et
toute information personnelle concernant les sujets participant à
l'étude seront strictement réservés au personnel soignant
et aux investigateurs directement impliqués dans l'étude.
2.4.10.3. Archivage
Tous les questionnaires, consentements signés et autres
documents relatifs à l'étude sont archivés en
sécurité dans un local spécifique à l'archivage des
données, dont l'accès est limité.
3emePARTIE :
RESULTATS
Chapitre .1 .Nombre
et origine des échantillons biologiques collectés et
analysés
3.1 Investigations Hospitalières
Pour
faciliter la collecte d'échantillons dans les divers hôpitaux de
district et au Centre Hospitalier Mère et Enfant, concernés par
notre étude, nous avons dû obtenir une autorisation d'accès
de la Secrétariat Général du Ministère de la
Santé Publique et de la Prévention. Cette autorisation
était notre laissez-passer pour accéder aux différents
hôpitaux de district et au CHU, nous permettant ainsi de collecter
directement auprès des laboratoires et services respectifs de ces
établissements tous les échantillons de selles et de sang
disponibles des patients malades hospitalisés.
Entre
janvier 2022 et juin 2023, un total de 1370 patients ont été
enregistrés dans quatre hôpitaux de district ainsi qu'au Centre
Hospitalier Universitaire Mère et Enfant pour des cas de
gastro-entérites aiguës. Parmi ces patients, 320 (soit 23,35%)
présentaient une fièvre supérieure à 38°C lors
de la consultation, tandis que 1050 (soit 76,64%) ont fourni des
échantillons de selles diarrhéiques, collectés au CHU ME
et dans les quatre hôpitaux de district.
3.2Origine géographique
des échantillons
L'étude a examiné des échantillons de
selles et de sang prélevés dans les quatre hôpitaux de
district de N'Djamena à savoir : Hopital de district Est, Hopital
de district Nord, Hopital de district Centre ,Hopital de District Sud ainsi
qu'au CHU ME. Au total, 1350 échantillons ont été
collectés et soumis à analyse. Ces échantillons ont
été traités en fonction de leur type et du site de
prélèvement correspondant.
3.2.1Identification culturale et
morphologique
Les Salmonella, après 18 heures d'incubation
dans le milieu Hektoen, donnent des colonies qui ont un diamètre de 1
à 3 mm à 37 ° C (Figure 13). On a observé
également des colonies naines, des colonies régulières
lactoses négatifs et colonies vertes translucides à centre noir,
dans certains cas, le centre noir n'apparaît pas. L'observation
microscopique à l'état frais présente des bacilles
mobiles.

Figure 12:Salmonella typhi sur Hektoen colonies
vertes au centre noir
Les Shigella, après 24 heures à 37
° C, on observe des colonies très petites 0,5 à 1 mm de
diamètre, bleuté (Figure 14). L'observation microscopique
à l'état frais présente des bacilles tous immobiles
Figure 13 : Shigella sur Hektoene colonies vertes
transparents
3.2.2 Répartition des
échantillons en fonction de la nature de produit pathologique et des
sites
La répartition des échantillons en fonction de
la nature n'est pas équitable, elle varie de prélèvement
d'un hôpital de district à un autre et d'un site à un
autre.
Les malades en provenance de ces différentes
localités ont été référés pour cause
de l'absence de laboratoires d'analyses biomédicales ou soit par manque
d'une structure adéquate pour la réalisation de la coproculture
et l'hémoculture.
Tableau X :
Répartition des patients selon l'âge et la provenance
|
PROVENANCE
|
AGE (ANS)
|
|
0-5
|
6-10
|
11-15
|
16-20
|
21 et plus
|
|
HÔPITAL DE DISTRICT EST
|
170
|
50
|
80
|
50
|
70
|
|
HÔPITAL DE DISTRICT SUD
|
70
|
75
|
40
|
20
|
70
|
|
HÔPITAL DE DISTRICT NORD
|
50
|
35
|
50
|
25
|
65
|
|
HÔPITAL DE DISTRICT CENTRE
|
50
|
25
|
10
|
60
|
45
|
|
CHU-ME
|
80
|
40
|
20
|
25
|
95
|
|
TOTAL (%)
|
420 (30,65)
|
225 (16,42)
|
200(14,59)
|
180(13,13)
|
345(25,18)
|
Le tableau X présente une analyse de corrélation
entre l'âge des patients et leurs lieux de provenance, en relation avec
les cas de maladies diarrhéiques. Les résultats démontrent
une forte dépendance des lieux de provenance vis-à-vis des
tranches d'âge des patients, cette relation étant hautement
significative avec un seuil de 5%. Il a été observé que
les enfants âgés de 0 à 5 ans représentent la
tranche d'âge la plus touchée par les maladies
diarrhéiques, avec une proportion de 30,65% dans la population
étudiée. Ensuite, les patients âgés de 21 ans et
plus représentent 25,18% de cette population affectée.
Une analyse plus approfondie révèle une
différence significative dans l'incidence des maladies
diarrhéiques entre les enfants de 0 à 5 ans et les individus
âgés de plus de 21 ans, par rapport aux autres groupes
d'âge. Cela est confirmé par une statistique de test du chi
carré (÷²) élevée, s'élevant à 16
658 avec un degré de liberté (ddl) de 1 et une valeur p de 0,001.
En somme, ces résultats mettent en lumière le
fait que les infections diarrhéiques ne se limitent pas à des
régions spécifiques, qu'elles soient rurales ou urbaines.
3.3Identification des
sérotypes des agents bactériens isolés
3.3 .1 Caractéristiques sociodémographiques
et cliniques des patients inclus
Les données présentées dans le tableau XI
révèlent la distribution des selles en fonction de l'âge,
des caractéristiques telles que l'aspect et la consistance, ainsi que la
présence de fièvre égale ou supérieure à 38
degrés. D'après les informations contenues dans les fiches
d'enquête en annexe, le nombre de selles émises par jour variait
de 3 à 14, tandis que certains patients présentaient une
fièvre égale ou supérieure à 38 degrés. Il
est remarquable que la plupart des enfants concernés émettaient
entre 3 et 7 selles par jour. Les enfants dont l'age varient entre 0 à 5
ans sont les plus exposés aux diarrhées avec un nombre de 339 cas
des diarrhées ce qui representaient un pourcentage de 24,74%, l'age
comprise entre 6 à 10 represent 15,83%,l'age comprise entre 11 à
15 represente 19,12%,l'age comprise entre 16 à 20 ans represente20,07%
et l'age comprise entre 21 à plus represente 20,21%.
Tableau XI : Aspects et consistance des selles
selon l'âge
|
AGE (ANS)
|
ASPECTS ET CONSISTANCE DES SELLES
|
|
Sang
|
Mucus
|
Liquide
|
Pâteuse
|
Molle
|
Moulée
|
|
0-5
|
10
|
16
|
105
|
71
|
35
|
2
|
|
6-10
|
53
|
28
|
44
|
52
|
25
|
15
|
|
11-15
|
44
|
19
|
62
|
80
|
35
|
22
|
|
16-20
|
70
|
12
|
53
|
73
|
41
|
26
|
|
21 ET +
|
43
|
31
|
100
|
42
|
44
|
17
|
|
TOTAL (%)
|
320(23,3)
|
106(7,73)
|
364(26,56)
|
318(23,2)
|
180(13,1)
|
82(6,00)
|
3.4.3 Répartition mensuelle des cas de
diarrhées et agents bactériens
La figure 13 illustre les fréquences de
réceptions de selles et les agents bactériens isolés
durant la période d'étude. On observe que pendant les mois
d'Août, Septembre, Octobre plus d'échantillons de selles provenant
de personnes se plaignant de diarrhées ont été
réceptionnées indiquant une forte prévalence de ces
infections diarrhéiques

Figure 19 : Répartition
mensuelle des cas de diarrhées et agents bactériens
isolés
Cette prévalence élevée des cas de
diarrhées pendant les mois d'Août, Septembre, Octobre peut
s'expliquer par le fait qu'elle se situe à la saison pluvieuse qui est
une période où on observe d'important drainage des immondices
chargées de différents germes par les eaux de pluie. Aussi
l'infiltration étant importante la montée de la nappe
phréatique pendant la période de la saison des pluies pouvant
provoqués des contaminations de certaines eaux souterraines de pompes et
des puits de consommation courantes dans les périphéries de
N'Djamena.
3.4.4 Types et nombre des
sérotypes identifiés
L'ensemble des méthodes de diagnostics
réalisés sur les 1370 échantillons de selles humaines et
du sang nous a mis permis d'identifier 50 souches qui sont des salmonella et
shigella pour troubles digestifs, on note une prévalence d'infection de
66,1% chez les femmes et de 53,2%. Chez les hommes.
Tableau XII : Répartition des agents
bactériens selon le sexe
|
Genre
|
Germe isolé
|
|
Shigella
|
Salmonella
|
P-value
|
|
Féminin
|
16 (66,1%)
|
9 (33,9%)
|
P= 0,122
|
|
Masculin
|
14(53,2%)
|
11(46,8%)
|
ddl=1
|
Le tableau 6 nous présente la corrélation entre
le sexe et le résultat Total. Il ressort de ce résultat qu'aucune
différence significative entre le sexe et le résultat total avec
la P-value de 0,122. Ce résultat montre tout de même que le sexe
féminin était plus positif à la culture par rapport au
sexe masculin avec respectivement un taux de 66,1% et 53,2%.
3.4.5 Facteurs de risque
associés à l'infection par les sérotypes des agents
bactériens isolés
3.4.5.1 Facteurs de risque
sociodémographiques
Les méthodes de diagnostic bactériologique
utilisées sur les échantillons de selles et de sang ont permis
d'identifier 50 souches de Salmonella et Shigella d'origine
humaine. Ces souches ont été isolées à partir de
deux produits pathologiques courants, à savoir les cas de
gastro-entérites, de diarrhées et de dysenteries. Au cours de
cette étude, il a été constaté que 3,6% des 1370
échantillons de selles et de sang, collectés dans quatre
hôpitaux de district de la capitale ainsi qu'au CHU ME, et
examinés par les méthodes d'hémoculture et de
coproculture, se sont révélés positifs pour les genres
Salmonella et Shigella.
3.4.5.2 Facteurs de risque
épidémiologiques et cliniques

Figure 20 : Distribution des
germes isolé dans les hôpitaux de districts et CHU ME
La figure 18 illustre la corrélation entre le lieu de
résidence des personnes interrogées et les résultats des
cultures correspondant aux souches de Salmonelles et de Shigellose.
Cette analyse révèle que, dans la zone d'étude,
l'hôpital de district Est a été le plus fortement
affecté par la présence de ces germes, affichant un taux de
positivité de 28,0%. Ensuite, le CHU ME ainsi que les hôpitaux de
district Centre, Nord et Sud ont enregistré des taux respectifs de
22,0%, 20%, 16,0% et 14%.
Il est notable que la valeur de la P-value était
supérieure à 5%, suggérant qu'il n'existe pas de
différence significative entre ces différents hôpitaux de
district et le CHU ME en ce qui concerne la présence des souches de
Salmonelles et de Shigellose.
3.4.6 Différentes
espèces de Salmonella et Shigellaet leurs facteurs de risques
d'infection à Ndjamena
Entre juillet 2022 et décembre 2022, une
enquête de notre étude a permis de réaliser 830 cultures de
selles et de sang, incluant 203 échantillons de sang et 600
échantillons de selles de routine. Parmi les 803 échantillons
biologiques analysés, 39 se sont révélés positifs
aux Salmonella spp et Shigella spp, avec 15 cas de
Salmonella et 24 cas de Shigella, ce qui représente
une prévalence globale de 4,85%. Les facteurs de risque
identifiés pour ces infections comprennent la consommation d'eau de
forage, d'aliments non cuits et le manque d'accès à des
installations sanitaires adéquates.
En outre, il a été démontré que la
propreté des services et du matériel joue un rôle crucial
dans la prévention efficace des infections à Salmonella et
Shigella. En examinant les selles, des agents parasitaires et fongiques, y
compris des levures, ont été détectés. Parmi ces
agents, des co-infections bactéries/parasites ont été
relevées. Ces résultats ont été publiés dans
le Journal of Biosciences and Medicine en 2023, dans le volume 11, pages 1
à 12
Lien vers la publication.
La Fréquence des espèces de
salmonella et de shigella selon la nature de matériel
biologique (selles et sang) est représentée sur la figure
ci-dessous :
Sur les 803 échantillons ont été
analysés (tout matériel biologique confondu) dont 600 sont des
échantillons des selles, la coproculture a été
utilisée pour l'isolement des germes, on a eu à isoler 34germes
dont 26Shigella spp et 8Salmonella spp cas soit une
prévalence de 3,23 % (34/1050) et 300 sont des échantillons des
sangs, on a pu à isoler au total 14 germes dont 12Salmonella
spp et 4 cas de Shigella spp, soit une prévalence de 5,33%
(16/300).

Figure 21 :Frequence des bacteries isolés
en fonction de la nature de l'echantillon biologique
Chapitre 2.Profil de
résistance aux antibiotiques des Salmonella et Shigella
isolés
Au cours de notre période d'étude, nous avons
observé une augmentation significative de la résistance
bactérienne, attribuable à une utilisation inappropriée
des antibiotiques. Parmi les 1370 échantillons de selles et de sang
analysés, nous avons isolé 50 souches de bactéries, toutes
appartenant à la famille des Entérobactéries, avec 30
souches de Shigella et 20 souches de Salmonella. Ces souches ont
présenté une résistance élevée de l'ordre de
85% aux antibiotiques de la classe des Bêta-lactamines, notamment
l'ampicilline et l'amoxicilline.
2.1 Analyse de
l'efficacité des antibiotiques face aux agents bactériens
isolés
Le tableau XIII a été utilisé pour
évaluer l'efficacité des antibiotiques sur les 50 souches de
Salmonella et Shigella isolées dans les quatre hôpitaux de
district et au CHU ME. L'étude a porté sur le test de 20
antibiotiques provenant de six familles différentes sur les 50 agents
bactériens isolés, comprenant S. Typhi (Salmonella Typhi, 10
cas), S. para Typhi A (Salmonella Para Typhi A, 5 cas), S. para Typhi B
(Salmonella Para Typhi B, 5 cas), Shigella Spp(10 cas), Shigella
flexneri (6 cas), et S. dysenteriae 1 (Shigella dysenteriae1, 8 cas),
ainsi que Shigella sonnei (6 cas). Les proportions de
résistance (R) et de sensibilité (S) obtenues sont
consignées dans le tableau (Le tableau XIII).
Tableau XIII :Analyse de l'efficacité des
antibiotiques face aux agents bactériens isolés
Bactérie isolé
|
Antibiotique utilisé par pourcentage
(%)
|
|
|
AMP
|
AMC
|
CTX
|
SXT
|
IMI
|
CHL
|
CIP
|
Am
|
NA
|
CI
|
ATM
|
OFX
|
NOR
|
MA
|
|
Shigella Spp
|
S
|
21,42
|
42,14
|
67,85
|
39,28
|
100%
|
34,14
|
75
|
42,85
|
89,28
|
21,42
|
100
|
100%
|
10,0
|
80%
|
|
|
R
|
78,57
|
57,85
|
32,14
|
60,71
|
0%
|
67,85
|
25
|
57,14
|
10,71
|
78,57
|
0
|
0%
|
90,00
|
20%
|
|
Shigella flexneri
|
S
|
54,54
|
34,14
|
34,14
|
55,9
|
70,5
|
54,54
|
93,7
|
18,18
|
21,42
|
72,72
|
93,7
|
70,5
|
33,33
|
93,7%
|
|
R
|
45,45
|
67,85
|
67,85
|
44,1
|
29,5
|
45,45
|
6,3
|
81,81
|
78,57
|
27,27
|
6,3
|
29,5
|
66 ,6
|
6,3%
|
|
Shigella dysenteriae 1
|
S
|
18,18
|
18,18
|
34,14
|
34,14
|
80,3
|
39,28
|
80,3
|
70,5
|
90,9
|
55,9
|
75
|
42,85
|
100%
|
90,3%
|
|
R
|
81,81
|
81,81
|
67,85
|
67,85
|
19,7
|
60,71
|
19,7
|
29,5
|
9,09
|
44,1
|
25
|
57,14
|
0%
|
09,7%
|
|
Shigella sonnei
|
S
|
39,28
|
54,54
|
21,42
|
30
|
54,54
|
54,54
|
70
|
21,42
|
63,63
|
81,5
|
81,5
|
75,80
|
66 ,6
|
70%
|
|
R
|
60,71
|
45,45
|
78,57
|
70
|
45,45
|
45,45
|
30
|
78,57
|
36,36
|
18,5
|
18,5
|
14,2
|
33,33
|
30%
|
|
Salmonella Para Typhi B
|
S
|
19,28
|
34,14
|
40
|
45
|
21,42
|
18,18
|
100%
|
10,18
|
81,5
|
55,25
|
81,5
|
55,9
|
60%
|
100%
|
|
R
|
80,71
|
67,85
|
60
|
55
|
78,57
|
81,81
|
0%
|
89,81
|
18,5
|
44,75
|
18,5
|
44,1
|
40%
|
0%
|
|
Salmonella Para TyphiA
|
S
|
10,18
|
63,63
|
100%
|
54,54
|
29,7
|
18,18
|
90,9
|
72,72
|
100
|
42,85
|
75
|
100%
|
100%
|
93,9%
|
|
|
R
|
89,81
|
36,36
|
0%
|
45,45
|
61,3
|
81,81
|
9,09
|
27,27
|
0
|
57,14
|
25
|
0%
|
0%
|
6,09%
|
|
Salmonella Typhi (10)
|
S
|
9,1
|
39,28
|
100%
|
55,9
|
70,5
|
10,7
|
93,7
|
40
|
94,54
|
18,18
|
70,5
|
55,9
|
60%
|
93,7%
|
|
R
|
81,9
|
60,71
|
0%
|
44,1
|
29,5
|
89,3
|
6,3
|
60
|
05,45
|
81,81
|
29,5
|
44,1
|
40%
|
6,3%
|
Legende :R = Résistance, S = Sensible (NCCLS,
2022), vis-à-vis de chaque antibiotique on a une zone de
résistance (R) sensible (S) suivant : Ampicilline (AM):
R<11, S= 17 ; Amoxicilline
+ acide Clavulanique (AMC) : R< 14, S= 21 ; Oflaxine (OFX) :
R< 15, S= 22 ; Ceftriaxone (CTX) : R< 15, S= 21 ;
Chloramphénicol (C): R< 19, S= 23 ; Amikacine (Am) : R<
17, S= 19 ; Colistine (Cl) : R< 8, 8 = I= 11, S= 12 ;
Triméthoprime Sulfamides (SXT) : R < 10, S = 19 ;Aztreonam (ATM) : R< 15, S= 22 , Acide
Nalidixique (NA) : R< 15, S = 20,Imipenem (IMI) R<11, S= , Céfamadole (MA) : R< 15, 15 = I= 21, S=
22 ; 17,Norfloxacine (NOR) : R< 22, 22 = I= 25, S= 25
et Ciprofloxacine (Cip) : R< 15 ( CASFM,2022).
Le tableau XIII indique l'évaluation de
l'efficacité des antibiotiques sur les agents bactériens
isolés dans notre lieu d'etude. L'étude a concerné le test
avec 14 antibiotiques issus de six familles différentes sur 50 agents
bactériens isolés Salmonella Typhi (10),
Salmonella Para Typhi A (5), Salmonella Para
Typhi B (5), Shigella Spp (10), Shigella flexneri
(6),Shigelladysenteriae (8), Shigella sonnei (6).
Le profil antimicrobien des espèces isolées de
Salmonella et Shigella (N=50) a été évalué pour 14
antibiotiques à l'aide de la méthode de diffusion sur disque,
conformément aux recommandations de l'antibiogramme. Les isolats de
Salmonella et Shigella ont présenté des niveaux variables de
résistance vis-à-vis des antimicrobiens testés.
Environ 37 % des isolats ont montré une
sensibilité inférieure aux seuils de résistance standards
pour l'ampicilline. La résistance la plus élevée a
été observée contre l'ampicilline, avec 87 % des isolats
résistants, suivie de la résistance à la Amikacine. En
revanche, tous les isolats étaient sensibles à la ciprofloxacine
et imipenem.
La résistance globale aux 14 antimicrobiens
testés était plus élevée chez les isolats de
Salmonella (33 %) par rapport à ceux de Shigella (30 %). L'ampicilline a
enregistré le taux de résistance le plus élevé,
atteignant 89 % pour les isolats de Salmonella et 80 % pour ceux de
Shigella.
À l'opposé, la ciprofloxacine et Aztreonam ont
montré la résistance la plus faible, tous les isolats
étant sensibles à cet antibiotique. Les isolats de Shigella ont
montré un faible taux de résistance à la Céfamadole
etAztreonam (20%), tandis que les isolats de Salmonella n'ont
présenté aucune résistance à l'acide
nalidixique.
Enfin, en ce qui concerne les antibiotiques fréquemment
prescrits, tels que le chloramphincole, et Amoxicilline + acide Clavulanique,
la résistance était de 67 % pour les isolats de Shigella et de 60
% pour ceux de Salmonella.
D'une manière générale, les souches
étudiées présentaient une bonne sensibilité aux
Quinolones (Acide nalidixique) et Fluoroquinolones (Ciprofloxacine et
Norfloxacine). Par contre 70, 9% des isolats étaient résistants
à l'ampicilline et au Chloramphénicol,, 25,3% Aztreonam ,
25,8% à laCéfamadole et Amikacine 25,4% . Les salmonella Para
Typhi manifesté une grande résistance de l'ordre moyenne de
70% auxBêta-lactamines et aux autres classes des antibiotiques
testés excepté le Céfamadole
Chapitre 3.Caractérisation moléculaire des agents
bactériens identifiés
3.1 Caractérisation
moléculaire des souches de salmonella isoléespar la Technique
(GTG) -PCR
Toutes les PCR ont été
répétées au moins deux fois afin de nous assurer de la
fiabilité et de la reproductibilité de nos résultats.
La figure 21 : (A et B) nous montre les différents
profils d'empreinte des souches de salmonellapar la Rep-PCR. Toutes
les souches de salmonellaprésentaient un profil (GTG) 5-PCR.
Les chiffres 1 à 20 montrent les empreintes génétiques des
souches étudiées. La caractérisation moléculaire a
confirmé que sur les 20 souches identifiées, 16 étaient
positives à l'amorce universel GTG5 (5'-GTGGTGGTGGTGGTG-3')
utilisée pour la détection de salmonella.


A
B
Figure 21: Profil d'empreinte
génétique de souche de salmonella par rep-pcr
Légende : PB= paire de base, M= masse
moléculaire, TN= témoin négatif, TP= témoin
positif, 1 à 20 souches de salmonella
analysées.
Chaque groupe des salmonella ont été
réalisées comme marqueurs génétiques, dans le but
de comparer les profils phylogénétiques et les liens de
clonalité de nos souches entre elles.
Dans le génome bactérien, certaines
séquences génétiques sont répétées
à plusieurs endroits. Les amorces rep-PCR sont conçues pour
amplifier les séquences autour des éléments
répétitifs. Les mutations peuvent modifier la séquence du
génome et la rep-PCR peut être utilisée comme outil de
diagnostic.
En effet, alors que les modèles d'empreinte d'ADN
rep-PCR sont considérés comme stables sur de nombreuses
générations de microbes croissance Kang et al,2003. L'impression
par PCR peut être utilisée pour étudier l'évolution
du génome microbien Ishii et al,2009. La rep-PCR a permis
d'étudier vingt souches de salmonella.
L'électrophorèse des produits PCR nous a permis d'obtenir des
informations sur les empreintes génétiques de chaque souche. Les
profils révèlent des bandes caractéristiques des souches
de référence utilisées dans cette
étude SalmonellaATCC 13076 (quatre bandes
caractéristiques à 200 pb, 300 pb, 500 pb et 1000 paire de base.
Les différentes photos montrant les profils moléculaires
représentatifs des différents sérotypes de
Salmonella étudiés.
3.1 Comparaison des profils de
l'arbre phylogénétique
L'arbre phylogénétique obtenu présente la
relation entre les différentes souches étudiées
grâce à leur profil génétique en comparaison avec la
souche de référence SalmonellaATCC 13076.
La relation familiale des souches a
étédéterminée par la ligne droite verticale
à 96 % sur le dendrogramme. À travers le dendrogramme, on peut
voir que la souche de référence SalmonellaATCC 13076est
positionnée au même endroit que la souche S11. L'analyse
de l'arbre phylogénétique montre qu'il existe une
diversité entre les souches étudiées. Vingt souches ont
ainsi été obtenus.

CopheneticCorrelation
Coefficient (CP) = 0,96
Figure 22: Dendrogramme basé sur des empreintes de
(GTG)5-PCR sur les souches cliniques de Salmonella selon l'algorithme
de l'UPGMA
4eme Partie : DISCUSSION
4 . DISCUSSION
GENERALE
4.1 Nombre et origine des
échantillons biologiques collectés et analysés
Caractéristiquesociodémographique
L'étude a été menée pour
actualiser la connaissance sur l'épidemiologie et la
caracterisationmoleculaire sur les souches de Salmonella et
Shigellaresponsable des gastroenterites aigues chez les patients
souffrants des diarrhées aigues dans les quatre hopitaux des districts
dans la ville de N'Djamena au Tchad. Nous avons pu isoler cinquante (50)
souches des enteropathogene : Salmonella et shigella à
l'issue de cette étude, soit une prévalence de 3,64% (50/1370).
Tous les enteropathogenes isolés telsquesSalmonella et
shiegella peuvent, provoquer des maladies systémiques chez
l'homme ayant un statut immunitaire faible, ce taux de prévalence
observé dans cette étude met en exergue un problème de
santé publique alarmant.Des resultats presque similaires ont
été observés par Abba (2023) au Tchad, par Sylla (2020) au
Mali et par Bessimbaye (2013) au tchadrespectivement 2%,1,8 et 2,90%.
Par ailleurs une légère différence entre
nos résultats et celui de Tabo et al. (2015) (9,3%) a été
observé. Cela pourrait s'expliquer par le fait que Tabo et al. (2015)
avaient travaillé dans cinq (5) hôpitaux de la ville de N'Djamena
au Tchad et notre étude a concerné que quatre hopitaux des
districts et le Centre Hospitalier Universitaire de la Mere et de l'Enfant de
N'Djamena.
Cependant, nos résultats sont inférieurs
à ceux observés au Nigeria (53,33%) par Emmanuel et al. (2018),
au Burkina (39%) Somda et al. (2017) et au Congo (20,3%) par Lunguya et al.
(2012). Ces résultats pourraient s'expliquer par l'utilisation des eaux
souterraines (Forage) par la population de N'Djamena (Tchad) et des eaux des
barrages remplies des microorganismes à Ouagadougou (Burkina Faso).
Identification des sérotypes des agents
bactériens isolés
Les échantillons de selles et du sang collectés
dans les quatre hopitaux des districts et le CHU ME présentaient des
aspects des sang (23, 35%) cas. La consistance des selles était
liquide dans cas (26,56%), pâteuse (23,21%), molle cas (23,13%) et
Moulée da (6,36%).Cela pourrait s'expliquer par le fait que la
consistance des selles (liquide) attestent d'une hémolyse et d'une perte
d'eau susceptible d'exposer les malades à l'anémie sevère,
à la perte des electrolytes et à la déshydratation pouvant
les conduire à la mort. Aussi les aspects sanguinolents des selles
seraientt les indicateurs des infections dues à la shigelose à
Shigella dysenteriae1.
Les différents aspects et consistance des selles ont
été respectivement rapportés par Dao etal. (2007)
à Bamako (Mali) : les aspects glaireux dans 14 cas (18,4 %), la
consistance des selles liquides dans 40 cas (52,6 %), et la consistance
polymorphe dans8 cas (10,5 %).
Le taux des selles liquides a été
rapporté en hausse par Reitheret al. (2007) dans 75,3 % au
Ghana. La cause de ces diarrhées liquides sont nombreuses :
inflammation de l'intestin grêle, du colon, par les bactéries, les
parasites, les virus, l'usage chronique de l'alcool pourrait endommager la
muqueuse intestinale exposant la personne aux maladies diarrhéiques,
l'utilisation abusive des antibiotiques qui détruirait la flore normale
de l'intestin et enfin l'ingestion des aliments mal cuits ou souillés
par les microorganismes pathogènes.
La forte prévalence de ces infections
diarrhéiques serait liée aux conditions de vie précaires
des populations dans les pays en développement. Le Fonds des Nations
Unies pour l'enfance (UNICEF) en 2007 à aussi rapporté qu'environ
5000 enfants meurent chaque jour des diverses maladies et 1,5 millions
mourraient des maladies associées aux mauvaises conditions de vie et
manque d'hygiène sanitaire chaque année. Cela pourrait
s'expliquer par la vulnérabilité due à la faiblesse de
l'immunité de ce groupe vis-à-vis des maladies
diarrhéiques.
Sur les 50 agents bactériens isolés, (28,32%)
provenaient des selles d'enfants de 0 à 5 ans. De tel taux a
été également rapporté par Sanouet al.
(1999) au Burkina Faso. Plusieurs auteurs ont expliqué ce taux de
prévalence de diarrhées des enfants de 0 à 5 ans par une
instauration progressive de l'immunité chez les enfants de 0 à 1
an, la malnutrition ou la contamination au niveau de leur alimentation dans le
ménage et le comportement hygiénique des parents. La persistance
de ces maladies diarrhéiques à entéropathogènes et
le manquement aux règles d'hygiène à tous les niveaux de
la vie des populations et spécialement à la mauvaise alimentation
sur le plan qualité a été rapportée par Barro
etal. (2005) au Burkina Faso. En effet plusieurs études
réalisées sur les aliments de rue très consommées
ont révélé que ceux-ci sont souvent contaminés par
des entéropathogènes (Barro et al., 2002 ; Barro et
Traore 2008). L'environnement dans lequel la vie quotidienne se mène se
trouve être le grand réservoir de pathogènes en
cohabitation.
La fréquence de 24% des agents bactériens
obtenus à N'Djamena montre que ceux-ci peuvent être
considérés comme un problème de santé publique pour
la population Tchadienne. Cela montrerait que les agents bactériens
demeurent la principale cause de diarrhées mortelles dans les pays en
développement. On a estimé que la diarrhée a tué
2,2 millions de personnes en 1998, dont la plupart était
âgée de moins de 5 ans (OMS, 2000).
Facteurs de risque associés à
l'infection par les sérotypes des agents bactériens
isolés
D'une manière générale les espèces
du genre Salmonella et Les Shigella ont été les
plus retrouvées dans notre étude. Cela pourrait s'expliquer par
l'utilisation des eaux non potables. La fréquence relativement
élevée des Salmonella a été
également rapporté par Cardinale etal. (2005) dans 43%
des cas. Cette fréquence montre que les diarrhées à
Salmonella sont très fréquentes dans les pays en
développement et seraient liées à la promiscuité
avec certains animaux dans des mauvaises conditions d'hygiène
individuelles collectives et alimentaires (Barro etal, 2002 ;
Dupeyron, 1997). Les Shigella ont été
isolés à un taux de 60 % des cas dans notre étude à
Ouagadougou mais Sanouetal, 1999 ont rapporté un taux
élevé de 42 % au Burkina Faso.
La répartition des agents bactériens dans notre
etude selon le sexe observé, Il ressort de ce résultat qu'aucune
différence significative entre le sexe et le résultat total avec
la P-value de 0,122. Ce résultat montre tout de même que le sexe
féminin était plus positif à la culture par rapport au
sexe masculin avec respectivement un taux de 66,1% et 53,2%. On note cependant
une légère augmentation du taux d'infection chez les femmes par
rapport aux hommes. La prévalence relativement élevée chez
les femmes pourrait s'expliquer par l'inobservation des règles
élémentaires d'hygiène liées à leur taux de
non scolarisation élevé (89 %) selon Podaetal (2003)
à Ouagadougou.
Pendant notre etude,nous avons observé une
prévalence élevée des cas de diarrhées et agents
bactériens des mois d'Août, Septembre et Octobre lors de
l'enquête sur les maladies diarrhéiques. Cela pourrait s'expliquer
par le faite que les déchéts déversés par ces
fleuves sont les sources bien connues des maladies diarrhéiques et
d'autres complications sanitaires de la population riveraine et voire
générale du Tchad. L'infiltration étant importante et la
montée de la nappe phréatique pendant la période de la
saison des pluies pouvant provoquées des contaminations de certaines
eaux souterraines de pompes et des puits de consommation courantes dans les
périphéries de N'Djamena et des villages seraient
également la cause principale des maladies diarrhéiques au Tchad
et même partout en Afrique.
. Les caractéristiques individuelles des
ménages, le niveau de scolarisation de la mère, la nature de
sites urbains et la source d'approvisionnement en eau ont été
également indexés comme facteurs des risques des maladies
diarrhéiques à Yaoundé au Cameroun par Yongsiet
al (2008).
La distribution des souches de Salmonella et
Shigelladans cette étude comprenait S. typhi, s.par typhi A et
B, de meme que shigella dysenteria, shigella flexina. La forte
prévalence de ces microorganismes parmi les isolats révèle
que ces agents pathogènes constituent toujours la cause principale des
gastro-entérites dans le pays. Alioet al. (2017) au Mali ont
montré qu'en Afrique les sérotypes majeurs de Salmonella
retrouvés chez l'homme sont S. typhimurium suivi de S.
enteritidis et S. typhi. Quant à Vandenberg et al. (2010) (22%) ont
montré qu'au Congo sur les Salmonella non typhoïdiques
isolées à partir d'hémocultures d'enfants dans un
hôpital de district rural.
Par ailleurs, depuis 2004, le sérotype S. Enteritidis a
repris la 1ère place des sérotypes responsables des
salmonelloses humaines en France (Weill et al., 2016 ; Weill et al., 2020). Ce
changement de situation pourraitêtre expliqué par le niveau
d'hygiène acceptable des pays développés comme la
France.
Cette faible prévalence
pourrait aussi s'expliquer du fait que dans certains pays en
développement, les campagnes de sensibilisation sur les règles de
bonne pratique d'hygiène au cours des dernières années se
sont considérablement améliorées. Ces améliorations
ont par conséquent réduit le taux de décès global
dû aux maladies diarrhéiques bactériennes (Sarantuya et
al., 2004). Il serait important de continuer d'observer les mesures
barrières et d'hygiènes des mains et environnementales.
Il est donc important et urgent de mener des études sur
la qualité de l'eau de boisson et mener des compagnes de sensibilisation
sur la technique de forage et leur traitement afin d'éviter la
prolifération des souches pathogènes dans les eaux de boisson qui
seraient un problème de santé publique. Pour mieux comprendre les
mécanismes pathogéniques des souches deSalmonella et
Shigella responsables de gastroentérites, en plus des facteurs de
virulence, l'étude de la sensibilité aux antibiotiques a
été également réalisée à travers les
méthodes phénotypiques.
4.2 Profil de
résistance aux antibiotiques des Salmonella et Shigella
isolés
La résistance des bactéries,
particulièrement les entérobactéries aux antibiotiques
constitue un véritable problème de santé publique. Cette
résistance affecte aussi bien les pays développés que les
pays en développement où cohabitent l'automédication et la
vente anarchique des médicaments en dehors des structures légales
(Aminov, 2010). Dans les pays en voie de développement, les
gastro-entérites sont endémiques et constituent un
problème majeur de santé publique, particulièrement chez
les enfants de 0 à 5 ans (Dembélé et al., 2016).
Les antibiotiques de première intention pour leur traitement sont les
phénicolés (chloramphénicol), les â-lactamines
(amoxicillines, ceftriaxones) et les sulfamides
(sulfamétaxazole-triméthoprime) (Aubry et Güzère,
2015). Ces dernières années, en particulier dans les zones
tropicales l'incidence desalmonella et shigella
multi-résistantes aux antibiotiques a vite augmenté. Les
â-lactamines (les aminopénicillines, les céphalosporines,
les monobactam et les carbapénèmes) constituent la famille des
antibiotiques les plus utilisées (Ouédraogo et al.,
2017). La mauvaise utilisation de ces antibiotiques a rapidement conduit
à la croissance de la résistance accrue de ces antibiotiques.
L'étude de la sensibilité des agents
bactériens aux antibiotiques a impliqué l'évaluation de
l'efficacité de différentes familles d'antibiotiques, notamment
les bêta-lactamines (comme l'ampicilline et la ceftriaxone), le
chloramphénicol, les cyclines (tels que la doxycycline), les sulfamides
(comme le cotrimoxazole) et les fluoroquinolones (telles que la
ciprofloxacine). Cette évaluation a été menée de
manière rigoureuse, conformément aux protocoles établis
par Quilici et ses collaborateurs en 2010 ainsi que par le Comité de
l'Antibiogramme de la Société Française de Microbiologie
en 2022.
Cette étude a contribué en fournissant des
données sur l'antibiorésistance des isolats de Salmonella et
Shigella provenant des quatre hôpitaux de district de N'Djamena. La
proportion de souches de Salmonella résistantes s'élevait
à 66,66%. Ces résultats sont en accord avec ceux de
l'étude menée par Dembélé et ses collègues
en 2020 au Burkina Faso, qui ont également constaté un taux de
résistance dépassant 50%.
La majorité des souches isolées dans notre
étude ont démontré une résistance aux
bêta-lactamines (ampicilline, amoxicilline) à un taux d'environ
75%.
Ces résistances pourraient apparaitre naturellement
dans le temps, généralement à la suite de modifications
génétiques. Toutefois la prescription ou l'usage
démesuré de ces antibiotiques ainsi que le non-respect des
délais de traitement pourraient être la cause de
l'accélération de ce processus de résistance. Ces
résistances pourraient également être justifiées par
le phénomène de l'automédication.
Mais une tres bonne sensibilité a été
observé chez le famille de quinolone élevée à (82%)
pour le ciprofloxacine et (80%) pour acide nalidixique. Ces résultats
montrent que les quinolones restent toujours de très bonne alternative
pour le traitement des maladies diarrhéiques dues aux salmonella et
shigella. Selon les directives de l'Organisation Mondiale de la
Santé, la ciprofloxacine est un antibiotique de choix pour tous les
patients présentant une diarrhée aigue (Yang et al., 2013).
Des travaux anterieur au Burkina Faso ont été
faite par Ouedrago et al en 2021ont trouvé les isolats de Salmonella
spp. ont montré des taux de résistance allant de 00 %
(à l'imipénème et à l'acide nalidixique) à
100 % (à l'amoxicilline + acide clavulanique et à la colistine)
pour les isolats cliniques et de 00 % (à l'imipénème)
à 100 % (ciprofloxacine amoxique) pour les isolats environnementaux.
De telles résistances observées seraient dues
à la production d'une pénicillinase associée à une
céphalosnase ou une â-lactamases à spectre élargi
capable de résister à tous les antibiotiques de la famille de
â-lactamine à l'exception de l'imipénème (Zeba et
al., 2007, Duval, 1999, Haukkak, 2007, Carvallo, 2004).
En effet, les salmonella et shiegella sont sensibles
à l'Imipénème, ce qui justifie sa place en premier choix
dans le traitement des infections sévères à
bactéries multirésistantes.
Cette hausse de la résistance aux antibiotiques
pourrait être attribuée à divers facteurs tels que
l'automédication, l'utilisation d'antibiotiques en agriculture et en
élevage, ainsi que des pratiques de prescription inadéquates et
la circulation des medicaments de mauvaise qualités.
La résistance croisée a également
été observée dans cette classe d'antibiotiques, touchant
des souches des genres Shigella, Salmonellaet Escherichia, qui sont
naturellement peu sensibles. Cette résistance, lorsqu'elle se manifeste,
est généralement associée à la production de
bêta-lactamases telles que les pénicillinases, les
céphalosporinases et les carbapénémases par les souches
concernées, comme indiqué dans plusieurs études (Zeba et
al., 2007 ; Duval, 1999 ; Haukka et Siitonen, 2007 ; Cavallo, 2004). De plus,
en France, Courvalin et Philippon (1989) ont démontré que le
transfert des plasmides contenant ces déterminants est un
mécanisme clé dans la propagation de la résistance aux
antibiotiques.
Ces travaux antérieurs apportent un soutien
supplémentaire à notre étude, en particulier en ce qui
concerne les tests de sensibilité aux antibiotiques. Cela renforce la
fiabilité et la pertinence de nos résultats dans le contexte plus
large de la recherche sur la sensibilité des agents bactériens
aux médicaments antimicrobiens.
En effet au Tchad, deux raisons peuvent expliquer le taux de
résistance de E. coli à la ciprofloxacine : la
première raison est que la prescription de l'antibiotique par le
clinicien se fait avant toute analyse au laboratoire. Les antibiotiques sont
prescrits de façon empirique. La seconde raison est la large utilisation
des antibiotiques de la rue due à la pauvreté et à
l'ignorance. La plupart des médicaments sont vendus par des personnes
non qualifiées.
Donc une nouvelle attitude thérapeutique devra
être adoptée dans les années à venir pour
réduire l'inefficacité de cet antibiotique.
4.3 Caractérisation
moléculaire des agents bactériens identifiés
Les profils génotypiques générés
par les différentes méthodes de typage moléculaire des
souches bactériennes constituent un outil épidémiologique
important pour la détermination de potentielles sources d'infections. De
plus, la distribution des souches typiques de Salmonella circulant
parmi les différentes espèces offre une information
précieuse pour la compréhension épidémiologique de
la dissémination des génotypes particuliers (tabo et
al.,2013).
Sur les vingt souches de Salmonella que nous avons
identifiées, seules seize se sont avérées positives
à la PCR.Dans l'ensemble, les empreintes génétiques des
souches examinées différaient de celles décrites par Khare
et al. pour les souches de salmonella, qui présentaient un nombre de
bandes variant de 15 à 24Khare et al.,2020. Cette disparité peut
être attribuée à des variations dans les conditions
environnementales ainsi qu'à l'évolution génétique
des souches Shauf et al .,2017 , Labrador et al.,2020.
Toutes les souches de salmonella présentaient
un profil (GTG) 5-PCR. Les chiffres 1 à 24 montrent les empreintes
génétiques des souches étudiées.Une minorité
de souches présente deux bandes caractéristiques,
représentant 3,77 % de l'échantillon.
L'arbre phylogénétique obtenu présente le
lien de parenté entre les différentes souches
étudiées grâce à leur profil d'empreinte
génétique en comparaison avec la souche de
référence ATCC 13076. La relation familiale des souches est
déterminée par la ligne droite verticale à 96% sur le
dendrogramme. A travers le dendrogramme, on observe que la souche de
référence Salmonella ATCC13076 est située au
même endroit que la souche salmonella S11. L'analyse de l'arbre
phylogénétique montre qu'il y a diversité entre les
souches étudiées. Ainsi quinze (15)
groupesontétéobtenus.G1 (S2), G2 (S1,S5), G3 (S4,S3), G4 (S8), G5
(S10), G6 (S7, S9), G7 ( S21,ATCC 13076), G8 (S11), G9 (S6), G10 (S13, S12),
G11 (S14,S15) G12 (S18) G13 (S20,S17), G14 (S19) G15 (S24,S22,S26,S25,S23).
Cela montre une faible relation phylogénétique
entre les souches étudiées (taux de similitude inférieur
à 96% figure 18)Khare et al.,(2020) et Mohapatra et
al., (2008) avaient utilisé la même méthode pour
regrouper les souches de Salmonella. Selon l'analyse
moléculaire basé sur l'arbre phylogénique de l'empreinte
digitale des souches, nous observons que les souches de groupe G15 (S24,
S22,S26, S25, S23) isolées des sangs des patients pourraient être
également la cause des infections à Salmonella en raison
de leur affiliation à des souches responsables de patholagies
entérites (figure : 22).
Cependant, les souches appartenant au groupe G15 (S22,
S26)isolées du sangsont uniques par rapport aux autres elles pourraient
également être à l'origine d'infections gastroenterite en
raison de leur affiliation à des souches responsables de pathologies
gastroentérite. Les souches de certains groupes ne sont que des
entéropathogènes selon leur affiliation (figure 22). En
effet certains auteurs avaient utilisé la méthode GTG5 pour
séparer les Salmonella responsables de pathologies humaines et
animales (Khare et al., 2020 ; Dombek et al.,
2000 ;Farmer,etal., 2016). D'ou, les souches de certains groupes
G1, G2, G3, G4,G5, G6, G7, G8, G9, G11, G12, G14, et G10 ne sont des
gastroenteropathogènes que selon leur affiliation .
.
CONCLUSION ET PERSPECTIVES
. Les risques sanitaires auxquels sont exposées les
populations sont divers et nombreux, résultant principalement de
facteurs sociaux et environnementaux. L'incidence des maladies
diarrhéiques est étroitement liée aux comportements
individuels, tels que la gestion des déchets domestiques et
l'hygiène des matières fécales, ainsi qu'aux pratiques
collectives, telles que l'élimination des déchets solides et
liquides au niveau communautaireCannaux des eaux, il y a des menages qui
conduisent les fècès dans les conduits
Une des principales sources de contamination
identifiées est l'approvisionnement en eau, notamment à travers
les points d'eau traditionnels tels que les puits et les forages.
L'étude a révélé une prévalence de
Salmonella et Shigella de 3,64%. De plus, elle a permis
d'évaluer la sensibilité aux antibiotiques et d'identifier les
souches isolées à partir d'échantillons pathologiques.
Certaines souches ont montré une résistance
significative aux antibiotiques de la famille des bêta-lactamines,
représentant environ 75% des cas au Tchad. En revanche, une
sensibilité élevée aux antibiotiques de la famille des
quinolones, tels que la ciprofloxacine, la norfloxacine et l'acide nalidixique,
a été observée chez 80% des souches.
Il est clair que l'utilisation anarchique d'antibiotiques
à large spectre, tant dans le domaine de la médecine humaine que
dans celui de l'élevage, est la principale cause de ces
résistances. La technique moléculaire a permis une identification
précise des souches étudiées et leur regroupement en
sous-groupes présentant des caractéristiques communes.
PERSPECTIVES
ü Etendre la recherche des souches de Salmonella et
Shigelladans les autres provinces du Tchad afin de comparer les taux
d'infestations.
ü Rechercher à l'aide de la biologie
moléculaire les supports génétiques codant les
gènes de résistances aux â-lactamines, aux aminosides,
fluoroquinolones, quinolones, sulfamides.
ü Effectuer le séquençage des souches qui
hébergent les supports génétiques de résistance
afin de mieux expliquer les mécanismes génétiques de
résistance aux antibiotiques chez les Salmonella et
Shigella.
Reference Bibliographie
A. Andino, & I. Hanning.
(2015). Salmonella enterica?: Survival, Colonization, and Virulence
Differences among Serovars. https://doi.org/10.1155/2015/520179
Adissa
T,
Déborah
T,
Benoît
L,
Nicolas
J,
Fanny
R,
Christopher
P,
Nicolas
L,
Laurent
A. 2010. Prevalence of Rotavirus, Adenovirus,
Norovirus, and Astrovirus Infections and Coinfections among
Hospitalized Children in Northern France. J. Clin. Microbiol. 48:
1943-1946
Aninov RI. (2010). brief of the antibiotic era: lessons
learned and chllenges for the future. Frontiers in Microbiology1: 134p.
Akpakpo, B., Souley, H., Ouattara, A., Bonou-Zin, F., Bouzoua,
N. D., Ali, A. O., Shepherd,S., & Tidjani, P. A. (s. d.). Le
Diagnostic par Biologie Moléculaire Qualitative peut améliorer la
Prise en Charge des Enfants Malnutris Aigus Sévères souffrant de
Diarrhées?: Cas de L'UNT de Hôpital de l'Amitié
Tchad-Chine, N'djaména, Tchad.
Ali, H. M., Hien, Y. E., Zongo, C., Erbi, D., Hissein, A. H.,
Tapsoba, F., Tahir, A. M., Ahamt, B. A., Traore, Y., & Savadogo, A. (2021).
Surgical Site Infection (SSI) in the National Referral General Hospital of
Ndjamena (Chad)?: Survey about Risk Factors. Journal of Biosciences and
Medicines, 9(5), Article 5.
https://doi.org/10.4236/jbm.2021.95001
Alio SA, Samna SO, Maârouhi IM, Diallo BA, Bakasso Y.
2017. Prévalence et Diversité de Salmonella En Afrique : Analyse
Qualitative et Quantitative. European Scientific Journal, ESJ., 13(30):
1857-7881. DOI:
https://doi.org/10.19044/esj.2017.v13n30
p250
Ateudjieu, J., Bita'a, L. B., Guenou, E., Chebe, A. N.,
Chukuwchindun, B. A., Goura, A. P.& Bisseck, A.-C. Z.-K. (2018). Profil et
antibiosensibilité des bactéries pathogènes
associées aux diarrhées chez les patients consultant à
l'Hôpital Régional Annexe de Kousseri, Extrême-Nord
Cameroun. The Pan African Medical Journal, 29, 170.
https://doi.org/10.11604/pamj.2018.29.170.14296
Avril L., Dabernat H., Denis F., Monteil H., 1988.
Bactériologie clinique, 1ére édition Paris. P 126-128.
Aubry P, Gaüzère BA. (2015). Les salmonelloses.
Med Trop: 1-6
BESSIMBAYE, N., Adelsalam, T., Khadidjia, G., Brahim, B. O.,
Guelmbaye, N., Lassana, S., Nicolas, B., & Alfred, A. T. (2013).
Gastro-entérites en milieux des réfugiés au Tchad.
April 2013, Int. J. Biol. Chem. Sci. 7(2): 468-478, April
2013(Int. J. Biol. Chem. Sci. 7(2): 468-478, April 2013), 468?478.
https://doi.org/DOI : http://dx.doi.org/10.4314/ijbcs.v7i2.5
Bessimbaye Nadlaou, Djimadoum Mbanga, Issakou Bakarnga-Via,
Claude Oualé, Nicolas Barro, Abdelsalam Tidjani, & Choua Ouchemi.
(2021). Biochemical profile and resistance phenotype of bacteria isolated from
the operating site departments of the National Reference University Hospital of
N'Djamena. World Journal of Advanced Research and Reviews,
10(1), 381?396. https://doi.org/10.30574/wjarr.2021.10.1.0189
Begum F, Adachi Y & Khan MSR (2008). Characterization of
Salmonella serovars in comparison with some Enterobacteria by sds-page
analysis., Bangl. J. Vet. Med. 6 (2) : 169-174.
Betancor L, Schelotto F, Martinez A, Pereira M, Algorta G,
Rodriguez MA, Vignoli F & ChabalgoityA (2004). Random Amplified polymorphic
DNA and phenotyping analysis of Salmonella e n t e r i c a serovar Enteritidis
isolates collected f r o m humans and poultry in uruguay from 1995-2002. J.
Clin. Microbiol., 42: 1155-1162.
Borrego JJ, Castro D, Jimencz-Notario M, Luque A,
Martinez-Manzanares E, Rodriguez- Avial C, Picazo (1992). Comparison of
epidemiological markers of Salmonella strains isolated from different sources
in Spain, J.Clin. Microbiol. 30, 3058-3064.
Bimet F, Coutelet O.; Dalou L, Hauwaert Th, Marchel N, Yanard
Me J, Podesta Jm, Milovanovic A, Stenger Ch, Maget M.2000. Le Biotechnologiste
International. ASSITEB. 25: 10-16.
Bonnet, Emmanuelle., Fillol, A., Nikiema, A., Lechat, L.,
Tall, M., Da, S. C., & Ridde, V. (2018). Evaluation of social inequalites
in health of road accident victims in Ouagadougou, Burkina Faso. Sante
Publique, HS, 131-137.
Brisabois A., Lafarge V., Brouillaud A., M.-L. de Buyser,
Collette C, Garin-Bastuji B. &Thorel M.-F., 2016. Les germes
pathogènes dans le lait et les produits laitiers : situation en France
et en Europe. Rev.sci.tech.Off. int. Epiz., 16 (1) ,452-471
Bruyère F, Cariou G, Boiteux JP, Hoznek A, Mignard JP,
Bernard L, Sotto A, et al. (2008). Progrès en Urologie. Elsevier
Masson.18 (1) : 5-6.
Canada, A. mondiales. (2017, février 21). La
diarrhée dans les pays en développement. AMC.
https://www.international.gc.ca/world-monde/issues_development-enjeux_developpement/global_health-sante_mondiale/diarrhea-diarrhee.aspx?lang=fra
Cazanave--2017--Gestion de la pénurie de
pénicilline retard inject.pdf. (s. d.). Consulté 22
mars 2024, à l'adresse
https://www.infectiologie.com/UserFiles/File/reunion/2018-prep-ist/2018-prep-ist-cazanave.pdf
Cattoir V. 2004. Pompes d'efflux et résistance aux
antibiotiques chez les bactéries. Pathol. Biol. 52:
607-616.
Charles, N., & Jean-Louis, V. (2007). Bactériologie
médicale. In Bactériologie médicale (2eme
Edition, p. 272).
Chiu CH, Su LH, Chu C, Chia JH, Wu TL, Lin TY, Lee YS & Ou
JT (2004). Isolation of Salmonella enterica serotype Choleraesuis resistant to
ceftriaxone and ciprofloxacin. Lancet 363: 1285-1286.
Courvalin P.2007.
La Résistance des Bactéries aux antibiotiques : Combinaisons
de mécanismes Biochimiques et Génétiques. Bull. Acad.
Vét. 161: 12 p.
Crump J.A., Luby S.P. and Mintz,2004. The global burden of
typhoid fever. Bull Engl J Med 347: 555-560.
Dauga C, Zabrovskaia A & Grimont PAD (1998). Restriction
fragment length polymorphism analysis of some flagellin genes of Salmonella
enterica. J. Clin. Microbiol., 36 : 2835-2843
Dao, S., Oumar, A. A., Dembele, J.
P., Noutache, J. L., Fongoro, S., Maiga, I., & Bougoudogo, F. (2007). [Clinical and bacteriological profiles of the
urinary infections associated the VIH/AIDS in hospital area of Bamako, Mali].
Le Mali medical, 22(1), 10-13.
Deguenon, D., , Victorien, D.,
Evelyne, L., Nana, N. M., Jerrold, A., Roula, M. A., Lamine, B., & Jacques, D. (2019, juin 7).
Déterminants de la résistance et de la virulence des
espèces fécales de Salmonella spp. Isolées d'animaux de
boucherie au Bénin | Notes de recherche BMC.
https://link.springer.com/article/10.1186/s13104-019-4341-x
Dekker, J., & Frank, K.
(2015). Salmonella, Shigella, and Yersinia. Clinics in laboratorymedicine, 35(2), 225?246.
https://doi.org/10.1016/j.cll.2015.02.002
Delarras, C. (2014). Pratique
en microbiologie de laboratoire?: Recherche de bactéries et de levures-moisissures. Lavoisier-Tec & Doc.
Delmas, M.-C., & Fuhrman, C.
(2010). Asthma in France?: A review of descriptive epidemiological data. Revue des maladies
respiratoires, 27, 151?159.
https://doi.org/10.1016/j.rmr.2009.09.001
Dembélé, R.,
Konaté, A., Traoré, O., Kaboré, W. A. D., Soulama, I.,
Kagambèga, A., Traoré, A. S., Guessennd, N. K., Aidara-Kane, A., Gassama-Sow, A.,
& Barro, N. (2020). Extended spectrum beta-lactamase and fluoroquinolone
resistance genes among Escherichia coli and Salmonella isolates from children
with diarrhea, Burkina Faso. BMC Pediatrics, 20(1), 459.
https://doi.org/10.1186/s12887-020-02342-z
Dembélé R,
Bonkougou IJO, Konaté A, Bsadjo Tchamba G, Ibrahim Bawa H, Bako E et
al. (2015). Serotyping and antibiotic resistance of enteropathogenic
Escherichia coli and E. coli 0157 isoled from diarrheae
children in rural aera of Burkina Faso. Afr J Microbiol
Res.9 :1053-1059.
Diagnostic au laboratoire des bacteriémie,
hemoculture. (2023). Diagnostic au laboratoire des
bactériémies?: L'hémoculture.
https://microbiologiemedicale.fr/diagnostic-laboratoire-bacteriemies-hemoculture/
Djim-adjim TABO., Colette D.,
Sophie A. G., Frédérique M., Anne B., Rachid E., Yves M.,
2013.Prevalence and antimicrobial resistance of non-typhoidal Salmonella
serotypes isolated from laying hens and broiler chicken farms in N'Djamena,
Chad. Veterinary Microbiology, 166: 293-298.
Dumas J., 1958. Tribut des Salmonella, Bactériologie
Médicale. Flammarion 8. 399-433. FAO, 2007. Les bonnes pratiques
d'hygiène dans la préparation et la vente des aliments de rue en
Afrique. Outils pour la formation, ISBN 92-5-205583-5, 188P.
Dupeyron C.1997.
Les diarrhées aiguës bactériennes : causes et
mécanismes. Dévelop.
Santé.128 : 1-9.
El_Hassan_K_2011_Quality_of_College_Life_QCL_Validation_of_a_measure_of_student_wellbeing_in_the_Middle_East_International_Journal_of_Educational_and_Psychological_Measurement_81_12-22
Consulté 22 mars 2024, à l'adresse
https://www.researchgate.net/publication/262932109
Dureja C, Mahajan S, Raychaudhuri
S, 2014. Phylogenetic distribution and prevalence of genes encoding class I
integrons and CTX-M-15 extended-spectrum b-lactamases in Escherichia coli
isolates from healthy humans in Chandigarh, India. PloS ONE 9:1-6
EFSA Journal, 2011. EU summary report on trends and sources of
zoonoses and zoonotic agents and food-borne outbreaks, 2009. 9(3): 2090p.
Fall-Niang NK, Sire JM, Tall A, Samb B, Breurec S, Ndour MM,
Faye N, Garin B, GassamaSow A, 2013. Etiologie des diarrhées aigües
infantiles et antibiorésistance des bactéries
entéropathogènes à Dakar. Dakar Med. 58:1-10.
Fresney, C. D. (2007). [When
research becomes the axis of a care project in anestablishment]. Soins; la revue de reference
infirmiere, 718, 35?37.
Gassama-Sow A, Aïdara-Kane A,
Barraud O, Gatet M, Denis F, Ploy MC, 2010. High prevalence of
trimethoprim-resistance cassettes in class 1 and 2 integrons in Senegalese
Shigella spp. isolates. J. Infect. Dev. Ctries. 4:207-212.
Gledel J., Corbion B., 1991. Le genre Salmonella dans le
contrôle Microbiologique, 2ème édition Paris. 480 p
Grimont P., Bouvet M., 2000.Salmonella, Précis de
Bactériologie clinique. Paris : Editions ESKA. P.l 137-1156.
Guide pratique des
bactéries pathogènes--Edition 2017--SOMIPEV. (s. d.).
Consulté 22 mars 2024, à l'adresse
https://somipev.ma/fr/guidelines/guide-pratique-des-bact%C3%A9ries-pathog%C3%A8nes-edition-2017.html
Hamadou, A., Ban-bo Bebanto, A.,
Edith, M. N., Jean, B. O., Kadidja, G., Abdoulaye, K. T., NADLOU, B. N., Abdelsalam, A. D., & Nicolas, B.
(2023). Prévalence et caractérisation des sérotypes de
Salmonella isolées au CHU la Référence Nationale de
N'Djaména au Tchad. Published: 31-10-2023, Vol. 17 No. 7
(2023)(9134-IJBCS), : 2215-2224.
https://doi.org/DOI:
https://dx.doi.org/10.4314/ijbcs.v17i6.7
Hart T, Shears P. Atlas de Poche
de Microbiologie, Flammarion Medecine-Sciences, 1997: Atlas de Poche de Microbiologie: Bukupedia; 1997.
Humbert F., Sautra L., Federighi
M., Jouve J., 1998. Les Salmonelles, Am. J. Vet. Res. 38, 2019-2022
INSEED, 2014. Deuxième Recensement
Général de la Population et de l'Habitat 2009. Analyse
thématique des résultats définitifs. Projections
démographiques régionales 2009- 2050, tome 2 : Niveau
régional, 90p.
Ishii S, Sadowsky MJ. Applications
of the rep-PCR DNA fngerprinting technique to studymicrobial diversity, ecology and evolution:
minireview. Environ Microbiol. 2009;11(4):733-40. https://doi.org/10.1111/j.
1462-2920.2008.01856.
Jabrane, B., & Abdelkhalek, C.
(2014, octobre). Comparative Numerical Simulation of Natural Convection in a Porous Horizontal Cylindrical
Annulus | Scientific.Net.
https://doi.org/10.4028/www.scientific.net/AMM.670-671.613
Jajere, S. M. (2019). A review of
Salmonella enterica with particular focus on the pathogenicity and virulence factors, host specificity
and antimicrobial resistance including multidrug resistance. Veterinary
World, 12(4), 504?521.
https://doi.org/10.14202/vetworld.2019.504-521
Kaboré, B., Ganamé,
A. O., Hama, C., Henri, S. O., Emmanuel, S., Koudbi, J. Z., Boukaré, Z.,
Yves, T., Olivier, G., Idrissa, S., & Aly, S.
(2022). (GTG)5-PCR fngerprinting of multi-drug resistant Escherichia coli
bacteria isolates from hospital in Ouagadougou, Burkina Faso. BMC
Microbiology, (2022) 22:118, (2022) 22:118.
https://doi.org/at
https://doi. org/10.1186/s12866-022-02537-7
Kang HP, Dunne WM. Stability of
repetitive-sequence PCR patterns with respect to culture age and subculture frequency. J Clin Microbiol.
2003;41(6):2694-6. https://doi.org/10.1128/JCM.41.6.2694-2696.2003 .
Khare N, Kaushik M, Martin JP,
Mohanty A and Gulati P. Genotypic diversity in multi-drug-resistant Escherichia
coli isolated from animal feces and Yamuna River water, India, using rep-PCR
fngerprinting. Environ Monit Assess. 2020;192(11).
https://doi.org/10.1007/s10661-020-08635-
Klaus, R., Ralf, I., Thomas, W.,
Andrew, S.-K., Felicia, A.-S., & Frank, P. M. (2007). Acute childhood diarrhoea in northern Ghana?:
Epidemiological, clinical and microbiological characteristics. 6
September 2007, 104 (2007).
https://doi.org/doi:10.1186/1471-2334-7-104.).
Consulté 8 avril 2024, à l'adresse
https://link.springer.com/article/10.1186/1471-2334-7-104
Labrador KL, Nacario MAG,
Malajacan GT, Abello JJM, Galarion LH, Rens - ing C, Rivera WL. Selecting
rep-PCR markers to source track fecal contami - nation in Laguna Lake,
Philippines. J Water Health. 2020:19-29. https:// doi.org/10.2166/wh.2019.042
.
Laine F. 2020. Salmonelles et
toxi-infections alimentaires : épidémiologie et
prévention, Thèse, UGA UFRP - Université Grenoble Alpes -
UFR Pharmacie, 93.dumas-03028429, HAL Id: dumas-03028429.
Laurent, G., & Moez, S.
(2023). Un guide pour la caractérisation des risques microbiologiques | Request PDF. In In book?:
Évaluation des risques microbiologiques (pp.185-210 (p. (pages?:
185-210)). Domaine de l'Encyclopédie SCIENCES?: Agronomie et science des
aliments.
https://www.researchgate.net/publication/370013979_Un_guide_pour_la_caracterisation_des_risques_microbiologiques
Le Hello, S., Hendriksen, R. S.,
Doublet, B., Fisher, I., Nielsen, E. M., Whichard, J. M., Bouchrif, B., Fashae, K., Granier, S. A., Jourdan-Da
Silva, N., Cloeckaert, A., Threlfall, E. J., Angulo, F. J., Aarestrup, F. M.,
Wain, J., & Weill, F.-X. (2011). International Spread of an Epidemic
Population of Salmonella enterica Serotype Kentucky ST198 Resistant to
Ciprofloxacin. The Journal of Infectious Diseases, 204(5),
675?684. https://doi.org/10.1093/infdis/jir409
Lindstedt BA, Heir H, Gjernes E (2003). DNA fingerprinting of
Salmonella enterica subsp enterica serovar Typhimurium with emphasis on phage
type DT104 based on variable number of tandem loci. J Clin Microbiol. 4,
1469-1479.
Li, L., Rathnayake, K., Walter,
S., Fullick, M., Shetty, A., Hudson, P., Lander, H., &Westbrook, J. I. (2024). Blood Culture Ordering After
Sepsis Alerts and Subsequent Patient Outcomes?: An Electronic Health
Record-Based Study. Studies in Health Technology and Informatics,
310, 314?318. https://doi.org/10.3233/SHTI230978
Lozniewskia A, Rabaud. 2010.
Résistance bactérienne aux atibiotiques, Nancy, 4p.
Lunguya O, Lejon V, Phoba MF, Bertrand S, Vanhoof R, Verhaegen
J, Smith AM, Keddy KH, Muyembe-Tamfum J, Jacobs J. 2012. Salmonella typhi in
the Democratic Republic of the Congo: Fluoroquinolone Decreased Susceptibility
on the Rise. PLoSNegl Trop Dis., 6(11): e1921. DOI:
10.1371/journal.pntd.0001921
Madden J M, Mc Cardell B A. 1989. Vibrio
cholerae. EditeurIn: Doyle, M.P. Foodborne Food Bacterial
Pathogens, New York: Marcel Dekker, p 525-542.
Mahmoudi, S., Pourakbari, B.,
Moradzadeh, M., Eshaghi, H., Ramezani, A., Haghi Ashtiani, M. T., Keshavarz Valian, S., & Mamishi, S. (2017).
Prevalence and antimicrobial susceptibility of Salmonella and Shigella spp.
Among children with gastroenteritis in an Iranian referral hospital.
Microbial Pathogenesis, 109, 45?48.
https://doi.org/10.1016/j.micpath.2017.05.023
Mares, M. (2017). Current
Topics in Salmonella and Salmonellosis. BoD - Books on Demand.
Mariani-Kurkdjian, P., Bonacorsi,
S., & Bingen, E. (2016). Diagnostic bactériologique des infections gastro-intestinales.
Bactériologie Médicale, 149?161.
https://doi.org/10.1016/B978-2-294-74616-1.00015-7
MartínezJL,BaqueroF,AnderssonDI.
2007.Predictingantibioticresistance.
Nat.Rev.Microbiol.12 :958-65.
Martinetti G, & Altwcgg M (1990). rRNA gène
restriction patterns and plasmid analysis as tool for typing Salmonella
Enteritidis, Res. Microbiol, 141, 1151-1162.
Mermin J, Villar R, Carpenter J, Roberts L,Samaridden A,
Gasanova L, Lomakina S, Bopp C, Hutwagner L, Mead P, Ross B, Mintz E (1999). A
massive epidemic of multidrugresistant typhoid fever in Tajikistan associated
with consumption of municipal water. J. Infect. Dis., 179, 1416-1422.
Maiden MC, Bygraves JA, Feil E, Morelli G, Russell JE, Urwin
R, Zhang Q, Zhou J, Zurth K, Caugant DA, Feavers IM, Achtman M, & Spratt BG
(1998). Multilocus sequence typing: a portable approach to the identification
of clones within populations of pathogenic microorganisms. Proc Natl Acad Sci
USA. 95, 3140-3145.
Madoff LC, Michel JL, Gong EW, Kling DE & Kasper DL
(1996). Group B streptococci escape host immunity by deletion of tandem repeat
elements of the alpha C protein. Proc Natl Acad Sci USA 93: 4131-6.
McQuade, E. T. R., Shaheen, F.,
Kabir, F., Rizvi, A., Platts-Mills, J. A., Aziz, F., Kalam, A., Qureshi, S., Elwood, S., Liu, J., Lima, A. A. M.,
Kang, G., Bessong, P., Samie, A., Haque, R., Mduma, E. R., Kosek, M. N.,
Shrestha, S., Leite, J. P., ... Iqbal, N. T. (2020). Epidemiology of Shigella
infections and diarrhea in the first two years of life using
culture-independent diagnostics in 8 low-resource settings. PLOS Neglected
Tropical Diseases, 14(8), e0008536.
https://doi.org/10.1371/journal.pntd.0008536
Mérens A, Servonnet A,
2010. Mecanismes et epidemiologie de la resistance aux fluoroquinolones en
2010. Revue francophone des laboratoires 422:33-41
Mérens A, Delacour H, Plésiat P, Cavallo JD,
Jeannot K, 2011. Pseudomonas aeruginosa et résistance aux antibiotiques.
Revue francophone des laboratoires 435:49-62.
Michel, R., Sicard, S., Coton, T., Watier-Grillot, S., Buzens,
A., Marimoutou, C., Mayet, A., & Pommier de
Santi, V. (2018). Actualités sur les diarrhées aiguës
liées aux déploiements hors métropole. Medécine
et armées, 46.
Moubareck, C., M. Lecso, E.
Pinloche, M. J. Butel, and F. Doucet-Populaire.2007. Inhibitory impact of
bifidobacteria on the transfer of B-lactam resistance among
Enterobacteriaceaein the gnotobiotic mouse digestive tract. Appl.Environ.
Microbiol. 73:855-60.
MSPP. (2022). PLAN NATIONALDE DEVELOPPEMENT SANITAIRE
(PNDS 4) 2022--2030 (Vol. 235).
Muylaert A, Mainil JG, 2012. Bacterial antimicrobial
resistances: the mechanisms and their contagiousness. Ann. Méd.
Vét. 156:109-123
Nau, R., Sörgel, F., & Eiffert, H. (2010).
Penetration of Drugs through the Blood-Cerebrospinal Fluid/Blood-Brain Barrier for Treatment
of Central Nervous System Infections. Clinical Microbiology Reviews,
23(4), 858?883. https://doi.org/10.1128/cmr.00007-10
Nicole L., B., , Melinda, A. Z.,
Dorian, Q. F., & Michael, D. P. (2016, juin 6). Ecological consequences of human niche construction?: Examining
long-term anthropogenic shaping of global species distributions | PNAS.
Ecological consequences of human niche construction: Examining long-term
anthropogenic shaping of global species distributions | PNAS.
https://www.pnas.org/doi/abs/10.1073/pnas.1525200113
Olsen, J.E., 2005. Studies of zoonotic Salmonella: Taxonomy,
detection, typing, and pathogenesis, Ed: Samfundsgrafik, Denmark, 146 p.
Organisation mondiale de la santé, 2015.- Maladies
d'origine alimentaire : près d'un tiers des décès
surviennent chez les enfants de moins de 5 ans. Genève, Suisse, URL :
https://www.who.int/fr/news-room/detail/03-12-2015-who-s-first-ever-global-estimates-of
foodborne-diseases-find-children-under-5-account-for-almost-one-third-of-
Ouchar Mahamat, O., Lounnas, M., Hide, M., Dumont, Y.,
Tidjani, A., Kamougam, K., Abderrahmane, M.,
Benavides, J., Solassol, J., Bañuls, A.-L., jean-Pierre, H.,
Carrière, C., & Godreuil, S. (2019). High prevalence and
characterization of extended-spectrum ß-lactamase producing
Enterobacteriaceae in Chadian hospitals. BMC Infectious Diseases,
19(1), 205. https://doi.org/10.1186/s12879-019-3838-1
Ouédraogo, G. A., , Hama, C., Kaboré,
B., Emmanuel, S., Rober, B., Kpoda, D. S., Bassolé, I. H. N., & Aly, S. (2022). Spread and antibiotic
resistance profile of pathogens isolated from human and hospital
wastewater in Ouagadougou. Microbes and Infectious Diseases 2022,
318-331, 3(2): 318-331.
https://doi.org/DOI:
10.21608/MID.2021.72261.1143
Ouédraogo N, Tomba Ngangas SM, Bonkoungou IJO,
Tiendrebeogo AB, Traore KA, Sanou I, et al.(2017). Temporal
distribution of gastroenteritis viruses in Ouagadougou, Burkina Faso :
seasonality of rotavirus. BMC Public Health.
17 : 274
Philippon A. 2004. ANTIBIOTIQUES
III. Résistance bactérienne : Cours de Bactériologi
Médicale, Faculté de Médecine, Université de Paris.
http://www.frm.org/informez/info_ressources_dossiers_article_sommaire.php?id=7&type=10,
16p.
Philippon A, Arlet G, 2012. Entérobactéries et
bêta-lactamines : phénotypes de résistance naturelle.
Pathologie Biologie 60:112-126.
Ploy MC, Denis F, Courvalin P, Lambert T, 2000. Molecular
characterization of integrons in Acinetobacter baumanii: Description of an
hybrid class 2 integron. Antimicrob. Agents Chemother. 44:2684-2688.
Poppe C. McFadde KA, Brouwer AM, & Demczuk W (1993).
Characterization of Samlonella Enteritidis strains, Can. J. Yet. Res. 57,
176-184
Quilici ML, Massenet D, Gake B, Olson DM.
2010. Vibrio cholerae O: 1 variant with reduced
susceptibility to Ciprofloxacin, Western Africa. Emerg. Infect.
Dis.85: 293-308
Rahman, Md. T. (2015).
Salmonellosis?: A major foodborne disease of Global significance. Beverage and Food World.
Ramisse V, Houssou P, Hernadez E (2004). Variable number of
tandem repeats in Salmonella enterica subsp enterica for typing purpose. J Clin
Microbiol 42, 5722-5730. Ramisse V, Houssou P, Hernadez E (2004). Variable
number of tandem repeats in Salmonella enterica subsp enterica for typing
purpose. J Clin Microbiol 42, 5722-5730.
Ross IL, Heuzenroeder M. (2009). A comparison of two PCR-based
typing methods with pulsed-field gel electrophoresis in Salmonella enterica
serovar Enteritidis. Int J Med Microbiol; 299, 410- 20.
Rud D, Pederson-Gulrud K, Wotton J, Medus C, Lyszkowicz E,
Besser J (2007). Comparison of multiple-locus variable-number tandem repeat
analysis, pulsedfield gel electrophoresis, and phage typing for subtype
analysis of Salmonella enterica serotype Enteritidis. J Clin Microbiol 45,
536-43..
René, S. H., Antonio, R.
V., Susanne, K., Danilo, M. A. L. F. W., Henrik, C. W., & Frank, M. A. (2011, juillet 18). Surveillance mondiale de la
distribution des sérovars à Salmonella de la Banque de
données par pays du Réseau mondial des infections d'origine
alimentaire de l'Organisation mondiale de la Santé?: Résultats
des laboratoires de qualité assurée de 2001 à 2007 |
Agents pathogènes et maladies d'origine alimentaire.
https://doi.org/10.1089/fpd.2010.0787
Rogawski McQuade, E. T., Shaheen, F., Kabir, F., Rizvi, A.,
Platts-Mills, J. A., Aziz, F., Kalam, A., Qureshi,
S., Elwood, S., Liu, J., Lima, A. A. M., Kang, G., Bessong, P., Samie, A.,
Haque, R., Mduma, E. R., Kosek, M. N., Shrestha, S., Leite, J. P., ... Iqbal,
N. T. (2020). Epidemiology of Shigella infections and diarrhea in the first two
years of life using culture-independent diagnostics in 8 low-resource settings.
PLOS Neglected Tropical Diseases, 14(8), e0008536.
https://doi.org/10.1371/journal.pntd.0008536
Sanranturya J, Nishi J, Wakimoto N, Erdene S, Nataro JP,
Sheikeh J et al. (2004). Tipical enteroaggregative Escherichia
coli in the most prevalent pathotype among Escherichia coli
strains causing diarrhea in Mongolian children. J clin
Microbiol.42 : 133-139.
Sawadogo, W., Bliefernicht, J., Fersch, B., Salack, S., Guug,
S., Diallo, B., Ogunjobi, Kehinde. O., Nakoulma,
G., Tanu, M., Meilinger, S., & Kunstmann, H. (2023). Hourly global
horizontal irradiance over West Africa?: A case study of one-year satellite-
and reanalysis-derived estimates vs. in situ measurements. Renewable
Energy, 216, 119066.
https://doi.org/10.1016/j.renene.2023.119066
Schwartz S, Cloeckaert A & Roberts MC (2006). Mechanisms
and spread of bacterial resistance to antimicrobial agents. InF. M. A are strup
(ed.), Antimicrobial resistance in bacteria of animal origin. ASM Press,
Washington, D. C. 73-98 p
Selander RK, Beltran P, Smith NH, Backer RM, Crichton PB, Old
D, Musser JM & Whittam TS (1990). Genetic population structure, clonal
phylogeny, and pathogenicity of Salmonella paratyphi B. Infect. Immun 58,
1891-1901.
Shauf MAM, Sieo CC, Kqueen CY,
Chong CW, Omar AR, Ho YW, Hun TG. Discrimination of Escherichia coli isolates
recovered from mucosal contents of chicken intestines and diferent age by
repetitive elements sequence-based PCR. J of Bioch Microbiol Biotechnol.
2017;5(1):7-12. https://doi.org/10.54987/jobimb.v5i1.333 .
Somda NS, Bonkoungou OJI, Traoré O, Bassolé IHN,
Traoré Y, Barro N, Savadogo A. 2017. Serotyping and antimicrobial drug
resistance of Salmonella isolated from lettuce and human diarrhea samples in
Burkina Faso. A. J. Infect. Dis., 11(2): 24-30. DOI: 10.21010/ajid.v11i2.4.
Soraci AL, Perez DS, Tapia MO, Martínez v, Dieguez S,
Buronfosse-Roque F, Harkes R, Colusi A, Romano O, 2011.
Pharmacocinétique et biodisponibilité de fosfomycine chez le
poulet de chair. Revue Méd. Vét. 162:358-363.
Sougakoff W, Trystram D.
Résistances aux â-lactamines. Service de
BacteriologieHygiène du CHU Pitié-Salpêtrière.
2003:9-12.
Tigabu E, Asrat D, Kassa T,
Sinmegn T, Molla B, Gebreyes W, 2015. Assessment of risk factors in milk
contamination with Staphylococcus aureus in urban and peri-urban small-holder
dairy farming in central Ethiopia. Zoonoses Public Health doi:
10.1111/zph.12199.
Threlfall EJ & Frost JA (1990). The identification typing
and fingerprinting of Salmonella: laboratory aspects and epidemiological
applications. J Appl Bacteriol 68: 5-16.
Threlfall EJ, Rowe B & Ward LR (1989). Subdivision of
Salmonella Enteritidis phage types by plasmid profile typing. Epidemiol. Infect
102, 459-465.
Threlfall E (2000). Epidemic Salmonella Typhimurium DT 104-a
truly international multiresistant clone. J. Antimicrob. Chemother 46, 7-10.
Tindall BJ, Grimont PA, Garrity GM, & Euzeby JP (2005).
Nomenclature and taxonomy of the genus Salmonella. Int J Syst Evol Microbiol
55, 521-524.
Ung, A., Baidjoe, A. Y., Van
Cauteren, D., Fawal, N., Fabre, L., Guerrisi, C., Danis, K., Morand, A., Donguy, M.-P., Lucas, E., Rossignol, L.,
Lefèvre, S., Vignaud, M.-L., Cadel-Six, S., Lailler, R., Jourdan-Da
Silva, N., & Le Hello, S. (2019). Disentangling a complex nationwide
Salmonella Dublin outbreak associated with raw-milk cheese consumption, France,
2015 to 2016. Eurosurveillance, 24(3), 1700703.
https://doi.org/10.2807/1560-7917.ES.2019.24.3.1700703
Vaillant, M., Miller, M. I., Younes, L., & Trouvé,
A. (2004). Statistics on diffeomorphisms via
tangent space representations. NeuroImage, 23, S161?S169.
https://doi.org/10.1016/j.neuroimage.2004.07.023
Vergnaud G & Pourcel C (2009). Multiple locus variable
number of tandem repeats analysis. Methods Mol Biol. 551, 141 158.
Vu, D.-L. (2020). Gastroentérites aiguës?:
Démarche diagnostique, qui et quand traiter?? Revue Médicale Suisse, 16(679),
186?188. https://doi.org/10.53738/REVMED.2020.16.679.0186
Waslh CT, Wright G, 2005.
Introduction: Antibiotic Resistance. Chemical Reviews 105:392-393.
Weill F.X, Le hello S, Lefevre S, Renaudat C. 2016. Rapport
d'activités du Centre National de Référence des Escherichia coli, Shigella
et Salmonella Unité de Recherche et d'Expertise des Bactéries
Pathogènes Entériques et Laboratoire associé Service de
Microbiologie, Institut Pasteur de Paris.
Weill FX, Lefèvre S, Pardos
de la Gándara M. 2020. Rapport d'activités du Centre National de
Référence des Escherichia coli,
Shigella et Salmonella Unité de Recherche et d'Expertise des
Bactéries Pathogènes Entériques et Laboratoire
associé Service de Microbiologie, Institut Pasteur de Paris
World Health Organization. (2008).
Directives pour la lutte contre la shigellose, y compris lors d'épidémies dues à Shigella
dysenteriae type 1. Guidelines for the control of shigellosis, including
epidemics due to Shigella dysenteriae type 1, 68.
World Health Organization. (2018). World health statistics
2018?: Monitoring health for the SDGs, sustainable
development goals. World Health Organization.
https://iris.who.int/handle/10665/272596
Yang D, Guo Y, Zhang Z.2009. Combined Porin Loss andExtended
SpectrumLactamase Production is Associated with an Increasing ImipenemMinimal
Inhibitory Concentration in Clinical Klebsiella pneumoniae Strains.
Curr. Microbiol. 58:366-70.
Yao, Kouamé
Réné . (2019). Thèse Phd CARACTERISATION PHENOTYPIQUE
ETMOLECULAIRE DE SALMONELLA SP ET ESCHERICHIA COLI
ISOLEES CHEZ LES BOVINS DANS LE DISTRICT D'ABIDJAN (CÔTE D'IVOIRE)?:
IMPACT BIOLOGIQUE DE L'UTILISATION DES ANTIBIOTIQUES.
Yao JDC, Moellering RCJR, 2007. Antibacterial agents. In Man.
Clin. Microbiol. Murray PR, Baron EJ, Jorgensen JH, Landry ML, Pfaller MA, 9th
Ed: 1:1077-1113
Yves Millemann (1998). Les marqueurs
épidémiologiques des salmonelles. Elsevier Inra, Vet Res 29,
3-19.
Zeba B, Kiendrebeogo M, Lamien A, Docquier J D, Simporé
J, Nacoulma G O. 2007. Major enzymatic Factors involved in Bacterial Penicillin
Resistance in Burkina Faso. J. Biol. Sci. 10:
506-510.
ANNEXE
Liste des articles et communication
A - Articles en relation avec la
thèse
1. Mahamat Tahir N'garé Hassan, Ahmat Idriss Ahmat1,
Yacoub Mahamat Allamine1, AbakarLawane Idriss, Allagueryane Djimadinan1,
AbderrazzackAdoum Foudda3, Ali Mahamat Moussa4 . 2023. Different
Species of Salmonella spp and Shigella spp and Their Risk of Infection in
N'Djamena Chad. Journal of Biosciences and Medicines, 11, 1-12.
https://doi.org/10.4236/jbm.2023.1111001;
Articles hors thèse
1 Mahamat Tahir N'garé Hassan 1*, Ahmat Idriss Ahmat 1
,Yacoub Mahamat Allamine 3 ,MbaigolmenBeral Valery, 1 ,Mahamat Nour
AbakarDjibrine 4 et Ali Mahamat Moussa 1. 2023. STUDY OF SALMONELLA ISOLATES'
RESISTANCE AMONG CHILDREN AGED 0 TO 5 YEARS AT THE UNIVERSITY HOSPITAL CENTER
FOR MATERNAL AND CHILD HEALTH. Am. J. innov. res. appl. sci. 2023; 17(3):
193-199.
B - Communications orales et affichées
(Annexe)
1 Communication orle et Poster. Profil de
sensibilité des souches de Salmonella spp et Shigella
spp associés aux diarrhées vis-à-vis des
antibiotiques dans la ville de Ndjamena Tchad. 2023. Mahamat Tahir
N'garé Hassan, Ahmat Idriss Ahmat,AbderrazzackAdoumFouda,Yacoub Mahamat
Allamine , Mahamat Nour AbakarDjibrine et Ali Mahamat Moussa. 2023.
Journées Scientifiques 1ère
édition de l'ACT.
2 Profil de résistance des souches de Salmonella
spp et Shigella spp associés aux diarrhées
vis-à-vis des antibiotiques dans la ville de Ndjamena Tchad.Colloque
nationale du 13 au 15 Janvier 2022, Deuxième Journées
Scientifiques et Partenariales des Écoles Doctorales de
l'Université de N'Djamena sur le
thème : « Contribution des études doctorales
du développement socio-économique du Tchad

ANNEXE1 : Article publiés

FICHE DE COLLECTE De COPROCULTURE /
HEMOCUTURE
Hôpital notifiant : ______________________________ No
patient ___________________.
Hospitalisé /____/ Externe /____/ Date d'hospitalisation :
____/____/____ (jour/mois/année)
Information sur le patient
Nom de famille : ________________________________ Prénom :
____________________
Adresse/Tel : _________________________ quartier :
_______________________________
secteur_________________________________________________________________
Age (mois) : __________ Date de naissance : ____/____/____
(jour/mois/année) Sexe : M F (encercler)
I Critères liés à la consommation
d'eau
Symptômes et lien avec la contamination de
l'eau
- Sources d'approvisionnement en eau :
I. Quelles sont vos sources d'approvisionnement en eau. Cochez
la bonne réponse
I-1 Eau de pluie I -2 puits I-5
STE
I-6 Forage I-7 fontaine publique (autres
sources à préciser)
2. Constatez-vous des symptômes de
gastro-entérite, (maux de ventre, vomissements, diarrhées,
fièvre à partir de quel mois ?
3. Y a-t-il un lien avec la consommation du réseau
d'eau utilisé ? OUI ? NON ?
II - Critères d'origine
alimentaire
II-1 quels sont les aliments consommés
généralement ?
Lait maternel Lait industrialisé bouillie
Légume cuit

1. Légume crut fruit Viande
poisson
III-Critères d'origine
environnementale
La garde de l'enfant à votre absence :
III-1 Qui s'occupe de l'enfant pendant votre absence :
coche la bonne réponse :
III -2 la bonne ? Oui Non
,
III- 3 Quel est le nombre d'enfant dans la famille
III-4 votre quartier est souvent inondé ? Oui
ou non
III-4 avez-vous des latrines ? Oui ou non
III -5 déféqués vous a L'air
libre ? Oui ou non
IV- Critères d'origine sociale
IV- 1Le chef de famille est un fonctionnaire ?
IV 2 Un étudiant ?
IV 3Un commerçant ? ?
V-4La mère est fonctionnaire ?
V5Une étudiante ? ?
V6 Une commerçante ?
V7 Une ménagère ?
VI- hygiène et assainissement : gestion
des déchets ménagers
· Comment gérez- vous vos déchets
ménagers : brève explication -------------
· C'est la mairie qui passe
récupérer ? Oui Non
· Vous les gardez à côté de la
maison ? OuNon
· Vous les jetez dans les caniveaux Oui
Non
· Vous les jetez sur les voies publiques Oui
Non
· Comment évacuez vos fosses latrines quand elles
sont pleines : brève explication : ----
Information clinique :
Diarrhée sanglante :_____(Oui/Non) Température :
______________ °C
Vomissement : ________ (Oui/Non) Nombre d'épisodes/24 h :
__________ Durée (jours) : _
Diarrhée : ___________ (Oui/Non) Nombre
d'épisodes/24 h : __________ Durée (jours) : __
Déshydraté : __________ (Oui/Non) Autres
symptômes : _____________________________
Paient sous antibiothérapie :_____(Oui/Non) si oui,
quel(s) antibiotique(s) ?______________
Information de laboratoire :
Date de prélèvement des selles : ____/____/____
(jour/mois/année) Aspect______________________
Sa consistance : Liquide
, Molle , Moulée , Pâteuse , Glaireuse
, Dure
Examen direct : Leucocytes ,
Hématies , Levures , Parasites , Néant
Flore bactérienne : Peu
abondante , Abondante , Très abondante , Pauvre
Germe (s) isolé (s):
Shigella , SalmonellaAutres
préciser______________________
Date de prélèvement des sangs : ____/____/____
(jour/mois/année)
Aspect_____________________________________________________________________
Hémoculture :______________________________________________________________
Germe (s) isolé (s) :
Shigella , Salmonella, Autres
préciser______________________
Remarque :
________________________________________________________________
Personne remplissant le formulaire : Date : ____/____/____
(jour/mois/année)
Nom : _______________________ Signature : __________________ Tel
: ___________
Note information et consentement éclairé
pour participer
Thème
Epidemiologie et caracterisation moleculaire des
Souches Salmonella et Shigella,
impliqués dans les gastroenterites aigue chez les patients souffrants
des diarrhée dans la Ville de N'Djamena.
1-BUT DE L'ETUDE : cette étude a pour but de
protéger les personnes sur les infections des gastroentérites
aigues du aux Salmonella et
Shigella.
2-PROCEDURE : Une fiche de renseignement était
établie. On remettra les potssterile pour le prélèvement
des selles aux parents en vue de réaliser l'analyse,le bouillons de
l'hemoculturesera utilisé pour les patients hospitalisés ou non
hospitalisé mais qui presentait une fiévresuperieur à 38
degré et le résultat des examens seront remis au
médecin.
3-PARTICIPATION : La participation est volontaire et les
patients sont libres d'accepter ou de refuser.
4-BENEFICICE EVENTUEL : Le bénéfice de
l'etudeest la connaissance des souches de Salmonella et
Shigella. entéropathogène et aussi
l'ampleur des risques .Cela devra permettre aux cliniciens à une
meilleures prise en charge thérapeutique.
5-CONFIDENTIALITE : Les informations seront remises au
médecin consultant confidentiellement et ne seront divulguées
à qui que ce soit.
6-RISQUES EVENTUELS :
Cette étude ne comporte aucun risque pour la
santé du patient.
7-DEPENSES : La participation de l'étude est libre
et non payante. Les résultats d'analyses seront remis au médecin
8-SIGNATURE
a-Reconnaissance de l'investigateur :
Le parent-----------------------------------------------a
été informé de la nature de l'étude et de
procédure devant être utilisées pour sa réalisation.
Il lui a été demandé de poser les questions sur le
différent aspect de l'étude. Les réponses seront claires,
précises et sans ambiguïté.
b-Déclaration du parent :
Je
soussignée---------------------------------------------déclare
avoir bien été informé de la nature, procédures,
bénéfices et risques éventuel de l'étude
« Epidemiologie et caracterisation moleculaire des Souches
Salmonella et Shigella, impliqués dans
les gastroenterites aigue chez les patients souffrants des diarrhée dans
la Ville de N'Djamena.Accepté de participer.

|